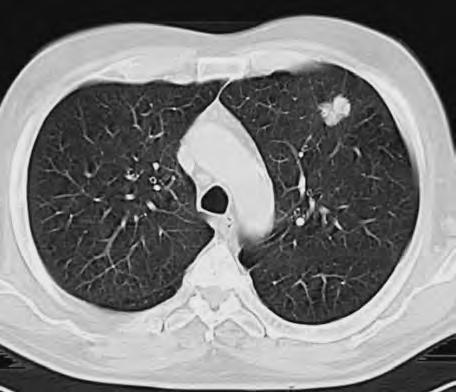

Seznam autorů
prof. MUDr. Zdeněk Adam, CSc. Interní hematoonkologická klinika FN
Jihlavská 20 639 00 Brno
e-mail: z.adam@fnbrno.cz
MUDr. Zdenka Adamová
Ordinace pro děti a dorost
Obilní trh 9
602 00 Brno
doc. MUDr. Rudolf Autrata, CSc.
Dětská nemocnice– FN Brno
Dětská oční klinika Černopolní 9
613 00 Brno
e-mail: rautrata@fnbrno.cz
MUDr. Lenka Babičková
Klinika tuberkulózy a respiračních nemocí FNB
Jihlavská 20 639 00 Brno
e-mail: babickova@fnbrno.cz
doc. MUDr. Pavel Cejpek, CSc. Neurochirurgická klinika FN
Jihlavská 20 639 00 Brno
e-mail: pcejpek@med.muni.cz
Doc. MUDr. Petr Cetkovský, Ph.D. ÚHKT Praha
U Nemocnice 1 120 00 Praha 2 e-mail: petr.cetkovsky@uhkt.cz
MUDr. Oldřich Coufal, Ph.D. MOÚ – Oddělení chirurgické onkologie
Žlutý Kopec 7
656 53 Brno
e-mail: coufal@mou.cz
MUDr. Ivo Čapák MOÚ – Klinika komplexní onkologické péče
Žlutý Kopec 7 656 53 Brno
MUDr. Petr Čechovský MOÚ – Oddělení gynekologické onkologie
Žlutý Kopec 7
656 53 Brno e-mail: cechovsk@mou.cz
MUDr. Aleš Čermák Urologická klinika FNB
Jihlavská 20 639 00 Brno e-mail: acermak@fnbrno.cz
MUDr. Petr Čoupek MOÚ – Oddělení radiační onkologie
Žlutý Kopec 7 656 53 Brno e-mail: coupek@mou.cz
MUDr. Danuše Dembická Dětská nemocnice – FN Brno Klinikadětské onkologie Černopolní 9 662 63 Brno e-mail: d.dembicka@fnbrno.cz
prof. MUDr. Petr Dítě,DrSc. Interní gastroenterologickáklinikaFNB
Jihlavská 20 639 00 Brno
e-mail: pdite@fnbrno.cz
MUDr. Michael Doubek, Ph.D. Interní hematoonkologická klinika FNB
Jihlavská 20 639 00 Brno e-mail: mdoubek@fnbrno.cz
prof. MUDr. Karel Dvořák, DrSc. Patologicko-anatomický ústav FNB
Jihlavská 20
639 00 Brno
e-mail: kdvorak@fnbrno.cz
doc. MUDr. Lubomír Elbl, CSc.
Oddělení funkčního vyšetření FNB
Jihlavská 20 639 00 Brno
e-mail: lelbl@fnbrno.cz
MUDr. P. Fabián, Ph.D. Patologicko-anatomický ústav FNB Jihlavská 20
639 00 Brno
e-mail: pfabian@fnbrno.cz
MUDr. Vuk Fait, CSc.
MOÚ – Oddělení chirurgické onkologie
Žlutý kopec 7
656 53 Brno
e-mail: fait@mou.cz
MUDr. Petr Filipenský Urologická klinika – FN u sv. Anny Pekařská 53 602 00 Brno
MUDr. Lenka Foretová
MOÚ – Oddělení genetiky a epidemiologie nádorů
Žlutý Kopec 7
656 53 Brno
e-mail: foretova@mou.cz
MUDr. Edvard Geryk MOÚ – Úsek regionální správy NOR
Žlutý Kopec 7
656 53 Brno
e-mail: geryk@mou.cz
MUDr. Vlasta Gregorová Klinikadětské onkololgie
Dětská nemocnice – FN Brno Černopolní 9 662 63 Brno
e-mail: vgregorova@fnbrno.cz
doc. MUDr. Roman Hájek, CSc. Interní hematoonkologická klinika FNB
Jihlavská 20 639 00 Brno
e-mail: r.hajek@fnbrno.cz
prof. MUDr. Boris Habanec, DrSc. Bioptická stanice
Dětská nemocnice – FN Brno Černopolní 9
662 63 Brno
MUDr. Ivo Hanke Chirurgická klinika FNB Jihlavská 20 639 00 Brno
e-mail: ihanke@fnbrno
prof. MUDr. Aleš Hep, CSc. Interní gastroenterologická klinika FNB
Jihlavská 20
639 00 Brno
MUDr. Markéta Hermanová Patologicko-anatomický ústav – FNB
Jihlavská 20
639 00 Brno
e-mail: mhermanova@fnbrno.cz
MUDr. Věra Hrbková
Interní gastroenterologická klinika FNB
Jihlavská 20 / Teyschlova 25, 635 00 Brno
639 00 Brno
prof. MUDr. Hana Hrstková, CSc.
Dětská nemocnice – FN Brno
I. dětská interní klinika
Černopolní 9
662 63 Brno
e-mail: hrstkova@fnbrno
MUDr. Josef Chovanec, Ph.D. Gynekologicko-porodnická klinika FNB
Obilní trh 11
602 00 Brno
e-mail: jchovane@fnbrno.cz
doc. MUDr. Pavel Janíček, CSc. I. ortopedická klinika – FN u sv. Anny
Pekařská 53 602 00 Brno
doc. MUDr. Zdeněk Kala. CSc.
Chirurgická klinika FNB
Jihlavská 20 639 00 Brno
e-mail: zdkala@med.muni.cz
MUDr. Renata Kalábová
MOÚ – Oddělení gynekologické onkologie
Žlutý Kopec 7 656 53 Brno
e-mail: kalabova@mou.cz
MUDr. Jana Kaplanová
Klinika tuberkulózy a respiračních nemocí FNB
Jihlavská 20 639 00 Brno
e-mail: jkaplanova@fnbrno.cz
MUDr. Tomáš Kepák
Klinikadětské onkologie
Dětská nemocnice – FN Brno
Černopolní 9 662 63 Brno
e-mail: tkepak@fnbrno.cz
prim. MUDr. Igor Kiss
Oddělení klinické onkologie FNB
Jihlavská 20
639 00 Brno
e-mail: ikiss@fnbrno.cz
MUDr. Ivo Kocák
MOÚ – Klinika komplexní onkologické péče
Žlutý Kopec 7 656 53 Brno
e-mail: kocak@mou.cz
MUDr. Jiří Korbička
I. Chirurgická klinika – FN u sv. Anny
Pekařská 53 602 00 Brno
prof. MUDr. Rom Kostřica, CSc. Klinika otorynolaryngologie a chirurgie hlavy a krku – FN u sv. Anny
Pekařská 53 602 00 Brno e-mail: rom.kostrica@fnusa.cz
MUDr. Zdeněk Král,CSc. Interní hematoonkologická klinika FNB Jihlavská 20
639 00 Brno e-mail: zkral@fnbrno.cz
MUDr. Marta Krejčí, Ph.D. Interní hematoonkologická klinika FNB Jihlavská 20
639 00 Brno e-mail: mkrejci@fnbrno.cz
doc. MUDr. Petr Krupa, CSc. Klinika zobrazovacích metod – FN u sv. Anny Pekařská 53 602 00 Brno e-mail: pkrupa@med.muni.cz
MUDr. Andrea Křivanová, Ph.D. Interní hematoonkologická klinika FNB Jihlavská 20 639 00 Brno e-mail: akrivan@fnbrno.cz
MUDr. Roman Liščák, CSc. Oddělení stereotaktické a radiační neurochirurgie Nemocnice Na Homolce Roentgenova 2 150 30 Praha 5 Motol e-mail: roman.liscak@homolka.cz
MUDr. Olga Magnová Dětská nemocnice – FN Brno Klinikadětské onkologie Černopolní 9 662 63 Brno e-mail: omagnova@fnbrno.cz
MUDr. Jana Marková oddělení klinické onkologie FN Brno e-mail: jmarkova@fnbrno.cz
prof. MUDr. Jiří Mayer, CSc. Interní hematoonkologická klinika FNB
Jihlavská 20
639 00 Brno
e-mail: jmayer@fnbrno.cz
MUDr. Zdeněk Mechl, CSc. Charvatská 13 612 00 Brno
MUDr. Zdeněk Merta, CSc. Klinika tuberkulózy a respiračních nemocí FNB
Jihlavská 20 639 00 Brno e-mail: merta@fnbrno.cz
MUDr. Peter Múdry
Dětská nemocnice – FN Brno
Klinikadětské onkologie
Černopolní 9 662 63 Brno
e-mail: pmudry@fnbrno.cz
MUDr. Tomáš Nebeský, CSc. Radiodiagnostická klinika FNB e-mail: tnebesky@fnbrno.cz
MUDr. Jaroslav Němec, CSc. MOÚ
Žlutý Kopec 7 656 53 Brno
MUDr. Renata Neumanová
Oddělení radiační onkologie – FNB
Obilní trh 11 602 00 Brno e-mail: Rneumano@fnbrno.cz
prof. MUDr. Dalibor Pacík, CSc. Urologická klinika FNB Jihlavská 20 639 00 Brno
e-mail: dpacik@fnbrno.cz
MUDr. Markéta Palácová MOÚ – Klinika komplexní onkologické péče
Žlutý Kopec 7 656 53 Brno e-mail: palacova@mou.cz
MUDr. Ivana Pálková Klinika tuberkulózy a respiračních nemocí FNB
Jihlavská 20
639 00 Brno e-mail: ipalkova@fnbrno.cz
MUDr. Zdeněk Pavelka Dětská nemocnice – FN Brno Klinikadětské onkologie Černopolní 9 662 63 Brno e-mail: zpavelka@fnbrno.cz
Prof. MUDr. Miroslav Penka, CSc. Oddělení klinické hematologie FNB
Jihlavská 20
639 00 Brno e-mail: m.penka@fnbrno.cz
MUDr. Květa Pirochtová Dermatovenerologická klinika FNB
Jihlavská 20
639 00 Brno e-mail: kpirochtova@fnbrno.cz
MUDr. Antonín Pokorný Interní gastroenterologická klinika FNB
Jihlavská 20
639 00 Brno e-mail: apokorny@fnbrno.cz
doc. MUDr. Jiří Prášek, CSc. Oddělení nukleární medicíny FNB
Jihlavská 20 639 00 Brno
e-mail: jprasek@fnbrno.cz
MUDr. Olga Rašovská
Oddělení radiační onkologie – FNB
Obilní trh 11 602 00 Brno
MUDr. Zdeněk Ráčil
Interní hematoonkologická klinika FN Brno e-mail: zracil@fnbrno.cz
prim. MUDr. Arne Rovný
Urologická klinika – FN u sv. Anny
Pekařská 53 602 00 Brno
doc. MUDr. František Rovný, CSc.
Urologická klinika – FN u sv. Anny
Pekařská 53 602 00 Brno
prof. MUDr. Jaroslav Řehůřek, CSc.
Dětská nemocnice – FNBrno
Oční klinika
Černopolní 9 662 63 Brno
e-mail: rehu@fnbrno.cz
doc. MUDr. František Salajka, CSc. Klinika tuberkulózy a respiračních nemocí FNB
Jihlavská 20 639 00 Brno
e-mail: fsalajks@fnbrno.cz
MUDr. Šárka Skorkovská, CSc.
Klinika nemocí očních a optometrie – FN u sv. Anny
Pekařská 53 602 00 Brno
MUDr. Jarmila Skotáková
Dětská nemocnice – FN Brno
Klinika dětské radiologie
Černopolní 9 662 63 Brno
e-mail: jskotakova@fnbrno.cz
prim. MUDr. Miroslava Skovajsová RTG oddělení
Mamma centrum DTC Praha a.s. Roškotova ul. 1717/2 140 44 Praha 4 e-mail: mirkasko@dtc.cz
doc. MUDr. Jana Skřičková, CSc.
Klinikatuberkulózy a respiračních nemocí FNB
Jihlavská 20 639 00 Brno
e-mail: jskric@fnbrno.cz
MUDr. Jaroslav Slaný, CSc. DětskáklinikaFN Ostrava ul. 17. Listopadu 1790 708 00 Ostrava e-mail: jaroslav.slany@fnspo.cz
MUDr. Pavel Smilek, Ph.D. Klinika otorynolaryngologie a chirurgie hlavy a krku – FN u sv. Anny Pekařská 53 656 91 00 Brno
MUDr. Vladimír Spurný, CSc. Oddělení radiační onkologie – FN u sv. Anny Pekařská 53 656 91 00 Brno e-mail: vladimir.spurny@fnusa.cz
MUDr. et MVDr. Dalibor Stratil Patologicko-anatomický ústav FNB
Jihlavská 20 639 00 Brno e-mail: d.stratil@fnbrno.cz
MUDr. Tomáš Svoboda Chirurgická klinika FNB Jihlavská 20 639 00 Brno e-mail: tsvoboda@fnbrno.cz
MUDr. Ivo Šabacký Urologická klinika – FN u sv. Anny Pekařská 53 602 00 Brno
MUDr. Zuzana Šeneklová MOÚ – Oddělení radiační onkologie
Žlutý Kopec 7
656 53 Brno e-mail: seneklova@mou.cz
doc. MUDr. Pavel Šlampa, CSc. MOÚ – Oddělení radiační onkologie
Žlutý Kopec 7
656 53 Brno e-mail: slampa@mou.cz
RNDr. Jana Šmardová, CSc. Ústav patologické anatomie FNB FN Brno e-mail: jsmardova@fnbrno.cz
MUDr. Stanislav Špelda
MOÚ – Klinika komplexní onkologické péče
Žlutý Kopec 7
656 53 Brno
e-mail: spelda@mou.cz
doc. MUDr. Jaroslav Štěrba, Ph.D.
Dětská nemocnice – FN Brno
Klinika dětské onkologie Černopolní 9 662 63 Brno
e-mail: jsterb@fnbrno.cz
MUDr. Pavel Štourač, CSc. Neurologická klinika FNB
Jihlavská 20 639 00 Brno
e-mail: pstourac@fnbrno.cz
MUDr. Jiří Tomášek
Oddělení klinické onkologie FNB
Jihlavská 20
639 00 Brno
e-mail: jtomasek@fnbrno.cz
doc. MUDr. Miroslav Tomíška, CSc. Interní hematoonkologická klinika FNB Jihlavská 20
639 00 Brno
e-mail: mtomiska@fnbrno.cz
MUDr. Dalibor Valík
MOÚ – Oddělení klinické biochemie
Žlutý Kopec 7 656 53 Brno e-mail: valik@mou.cz
MUDr. Jiří Vaníček
Klinika zobrazovacích metod – FN u sv. Anny Pekařská 53 602 00 Brno
doc. MUDr. Vladimír Vašků, CSc. I. dermatovenerologická klinika – FN u sv. Anny Pekařská 53 602 00 Brno
prof. MUDr. Pavel Ventruba, CSc. Gynekologicko-porodnická klinika – FNB
Obilní trh 11 656 77 Brno e-mail: pventrub@fnbrno.cz
doc. MUDr. Jiří Vokurka, CSc. I. chirurgická klinika – FN u sv. Anny Pekařská 53 602 00 Brno
prof. MUDr. Jindřich Vomela, CSc. ChirurgickáklinikaFNB Jihlavská 20 639 00 Brno e-mail: jvomela@fnbrno.cz
prof. MUDr. Jiří Vorlíček, CSc. Interní hematoonkologické klinikaFNB Jihlavská 20 639 00 Brno
e-mail: jvorlic@fnbrno.cz
prof. MUDr. Miroslav Votava, CSc. Mikrobiologický ústav LF a FN u sv. Anny, Brno e-mail: mvotava@med.muni.cz
doc. MUDr. Rostislav Vyzula, CSc. MOÚ – Klinikakomplexní onkologické péče Žlutý Kopec 7 656 53 Brno e-mail: vyzula@mou.cz
MUDr. Petr Zatočil MOÚ – Oddělení gynekologické onkologie Žlutý Kopec 7
656 53 Brno e-mail: zatocil@mou.cz
prof. MUDr. Jan Žaloudík, CSc. MOÚ – Chirurgické oddělení Žlutý Kopec 7
656 53 Brno
e-mail: zaloudik@mou.cz
Prof. MUDr. Zdeněk Adam, CSc., prof. MUDr. Jiří Vorlíček, CSc., a kolektiv
DIAGNOSTICKÉ A LÉČEBNÉ POSTUPY U MALIGNÍCH CHOROB
Druhé, aktualizované a doplněné vydání
OBRAZOVÁDOKUMENTACE:
MUDr. Jiří Vaníček, doc. MUDr. Petr Krupa, CSc., MUDr. Zdeněk Ráčil, CSc.
RECENZE:
Doc. MUDr. Jitka Abrahámová, DrSc.
Doc. MUDr. Petr Cetkovský, Ph.D.
© Grada Publishing, a.s., 2004
© Springer-Verlag, 2003, pro kapitoly 62 až 71
Cover Design © Grada Publishing, a.s., 2004
Vydala Grada Publishing, a.s.
U Průhonu 22, Praha 7 jako svou 1988. publikaci
Odpovědný redaktor doc. MUDr. Jan Klíma, CSc.
Obrázky dodali autoři
Sazba a zlom Petr Hloušek
Počet stran 692+ 4 strany barevné přílohy
Vydání druhé, aktualizované a doplněné, Praha 2004
Vytiskla tiskárna PBtisk s.r.o.,
Prokopská 87, Příbram VI
Tato kniha vyšla za laskavého přispění firmy Roche s.r.o.
Názvy produktů, firem apod. použité vknize mohou být ochrannými známkami nebo registrovanými známkami příslušných vlastníků, což není zvláštním způsobem vyznačeno.
Postupy a příklady vtéto knize, rovněž tak informace o lécích, jejich formách, dávkování a aplikaci jsou sestaveny snejlepším vědomím autorů. Zjejich praktického uplatnění však pro autory ani pro nakladatelství nevyplývají žádné právní důsledky.
Všechna práva vyhrazena. Tato kniha ani její část nesmí být žádným způsobem reprodukovány, ukládány či rozšiřovány bez písemného souhlasu nakladatelství.
ISBN 80-247-0896-5
Obsah
ředmluva kdruhému vydání ...............................................................................................................11
1Maligní nádory mozku (Cejpek P., Krupa P., Štourač P., Štěrba J.) .....................................................13
2Maligní nádory hlavy akrku (Smilek P., Kostřica R., Mechl Z., Spurný V.) .........................................27
3Bronchogenní karcinom (Skřičková J., Špelda S., Kaplanová J., Merta Z., Pálková I., Salajka F., Vomela J.) ................................................................................................................................41
4Maligní mezoteliom (Špelda S., Skřičková J.) ..........................................................................................63
5Thymom (BabičkováL., Skřičková J.). .....................................................................................................69
6Karcinom jícnu (Vokurka J., Němec J., Spurný V.) .................................................................................75
7Karcinom žaludku agastrointestinální stromální nádory (Vokurka J., Němec J., Spurný V., Kiss I.).....83
8Kolorektální karcinom (Vokurka J., Adam Z., Žaloudík J., Vyzula R., Krupa P., Prášek J., Hep A., Kiss I.) ..........................................................................................................................95
9Karcinom pankreatu (Vokurka J., Němec J., Spurný V.) ........................................................................111
10Hepatocelulární karcinom (Kala Z., SvobodaT., Kiss I., Pokorný A.) ..................................................121
11Karcinom žlučníku ažlučových cest (Kala Z., SvobodaT., Vomela J., Kiss I.) ....................................129
12Karcinom análního kanálu (Šlampa P., Tomášek J., Korbička J., Šeneklová Z.) ..................................137
13Neuroendokrinní nádory střeva apankreatu (APUDomy) (Hrbková V.) ............................................143
14Kožní nádory (Pirochtová K.) ..................................................................................................................151
15Nádory ledvin (Rovný A., Filipenský P., Šabacký I., Rovný F., Spurný V., Mechl Z.) ............................159
16Karcinom prostaty (Čapák I., Kocák I., Čoupek P.) ...............................................................................169
17Testikulární nádory (Kocák I., PalácováM.) ..........................................................................................185
18Karcinom močového měchýře (Rovný A., Filipenský P., Šabacký I., Rovný F., Spurný V., Mechl Z.) ....197
19Maligní nádory penisu (Pacík D., Čermák A.) ........................................................................................209
20Karcinom prsu (Vyzula R., Neumanová R., Skovajsová R.) ....................................................................213
21Zhoubné nádory vaječníků (Kalábová R., Čechovský P.) ......................................................................231
22Maligní nádory endometria (Chovanec J., Rašovská O.) .......................................................................241
23Trofoblastický choriokarcinom (Chovanec J.) .......................................................................................251
24Karcinom děložního čípku (Kalábová R., Čechovský P.) .......................................................................257
25Maligní nádory pochvy azevních rodidel (Kalábová R., Čechovský P., Zatočil P.) ............................267
26Maligní melanom (Fait V.) .......................................................................................................................273
27Retinoblastom (Řehůřek J., Autrata R.)....................................................................................................283
28Karcinom štítné žlázy (Hrbková V.) ........................................................................................................287
29Karcinom nadledvin adalší nádory endokrinních žláz (Hrbková V.) .................................................297
30Kostní sarkomy (Janíček P.) ....................................................................................................................305
31Sarkomy měkkých tkání (Žaloudík J.) ....................................................................................................313
32Kaposiho sarkom (Vašků V.) ....................................................................................................................319
33Ewingův sarkom aperiferní neuroektodermální tumor (Štěrba J., KepákT., Skotáková J.) .............325
34Nádory srdce (ElblL.) ..............................................................................................................................331
35Jaterní metastázy (Kala Z., SvobodaT., Kiss I., Hanke I., Pokorný A.) .................................................335
36Metastázy nádorů neznámé primární lokalizace: (Kiss I., Tomášek J., Král Z.) .................................339
37Solidní nádory udětí: neuroblastom, nádory CNS, germinální nádory, sarkomy měkkých tkání, nefroblastom (Štěrba J., Skotáková J., Dembická D., Magnová O., Pavelka Z., Múdry P., Valík D., Gregorová V., Slaný J.) ..............................................................................................................347
38Myelodysplastický syndrom amyelodysplastické myeloproliferativní choroby (Adam Z., PenkaM., DoubekM.) ..............................................................................................................359
39Akutní myeloidní leukemie (Adam Z., DoubekM., PenkaM.) ...............................................................371
40Akutní lymfatická leukemie (DoubekM.) ...............................................................................................379
41Myeloproliferativní nemoci (DoubekM., Adam Z.) ................................................................................385
42Přehled maligních lymfoproliferativních onemocnění dle REAL aWHO klasifikace (Adam Z., Dvořák K.) ..423
43Správný postup při chirurgickém odebírání lymfatické uzliny ajejím dalším zpracování (Dvořák K., Žaloudík J., Coufal O.) .......................................................................................433
44Nehodgkinské lymfomy nízké agresivity (Adam Z., Vorlíček J.) ...........................................................439
45Folikulární lymfomy (Adam Z., Vorlíček J.) ............................................................................................447
46Chronická B-lymfatická leukemie (Adam Z., Vorlíček J.) .....................................................................453
47Vlasatobuněčná leukemie (Adam Z., Vorlíček J.)....................................................................................463
48Lymfomy asociované smukózní tkání – MALT-lymfomy aostatní lymfomy zažívacího traktu (TomíškaM., Adam Z., Vorlíček J.) ............................................................................469
49Mycosis fungoides, Sézaryho syndrom adalší kožní lymfomy (Adam Z., Vorlíček J.) .......................475
50Agresivní maligní lymfomy (Adam Z., Vorlíček J.) .................................................................................481
51Difuzní velkobuněčný B-lymfom (Adam Z., Vorlíček J.) ........................................................................485
52Vysoce agresivní lymfomy (Adam Z., Vorlíček J.) ..................................................................................493
53Hodgkinova choroba (Král Z., Adam Z., Vorlíček J.)..............................................................................497
54Monoklonální gamapatie nejasného významu (Adam Z.) .....................................................................511
55Mnohočetný myelom adalší plazmocelulární malignity (Adam Z., KrejčíM., Hájek R.) ...................515
56Waldenströmova makroglobulinemie (Adam Z.) ...................................................................................531
57AL-amyloidóza aněkteré další typy amyloidóz (Adam Z.) ...................................................................535
58Maligní nehodgkinské lymfomy vdětském věku (KepákT., Slaný J., Dembická D.) ..........................541
59Leukemie vdětském věku (Hrstková H.) ................................................................................................543
60Histiocytární choroby amastocytózy (Adam Z., Adamová Z.) ..............................................................547
61Získaná aplastická anemie (Adam Z., Cetkovský, P.) ............................................................................551
Kapitoly 62–71: Diagnostika aléčba infekcí uonkologicky nemocných
Doporučení Německé hematoonkologické společnosti (2003)
62Antimikrobiální léčba horečky nejasného původu uneutropenických pacientů ..............................559
63Diagnostika aantimikrobiální léčba plicních infiltrátů upacientů sfebrilní neutropenií ..............573
64Diagnostika aléčba potvrzené infekce uneutropenických pacientů ..................................................583
65Léčba mykotických infekcí vhematologii aonkologii .........................................................................589
66Diagnostika invazivních mykotických infekcí vhematologii aonkologii ..........................................597
67Infekce související scentrálními žilními katétry uneutropenických nemocných ............................603
68Sepse uneutropenických nemocných ....................................................................................................611
69Antimikrobiální léčba febrilních komplikací po vysokodávkované chemoterapii spřípadnou radioterapií aautologní transplantací krvetvorných buněk .......................................619
70Infekční komplikace po alogenní transplantaci krvetvorné tkáně .....................................................627
71Profylaxe invazivních mykotických infekcí unemocných shematologickými maligními chorobami asolidními tumory ...............................................................................................................637
72Infekční komplikace ajejich prevence udospělých pacientů po splenektomii nebo sfunkčním hyposplenismem (Ráčil, Z.) .................................................................................................643
73Transplantace krvetvorných buněk (Mayer J.)......................................................................................649
74Maligní oční nádory aoční projevy jiných nádorů a protinádorové léčby (Skorkovská Š.) ..............659
75Teplota nejasné etiologie (FUO –fever of unknown origin) (Křivanová, A.) .........................................667
Závěr ...........................677
Rejstřík ......................................................................................................................................................681
AJCC American Joint Committee an Cancer
AFP alfa-fetoprotein
ALL akutní lymfoblastická leukemie
ALP alkalická fosfatáza
AML akutní myeloblastická leukemie
AMLM3 promyelocytární leukemie
AML akutní myeloidní leukemie
AMM agnogenní myeloidní metaplazie
APUD Amina Precursor Uptake and Decorboxilation
AUL acute undiferentiated leukemia – akutní nediferencovaná leukemie
B2M beta2-mikroglobulin
B-CLL chronická Blymfatická leukemie
BMT transplantace kostní dřeně
CEA karcinoembryonální antigen
CIN cervikální intraepiteliální neoplazie
CMGM chronická megakaryocytární granulocytární myelóza
CML chronická myeloidní leukemie
CMML chronická myelomonocytární leukemie
CMV cytomegalovirus
CNS centrální nervový systém
CRP C-reaktivní protein
CT výpočetní (počitačová) tomografie
CVT centrální venózní tlak
CYFRA 21-1 cytokeratin fragment
DCIS duktální karcinom in situ
DIK diseminovaná intravaskulární koagulace
EMGM esenciální megakaryocytární granulocytární myelóza
ESMOEvropská onkologická společnost
ET esenciální trombocytemie
FAB Francouzko-anglicko-britská klasifikace leukemií amyeproliferací
FEL familiární erytrofagocytární lymfohistiocytóza
FER feritin
FIGO Federation International of Gynecology and Obstetric
FISH fluorescenční in situ hybridizace
FNA Fine Needle Aspiration – aspirace tenkou jehlou
FPSA volný prostatický specifický antigen
G-CSF granulocyty kolonie stimulující faktor
gGRs Hematopoietic Growth Factors
GM-CSF granulocyty-makrofágy kolonie stimulující faktor
GTN gestační trofoblastická nemoc
Gy gray, jednotka dávky záření
HAI Hepatic Artery Infusion (infuze do arteria hepatica)
hCG lidský choriogonadrotopin
HD Hodgkinova choroba
HHV Human Herpes Virus 8 (lidský herpes virus 8)
HIV Human Immunodeficiency Virus
HPV lidský Papiloma Virus
HSV Herpes Simplex Virus
HTLV lidskýT-lymfotropní virus
IAHS Infection Associated Hemophagocytic Syndrom – sinfekcí asociovaný hemofagocytický syndrom
IHES idiopatický hypereozinofilní syndrom
IL interleukiny
IM idiopatická myelofibróza
JMML juvenilní myelomonocytární leukemie
LCIS lobulární karcinom in situ
LITT laserem indukovaná termoablace
MDCT multidetektorová CT
MDS myelodysplastický syndrom
MEN mnohočetná endokrinní neoplazie
MIBI metoxyisobutylisonitril
MMM myelofibróza smyeloidní metaplazií
NCCN National Cancer Comprehensive Network
NHL nehodgkinský lymfom
NSE neuron-specifická enoláza
OPSI Overhelming Postsplenectomy Infection (prudké infekce po splenektomii)
PAP prostatická kyselá fosfatáza
PAS „Periodic Acid Schiff“ reakce
PBSC periferní kmenové buňky krvetvorby
PCR Polymeraze Chain Reaction, polymerázová řetězová reakce
PET pozitronová emisní tomografie
PIN prostatická intraepiteliální neoplazie
PNET primitivní neuroektodermální nádor
PSA prostatický specifický antigen
PV polycytemia vera
RA refrakterní anemie
RAEB refrakterní anemie snadbytkem blastů
RAEB IRAEB sblasty do 10 %
RAEB II RAEB sblasty do 20 %.
RAEB-t refrakterní anemie snadbytkem blastů vtransformaci
RARS refrakterní anemie sprstenčitými (ring) sideroblasty
RCMD refrakterní cytopenie smultilineární dysplazií
RFA radiofrekvenční ablace
SCC antigen skvamózních buněk
SLVL splenický lymfom svilózními lymfocyty
SP1 beta1-specifický glykoprotein
T-CLL chronickáTlymfatická leukemie
TK thymidinkináza
TKD transplantace kostní dřeně
TNF Tumor Necrosis Factor
TPA tkáňový polypeptidový antigen
TPS specifický TPA
TRUS transuretrální sonografie
TSH Thyroxin Stimulating Hormon – tyreoideu stimulující hormon
UICC International Union Agains Cancer
UZ ultrazvuk
UZV ultrazvukové vyšetření
VAIN vaginální intraepiteliální neoplazie
VIP vazoaktivní intestinální polypeptid
VZV Varicela-Zoster Virus
WHO World Health Organisation, Světová zdravotnická organizace
Poznámka: Do seznamu zkratek byly převzaty jenom zkratky nacházející se vtextu. Zkratky obsažené vtabulkách nebo grafech jsou vysvětleny vždy pod tabulkou či grafem.
Vážení čtenáři, dostává se vám do rukou kniha, kterou jsme nazvali Diagnostické aléčebné postupy u maligních chorob. Navazuje na naše předchozí publikace: J. Vorlí č ek, Z. Adam aspolupracovníci: Paliativní lé č ba, Grada, Praha 1999, J. Vorlí č ek, R. Vyzula, Z. Adam, aspolupracovníci: Praktická onkologie, Grada, Praha 2000 adále na nedávno vydanou knihu Z. Adam, J. Vorlí č ek aspolupracovníci: Hematologie II – P ř ehled maligních hematologických nemocí, Grada, Praha 2001.
Publikace, kterou držíte vrukou, si klade za cíl:
• podrobně referovat opříznacích jednotlivých chorob,
• popsat diagnostické postupy,
• definovat koncepty standardních léčebných postupů pro jednotlivá klinická stadia uvedených nemocí na podkladě „medicíny založené na důkazech (evidence based medicine)“,
• navrhnout systém preventivních onkologických prohlídek na základě stratifikace pacientů dle rizikových skupin.
Pro koho je kniha určena? Knihu jsme psali tak, aby byla přínosem pro všechny lékaře, kteří se setkávají smaligními chorobami, tedy jak pro lékaře první linie, za nimiž pacienti přicházejí spříznaky počínající nebo již pokročilé nemoci, tak pro specialisty nehematology aneonkology, kteří se vrámci svého zaměření stěmito pacienty také setkají. Je na nich, aby stanovili diagnózu, nebo řešili komplikace, které choroba přináší. Stejně tak může být přínosem pro studenty medicíny anakonec ipro specialisty na léčbu maligních chorob.
Proč uvádíme tak širokou čtenářskou obec? To proto, že lékař, který si není vědom existence některé nozologické jednotky, tedy neznající její příznaky, ji nemůže usvého pacienta rozpoznat adiagnostikovat.
V části věnované léčbě si autoři stanovili cíl předložit takzvané léčebné koncepty. To znamená přesně definovat optimální standardní léčebné postupy, které náleží jednotlivým klinickým stadiím
dle informací dostupných vroce 2001. Podrobný popis jednotlivých léčebných metod však neuvádíme. Pro přehlednost jsou jednotlivé koncepty znázorněny grafickými schématy. Považujeme totiž za vhodné, aby neonkologové anehematologové znali koncepty léčby jednotlivých chorob amohli usvých pacientů posoudit, zda jsou léčeni odpovídajícím způsobem. Pokud zjistí že ne, měli by to organizačně zajistit (poslat pacienta na příslušné odborné pracoviště).
Co je to „standardní optimální léčba“?
Po nalezení nového léku či léčebné metody představuje tento lék či metoda takzvanou experimentální léčbu. Tato léčba se napřed testuje vrámci menších klinických studií (I. aII. fáze), ověřujících její bezpečnost, apokud se vtěchto studiích osvědčí, je testována prospektivními randomizovanými klinickými studiemi III. fáze na stovkových až tisícových souborech pacientů. Do doby, než výsledky těchto velkých klinických studií III. fáze jsou zveřejněny, je léčba stále považována za experimentální. Pokud její přínos (lepší účinnost, než měla předchozí standardní léčba) potvrdí jedna, lépe však více velkých prospektivních randomizovaných studií, stává se tato léčba léčbou standardní (pokud je pro společnost ekonomicky únosná) apřekonaná metoda léčby je léčbou obsolentní. Pokud dopadne její testování asrovnávání spředchozími postupy nepříznivě, je zavržena, azůstává trvale jen metodou experimentální, jejíž přínos se nepotvrdil.
Co se ale skrývá pod slovíčkem lepší účinnost?
Zcela zřejmým (čili tvrdým) kritériem, že je nějaká léčebná metoda lepší, je statisticky, ale ilidsky významné prodloužení mediánu přežití nebo zvýšení počtu pacientů vkompletní remisi po 5 letech od začátku léčby.
Jak rychle najít informaci, co je nejlepší standardní léčba pro současné období?
Aby lékaři nemuseli studovat kvanta literatury, popisující výsledky klinických studií zoblastí, jimiž se
Diagnostické a léčebné postupy u maligních chorob
přímo nezabývají, jsou uvedené informace pravidelně shrnovány týmy odborníků, které definují takzvanou minimální standardní léčbu pro určité období. Za nejpropracovanější aodborně nejvíce podložené považujeme léčebné doporučení National Comprehensive Cancer Network (NCCN). Poslední verze tohoto doporučení je zroku 2000. Je naděje, že koncem roku 2001 bude kdispozici na webových stránkách, na adrese http://www.nccn.org. Vkapitolách jsou citována také doporučení evropské společnosti nazvané European Society of Medical Oncology, která se objevila poprvé vroce 2001 v8. čísle časopisu Annals of Oncology amají být zveřejňována také na webových stránkách této společnosti. Doporučení ESMO jsou však podstatně stručnějí 1–2 stránková než doporučení NCCN, která jsou nepoměrně objemnější apodrobnější.
Informace oléčbě leukemií lze zjistit na adrese: http://www.kompetenznetz-leukaemie.de.
Uvedená doporučení NCCN vznikají vrámci skupin (boards) vedoucích odborníků na příslušné onemocnění ze všech význačných nemocnic aústavů USA. Na základně všech dostupných výsledků klinických studií tyto komise definují takzvané standardní, klinickými studiemi ověřené adoložené postupy. Léčebné postupy prováděné, avšak nevyhodnocené, označují za experimentální.
Kapitoly naší publikace byly konfrontovány sdoporučeními NCCN zroku 2000 ajsou snimi zcela vsouladu, vmnoha kapitolách jsou tato doporučení přímo citována. Lze tedy konstatovat, že tato publikace informuje odoporučení NCCN pro léčbu solidních nádorů
Kapitoly však nejsou tak podrobné jako NCCN doporučení, aproto zájemcům opodrobnosti aspecialistům doporučujeme originální NCCN publikaci, která je dostupná v ČR na kompaktním disku (tento CD byl onkologům poskytnut firmou BristolMyers-Squibb).
Část knihy, věnovaná krevním maligním chorobám vychází zpublikace Adam, Z., Vorlíček J. aspol.: Hematologie II – Přehled maligních hematologických nemocí, Grada, Praha 2001. Kapitoly jsou výrazně, ale opravdu výrazně zkrácené, upravené apřepracované tak, aby reflektovaly WHO klasifikaci krevních chorob, publikovanou koncem roku 2001. Léčebná doporučení – minimální standardní léčba – pro velkobuněčné B-lymfomy apro Hodgkinovu chorobu vychází zdoporučení ESMO (European Society of Medical Oncology) zroku 2001. Doporučení léčby ostatních chorob se opírá ozávěry velkých klinických studií, dostupných do konce roku 2001.
Aještě jedna poznámka. Vzhledem ktomu, že původní latinské názvosloví dnes nahrazují nově vznikající anglické termíny, uvádíme tuto anglickou terminologii vzávorkách, aby byl jasný originální termín, neboť při překladu do češtiny je často možné zvolit více synonym, čímž vznikají nepřesnosti v české terminologii.
Doufáme, že se tato kniha stane užitečným pomocníkem všech lékařů, ato jak pro diagnostiku, tak pro stanovení léčebného konceptu ujednotlivého pacienta.
Autoři
Předmluva kdruhému vydání
Druhé přepracované adoplněné vydání vychází vrelativně nedlouhém odstupu od prvního vydání zroku 2002. Vývoj voboru je však natolik rychlý, že ipřes nevelký časový odstup bylo nutné původní rukopis na mnoha místech pozměnit, rozšířit adoplnit. Vdruhém vydání jsou zachyceny změny vléčebných postupech ujednotlivých chorob, knimž došlo vposledních letech. Podobně jako vpředchozím vydání, kde byla uvedena doporučení NCCN zroku 2000, obsahuje druhé vydání informace oléčebných doporučeních NCCN zroku 2003. Vojedinělých případech, kdy se doporučení NCCN liší od názorů evropských autorů, citujeme idoporučení Německé onkologické společnosti (Kurzgefasste Interdisziplinäre Leitlinien, W. Zuzkschwerd Verlag 2002 552 s). Okontrolu, změny adoplňky ke kapitolám osolidních tumorech se hlavn ě zasloužili: primá ř MUDr.Igor Kiss, MUDr.Jiří Tomášek aMUDr Jana Marková.
Vdruhém vydání této knihy jsme záměrně vynechali několik kapitol, které jsou vširším rozsahu uvedeny vknize Obecná onkologie apodpůrná léčba, Grada 2003, obě knihy tvoří jeden funkční celek.
Cílem obou publikací je pomoci ke zlepšení diagnostiky aléčby maligních chorob. Zúdajů, které byly zveřejněny vsuppl. 5 časopisu Annals of Oncology vyplývá, že ve srovnání sostatními zeměmi EU máme co dohánět. Považujeme za zajímavé zde uvést údaje opravděpodobnosti relativního 5-letého přežití, vyjádřeného vprocentech, uvšech maligních chorob ve vybraných zemích vletech 1990–1994. Pro ilustraci vybíráme údaje ověkové kategorii 45–54 let, muže/ženy: Rakousko 56,8/71,8, ČR 29,9/57,5, Dánsko 43,9/63,6, Anglie 41,1/65,4, Estonsko 25/55,2, Finsko 44,2/74,9, Francie 41,1/75,8, N ě mecko 39,2/66,7, Itálie 45/71,4, Holandsko 45,2/68, Norsko 50/68,9, Polsko 24,9/52,1, Slovensko 25,8/58,7, Švýcarsko 52,7/72,6, Evropa 41/67,2. (Roazzi, P et al.: Electronic availability of Eurocare-3 data: atool for futher analysis. Ann. Oncol., 14, 2003, 150–155).
Uvedená kumulativní data říkají, že v ČR muži uvedené věkové kategorie, unichž vznikne maligní onemocnění, mají 29 % pravděpodobnosti žít déle než 5 let od stanovení diagnózy, zatímco ženy v ČR mají 57,5 % pravděpodobnost žít déle než 5 let po stanovení diagnózy, kdežto evropská průměrná pravděpodobnost žít po stanovení diagnózy maligní choroby déle než 5 let je pro muže 41% apro ženy 67,2 %.
Tato hrubá data ovšem nelze interpretovat pouze tak, že v ČR mají pacienti horší léčbu. Mimo jiné záleží jistě na rozdílech mezi uvedenými zeměmi ve výskytu rychle smrtících typů nádorů. Velmi důležitým faktorem je také zdravotní uvědomění občanů, které spolu súrovní první linie zdravotní péče velmi ovlivňuje časnost záchytu, atím ivýsledek léčby. Proto je tato kniha určena nejen pro specialisty, kteří tyto choroby léčí, ale ipro všechny lékaře, kteří tyto nemoci diagnostikují apředávají kléčbě do dalších center, případně léčí komplikace vzniklé vprůběhu léčby. Každýlékař by měl znát projevy maligních chorob, možnosti jejich rychlého rozpoznání aměl by být informován osoučasných léčebných konceptech.
Zásadní novinkou této knihy je 10 kapitol (62–71) týkajících se léčby infekčních komplikací. Po domluvě ase souhlasem profesora Georga Maschmeyera, vedoucího pracovní skupiny pro léčbu infekcí vrámci Německé hematologické aonkologické společnosti (Arbeitsgemeinschaft Infektionen in der Hämatologie und Onkologie (AGIHO), Fachgruppe der Deutschen Gesellschaft für Hämatologie und Onkologie (DGHO) apo dohodě snakladatelstvím Springer Verlag jsme přeložili doporu č ení pro diagnostiku alé č bu infek č ních komplikací uonkologických pacientů. Tato doporučení byla zveřejněna vsrpnu 2003 v časopise Annals of Hematology vol. 82, 2003, suppl.2. aměla by být trvale knahlédnutí na internetové adrese www.dgho-infectionen.de. Předchozí léčebná doporučení pro pacienty sinfekčními komplikacemi
Diagnostické a léčebné postupy u maligních chorob
zveřejnila tato společnost vroce 1999 vsupplementu časopisu Dtsch. Med. Wochenschr. Aprávě dlouhodobá asystematická tvorba těchto léčebných doporučení je zárukou jejich kvality jak zhlediska odborného obsahu, tak zhlediska didaktické úrovně, neboť obecně tvorba nových přepracovaných vydání zvyšuje jejich kvalitu.
Na překladu textu spolupracovali Zdeněk Adam, Miroslav Votava aZdenka Adamová. Překlad textu ozobrazovacích metodách připravil Jiří Vaníček apřeklad textu odiagnostice spomocí metod molekulární biologie Jana Šmardová. Obrazovou dokumentaci do této části připravil Zdeněk Ráčil aTomáš Nebeský.
Při přípravě rukopisu jsem zvažovali, zda uvést či neuvést obsáhlý seznam literatury, zněhož tato doporučení vycházejí. Nakonec převážilo ekonomické hledisko, neboť se domníváme, že většina čtenářů nebude citaci těchto literárních zdrojů postrádat apokud je některý čtenář bude chtít mít, snad nebude pro něj
větším problémem opatřit si spomocí knihovní služby xerokopie originálního anglického textu. Další alternativou je elektronická forma tohoto časopisu, která má adresu http://link.springer.de/alert/ nebo http://link.springer-ny.com/alert/ Další adresy jsou http://link.springer.de/alert/ nebo http://link.springer-ny.com/alert/ Na otázku, proč jsme zvolili pro překlad právě tato doporučení ane třeba doporučení Americké onkologické společnosti odpovídáme, že mezi nimi není zásadní obsahový rozdíl, ale že zhlediska didaktického podání se nám nejvíce líbila právě doporučení vytvořená DGHO.
Věříme, že doporučení pro léčbu infekčních komplikací, vytvořená vzemi našich sousedů, ocení všichni lékaři, kteří mají vnáplni práce řešení těchto závažných situací.
Zdeněk Adam aJiří Vorlíček
1Maligní nádory mozku
1.1 Definice
Primární maligní nádory mozku jsou expanzivně se chovající intrakraniální procesy, které vyrůstají zmozkové tkáně (neurony, glie) nebo zokolních struktur (meningy, nervové pochvy). Knim lze přiřadit zcela vzácně se vyskytující primárně vmozku lokalizovaný germinom ze zárodečných tkání aprimární mozkový lymfom.
Primární tumory mozku udospělých tvoří velmi heterogenní skupinu nádorů, znichž některé rostou pomalu ajsou chirurgicky vyléčitelné (pilocytární astrocytomy), jiné jsou vysoce agresivní anevyléčitelné (glioblastoma multiforme). Maligní nádory mozku infiltrují do okolní mozkové tkáně aněkteré mohou metastazovat vrámci nervového systému. Zcela ojediněle se mohou vdospělém věku vyskytnout nádory CNS dětského věku (neuroblastom). Léčba dospělých stímto onemocněním by měla být realizována dle protokolů pacientů dětského věku.
Sekundární maligní nádory mozku jsou způsobeny metastazováním maligních tumorů jiného původu do nervového systému, jejich incidence je 10x vyšší než incidence primárních mozkových nádorů
1.2 Epidemiologie
Primární nádory mozku (CNS) tvoří 1,4 až 4,2% všech maligních nádorů. Některé typy nádorů mozku postihují typicky určité věkové kategorie. V ČR bylo vroce 1989 nahlášeno 260 nových onemocnění umužů a224 užen, vroce 1998 to již bylo umužů 341 (6,8/100 000) užen 292 (5,5/100 000). K31. 12. 1998 bylo dispenzarizováno 1758 nemocných.
1.3 Etiologické faktory
Na etiologii nádorů CNS se podílejí jak genetické příčiny, tak řada zevních příčin: onkogenní viry,
chemické látky, radioaktivní záření. Zchemických látek to jsou etylnitrózomočovina avinylchlorid. Rovněž polychlorované bifenyly jsou dávány do souvislostí se vznikem maligních nádorů mozku pro svoji liposolubilitu anedostatečnou biodegradaci.
Vněkterých rodinách lze sledovat rodinný výskyt maligních gliomů. Vtěchto případech se předpokládá existence predisponující genetické výbavy, která umožní vnějším faktorům spustit mechanismus zhoubného bujení.
1.4 Symptomy nemoci
1.4.1 Bolest hlavy
Iniciálním příznakem mozkového nádoru bývá difuzní bolest hlavy, která je obvykle přítomna již ráno aje způsobena drážděním nociceptivních struktur vdůsledku růstu nádoru. Každá nově vzniklá bolest hlavy je důvodem kvyloučení tumoru CNS.
1.4.2 Psychické změny
Psychické změny (zvýšená podrážděnost aafektivní labilita, agresivita) mohou být také projevem primárního nádoru nebo metastázy CNS. Někdy může nádor způsobit celkovou změnu osobnosti.
1.4.3 Syndrom nitrolební hypertenze
Příznakem pokročilého onemocnění je syndrom nitrolební hypertenze. Ta se projevuje:
•zvracením bez předchozí nauzey (zvracení obloukem)
•silnou bolestí hlavy
•zvýrazněním ložiskových příznaků
•kvantitativními poruchami vědomí
Unádorů čelních laloků nalézáme změny osobnosti (tzv. prefrontální syndrom).
1.4.4 Epileptické záchvaty
Epileptické záchvaty jsou iniciálním příznakem ucelé jedné čtvrtiny pacientů stumory CNS. Vprůběhu celé choroby se epilepsie vyskytuje utřetiny pacientů
1.4.5 Ložiskové příznaky
Při postižení frontodorzální oblasti dominantní hemisféry dochází kexpresivní fatické poruše. Nádory, které jsou uloženy vcentrální oblasti apostihují gyrus precentralis, se projevují motorickými záchvaty vopačné polovině těla (Jacksonova epilepsie) aprohlubující se hemiparézou taktéž vopačné polovině těla.
Při postižení okcipitálního laloku se vyskytuje homonymní hemianopsie. Nádor uložený vtemporálním laloku se projevuje psychomotorickou epilepsií (kvalitativní změna vědomí spojená sautomatickými pohybovými stereotypy – žvýkání, mlaskání apod.). Léze voblasti zadní třetiny temporálního laloku dominantní hemisféry vede kpercepční fatické poruše a často ke smíšeným formám afázie.
Při nádorech voblasti středního mozku je charakteristická obrna pohledu vzhůru sporuchami reakce zornic (chybí reakce na osvit při většinou zachované konvergenci) advojité vidění. Tento tzv. Parinaudův syndrom nenalezneme jen při procesech ve středním mozku, nýbrž ipři nádorech epifýzy (pinealomech) atlaku na čtverohrbolí.
Příznaky mozečkových nádorů je neocerebelární syndrom vdůsledku postižení mozečkových hemisfér (zvýšená pasivita končetin, hlavy, snížení extrapyramidových reflexů (EPR), hypermetrie aadiadochokineze) asyndrom paleocerebelární vdůsledku postižení vermis (velká asynergie, tj. nesprávná vzájemná koordinace končetin atrupu ve stoji achůzi). Nejčastějším zhoubným nádorem vtéto oblasti je meduloblastom, nádor dětského věku.
Nádory voblasti mozkového kmene jsou charakteristické neurologickým syndromem sporuchami mozkových nervů na straně ložiska. Často se vyskytuje iataxie homolaterálních končetin jako důsledek přerušení vzestupných mozečkových drah aspastické motorické parézy ahemihypestezie kontralaterálně.
Pro nádory rostoucí voblasti mozkových komor je charakteristická dlouhá klinická latence, neboť pro svůj růst vkomoře mají dostatek místa. Postupně dochází krozvoji hydrocefalu, který se vurčitém stup-
ni začne projevovat známkami nitrolební hypertenze. Kložiskovým příznakům dochází až velmi pozdě, podle toho, zkteré části komory nádor vyrůstá.
1.5 Diagnostický postup
Podezření na mozkový nádor vzbudí ložiskové příznaky nebo rozvíjející se nitrolební hypertenze. Vpočátečním stadiu může abnormální EEG nález toto podezření podpořit.
CT nebo MR zobrazení saplikací kontrastní látky
Tato dvě vyšetření jsou zlatým standardem pro diagnostiku nádorů CNS. Pro lékaře indikujícího

Obr. 1.1 Glioblastom, stav po kraniotomii, CT obraz po i.v. aplikaci kontrastní látky ukazuje heterogenní, expanzivně se chovající útvar s útlakem a přetlakem postranních komor a posunem středočárových struktur. Tvar je nepravidelný – na jednom řezu klamně působí jako multifokální. Rozpadlé centrum je ohraničeno prstenčitou zónou zvýšeného enhancement (hyperdenzity) po aplikaci k.l. i.v. představující oblast nádoru s porušenou hematoencefalickou bariérou –šipka bílá. Okolí útvaru je ovládnuto hypodenzním perifokálním edémem, který však obsahuje nádorové buňky – šipka čárkovaná. Hranice edému představuje prakticky hranici nádoru.
CT nebo MR vyšetření je podstatné vědět, že vnativním zobrazení nemusí být tumor vždy zřetelný, proto je nutné provést vyšetření spoužitím kontrastních látek. Výsledek zobrazovacího vyšetření může svelmi vysokou pravděpodobností informovat opřítomnosti maligního expanzivního ložiska viz obr. 1.1., 1.2., 1.3. Takovýto nález je dostatečnou indikací koperačnímu zákroku. Vdětském věku je možné provést ultrasonografické vyšetření mozku.
Radionuklidové zobrazení
Vdiagnostice mozkových nádor ů je možné použít rovn ě ž radionuklidové techniky. Nejv ě tší nad ě je jsou kladené na diagnostiku pomocí 19 FDG (19-fluorodeoxyglukózy). Toto vyšetření je schopno odlišit recidivu nádoru od radiační nekrózy.
Stereotaktická biopsie
Jsou-li nejasnosti, lze použít stereotaktickou biopsii azískat vzorek tkáně zpodezřelé oblasti. Stereotaktická biopsie umožní spřesností 1mm odběr tumorózní tkáně aurčení histologické skladby nádoru.Vzorky tkáně odebrané znekrotického centra nebo zedematózní oblasti mohou přinést falešně negativní výsledky.
Vyšetření mozkomíšního moku
Cytologie likvoru při průkazu maligních buněk může jednak morfologicky stanovit diagnózu, jednak být využita kmonitorování terapeutického efektu. Diagnostická hodnota cytologického vyšet ř ení mozkomíšního moku je významnější především umetastazujících tumorů, zejména u leukemií alymfomů, ale také umetastáz solidních tumorů Některé primární mozkové nádory (glioblastom, meduloblastom, ependymom) mají schopnost metastazovat per continuitatem voblasti likvorových cest avtěchto případech může likvorová cytologie kdiagnostice významně přispět.
Diferenciální diagnóza
Expanzivní ložisko vCNS může být někdy způsobeno benigním patologickým procesem (abscesem, kavernomem, meningeomem), ale může jít také ometastázu známého nebo doposud ukrytého tumoru, viz obr. 1.4 a1.5. Do mozku často metastazují následující tumory: bronchogenní karcinom, obzvláště jeho malobuněčná varianta, karcinomy prsu aledvin. V80 %případů jsou tyto metastázy uloženy supratentoriálně.

1.2 Glioblastom – ve srovnání s CT poskytuje MR vyšetření více detailů jak o struktuře nádoru, tak i o jeho prostorovém rozsahu, umístění a vztahu k mozkovým strukturám. Za příklad slouží parasagitální řez v T1 váženém čase po aplikaci kontrastní látky i.v.

Obr. 1.3 CT pokročilého astrocytomu III.stupně, který je nápadný rozsahem své velikosti, expanzivním chováním a kolaterálním edémem.
Obr.

Obr. 1.4 Miliární metastázy mozku bronchogenního karcinomu s okluzí aquaeduktu a hydrocefalem. MR zobrazení v koronárním řezu v T1 váženém čase po aplikaci kontrastní látky i.v. Bílá šipka ukazuje v tektu umístěnou metastázu blokující svou expanzí aquaedukt.
Metastázy mohou vCNS vytvořit jak solitární, tak ivícečetná ložiska, mohou však také infiltrovat meningy (bronchogenní karcinom, karcinomy prsu ižaludku).
Informace, které lze získat odborným hodnocením MR či CT zobrazení mozku
Nález multiformního glioblastomu se při CT vyšetření zobrazuje jako hypodenzní ložisko s často vyjádřeným mass-efektem. Po nitrožilním podání kontrastní látky se uvíce než 90%nemocných zobrazuje hyperdenzní prstenec, tzv. ring sign Tento nález není typický jen pro glioblastom, ale je možno se sním setkat iumozkového abscesu. Podobně jako glioblastom může hypodenzní ložisko vCT obraze vytvořit rovněž metastatický nádor nebo infarkt mozku. Edém obklopující glioblastom je rozsáhlý amá nepravidelný prstovitý charakter. Po podání kontrastní látky se nasycení (enhancement) nevytvoří u60 %nízkostupňových astrocytomů, 30 %anaplastických astrocytomů, ale pouze

Obr. 1.5 Miliární metastázy mozku bronchogenního karcinomu s okluzí aquaeduktu a hydrocefalem. MR zobrazení v sagitálním řezu v T1 váženém čase po aplikaci kontrastní látky i.v. Bílá šipka ukazuje v tektu umístěnou metastázu blokující svou expanzí aquaedukt.
u6,5%glioblastomů. Platí, že čím vyšší je malignita, tím větší je imass-efekt.
Nový pohled na předoperační stanovení histologické klasifikace gliomů přineslo zavedení MR. Astrocytomy typu low-grade se vT2 váženém zobrazení znázorňují jako relativně homogenní léze vysoké intenzity. Ugliomů typu high-grade se znázorňuje nehomogenně hyperintenzní centrum ohraničené lemem méně zvýšené intenzity. Periferně leží zóna tvořící hyperintenzní široký lem sprstovitými výběžky. Podání gadolinia zpravidla vede kvytvoření enhancement. Vpodstatě platí, že heterogenita signálu spolu svýrazným mass-efektem odpovídá vyššímu gradingu.
1.6 Morfologický grading, WHO histologická klasifikace aklinická stadia
1.6.1 Histopatologická klasifikace mozkových nádorů
Unádorů mozku má označení maligní abenigní poněkud jiný význam než unádorů jiných lokalizací. Klasickou vlastností maligních nádorů mimo CNS
je jejich metastazování po celém organismu arovněž jejich infiltrativní růst do okolí.
Vpřípadě CNS nabývá termín maligní poněkud odlišný význam. Může se použít pro zhodnocení klinického významu nádoru, neboť ihistologicky benigní nádor, postihne-li důležité centrum nebo svou velikostí způsobí syndrom nitrolební hypertenze, může způsobit úmrtí pacienta, aje tedy pro pacienta vlastně tumorem maligním.
Častěji se však termínu maligní používá ve smyslu histologického obrazu nádoru CNS. Za projevy benignity či malignity se považuje rychlost proliferace, míra dediferenciace astím související sklon k časné recidivě atendence kinfiltrativnímu růstu. Na rozdíl od solidních nádorů, kde se nádory dělí na benigní amaligní (autěch se dále stanovuje histologický grading), uvádí histopatologická WHO klasifikace tumorů CNS čtyři stadia (I-IV), od benigního přes semibenigní, semimaligní až po vysoce maligní. Toto dělení do čtyř kategorií koresponduje shistologickým gradingem (G1 – dobře diferencovaný,G2 – mírně dediferencovaný,G3 – špatně diferencovaný,G4 – nediferencovaný).
WHO histopatogenetické hodnocení malignity vprincipu spočívá na stanovení základního histologického typu astupni dediferenciace. Zkrácenou verzi WHO histologické klasifikace tumorů CNS uvádí tabulka 1.1. Tato tabulka nepřestavuje pouze didaktické třídění, avšak zařazení tumoru do jednotlivé kategorie má iterapeutický dopad, jak dokazuje tabulka 1.3.
1.6.2 TNM klasifikace mozkových nádorů
Mozkové nádory se nešíří mimo CNS, takže TNM klasifikace definuje pouze velikostT, nikolivMaN, jako uostatních nádorů. Definici jednotlivýchTuvádí tabulka 1.2. Implantační metastázy vlikvorových cestách včetně páteřního kanálu, tedy pouze vrámci CNS, tvoří zejména germinom (nejčastější nádor pineální krajiny), pinealokarcinom ameduloblastom.
1.7Obecné zásady léčby
Léčba maligních nádorů mozku je vždy komplexní azahrnuje radikální operaci, po níž následuje aktinoterapie apřípadně chemoterapie. Kombinace léčebných modalit souvisí sWHO stupněm malignity, jak uvádí tabulka 1.3.
1.7.1 Chirurgická lé
čba
Chirurgická léčba má tři základní cíle:
• získat definitivní, histologickou diagnózu (stereotaktická biopsie, otevřená biopsie);
• redukcí tumorózní tkáně dosáhnout snížení nitrolebního tlaku;
• redukcí tumorózní tkáně zlepšit účinnost dalších léčebných modalit;
• vněkterých případech je cílem totální resekce tumoru.
Po operaci obvykle následuje kontrolní MR či CT svyhodnocením radikálnosti resekce. Cílem neurochirurgické léčby je provedení totální resekce tumoru. Ucentrálně uložených tumorů to často nebývá možné, takže vtěchto případech je vhodná alespoň částečná resekce. Zmenší se tím objem azlepší tak podmínky pro další léčebné kroky, neboť radioterapie achemoterapie mohou zprvu způsobovat edém atím zhoršovat nitrolební hypertenzi. Izolované, dobře ohraničené procesy ve funkčně němé oblasti jsou indikací pro kompletní resekci. Avšak ani vtéto oblasti nelze provádět resekci do zdravé tkáně jako ujiných orgánů, takže operační resekce tumoru ani vtěchto případech nebývá kurativní.
Neurochirurgicky se řeší nejen primární mozkové tumory, ale isolitární metastázy karcinomů vpřípadě, že primární tumor byl odstraněn anejsou informace ometastázách vjiných lokalizacích. Častý je iopačný postup. Nejdříve je operace mozkové metastázy, její histologické vyšetření anásledně operace primárního ložiska. Přežití utěchto pacientů může být iněkolik let.
Mezi metody neurochirurgické léčby patří také akutní operační řešení mozkové hypertenze (například zavedením ventrikuloperitoneálního shuntu), obzvláště uprocesů voblasti čtverohrbolí.
1.7.2 Radioterapie
Přínos radioterapie pro prodloužení života pacientů postižených maligním nádorem mozku je nesporný. Radioterapie proto pravidelně následuje po operaci. Používá se dávka 50–60 Gy /5 až 6 týdnů. Kradioterapii bývá používán kobaltový zářič (gama záření) nebo lineární urychlovač (brzdné záření X). Vpodstatě se používají tři druhy ozařovacích technik. • Cílená radioterapie na oblast tumoru (tedy ne na celý mozek). Tento typ se používá uvysoce maligních gliomů, kraniofaryngeomů aependymo-
Tabulka 1.1 Zkrácená verze histologické klasifikace WHO primárních nádorů CNS
Tumor benignísemibenignísemimalignímaligní
Astrocytární tumory
• astrocytomajeho variantyx
• anaplastický astrocytomx
• glioblastom ajeho varianty x
• subependymální obrovskobuněčný astrocytom x
Oligodendrogliové tumory
• oligodendrogliomx
• anaplastický (maligní) oligodendrogliomx
Ependymální tumory
• ependymomajeho variantyx
• anaplastický,maligní ependymomx
• myxopapilární ependymomx
• subependymomx
Smíšené gliomy
• oligoastrocytomx
• anaplastický (maligní) oligoastrocytomx
Tumor chorioidálního plexu
• plexuspapilomx
• plexuskarcinomx
Neuroepiteliální tumory nejasného původu
• astroblastom x x
• polární spongioblastom variabilní
• gliomatosis cerebri x x
Neuronální aneurono-gliové smíšené tumory
• gangliocytom, centrální neurocytomx
• gangliogliomxx
• anaplastický gangliogliomx
Tumory epifýzy
• pinealocytomx
• pinealoblastom x
Embryonální tumory
• meduloepiteliom x
• neuroblastom x
• ependymoblastom x
• primitivní neuroektodermální tumory meduloblastom, medulomyoblastomx
Tumory kraniálních nervů
• Schwannomx
• neurofibromx
Tumory mening-meningeom
• benigní variantax
• papilární meningeomx
• anaplastický meningeomx
Mezenchymové, nikoliv menigeální tumory
• benigní neoplazie x
• maligní neoplazie (maligní fibrózní histiocytom ajiné) x
Maligní melanocytická ložiska x x
Primární cerebrální lymfomy x
Germinální nádory ze zárodečných tkání x x x
Maligní nádory mozku 19
Tabulka 1.2 TNM klasifikace maligních CNS
T1supratentoriálně – nádor ≤ 5 cm, ohraničen na jednu stranu mozku
infratentoriálně – nádor ≤ 3 cm, ohraničen na jednu stranu mozku
T2supratentoriálně – nádor > 5 cm, ohraničen na jednu stranu mozku
infratentoriálně – nádor > 3 cm, ohraničen na jednu stranu mozku
T3nádor infiltruje komorový systém
T4supratentoriálně – nádor překračuje střední čáru mozku, infiltruje kontralaterální hemisféru nebo se propaguje infratentoriálně infratentoriálně – nádor překračuje střední linii, infiltruje kontralaterálně
Tabulka 1.3 Obecné principy léčby primárních nádorů CNS
WHO Terapie stupně malignity
I Operace scílem totálního odstranění ložiska, jen výjimečně radioterapie, žádná chemoterapie.
II Operace stotálním nebo subtotálním odstraněním ložiska. Ozáření může následovat ihned po operaci, nebo odloženě až při progresi tumoru. Chemoterapie má malou účinnost, je možno ji zvážit po vyčerpání možností operačního aradioterapeutického řešení.
III aIVPrimárně multimodální léčba obsahující operaci, pooperační radioterapii avněkterých případech iadjuvantní chemoterapii. Výjimkou je lokální germinom, kde je radioterapie kurativní.
mů bez spojení slikvorovými prostory.Podle doporučení NCCN 2003 se radioterapie cílí na oblast vykazující abnormality vT2 váženém MR zobrazení + 1–2cm bezpečnostního okraje. Za minimální dávku pro cílené ozáření se považuje 50–60 Gy. Vpřípadě postižení likvorových prostor (cerebrospinální diseminace) se ozařuje imícha dávkou 24–36 Gy.
• Radioterapie na oblast celého neurokrania. Tento způsob se používá preventivně uněkterých maligních chorob (akutní lymfatická leukemie, případně malobuněčný bronchogenní karcinom), nebo kurativně uprimárních lymfomů CNS.
• Radioterapie na veškerý likvorový prostor, tedy ina páteř. Tento způsob se používá umeduloblastomů aependymomů souvisejících slikvorovými cestami auzárodečných germinomů.
• Leksellův gama nůž, neboli multifokální gama-záření cílené do jedné oblasti, vhodný pro ozáření mozkových metastáz. Zde jenom stručně tuto metodu připomeneme apodrobnosti jsou pak uvedeny vzávěru textu. (V ČR je jediné zařízení toho druhu umístěno na oddělení stereotaktické aradiační neurochirurgie Nemocnice Na Homolce vPraze). Gama nožem jsou ošetřováni pacienti smaximálně 3–4 metastázami prokázanými na MR mozku. CT mozku není pro indikaci stereotaktické radiochirurgie dostatečné. Maximální velikost metastázy je do 2,5–3cm. Pacient musí
být vcelkově dobrém stavu. Metastázy také do jiných orgánů nejsou kontraindikací výkonu, ale pacient by měl mít prognózu několik měsíců
Výkon je proveden většinou za velmi krátké hospitalizace. Po výkonu je pokračováno nebo je zahájena antiedematózní terapie kortikosteroidy. Jejich dlouhodobé podání pak závisí na vývoji klinického stavu pacienta.
1.7.3 Chemoterapie
Chemoterapeutickou léčbu tumorů CNS lze rozdělit na intratékální anitrožilní aplikaci.
Intratékální aplikace je indikována jen při procesech postihujících likvorové cesty. Aplikace cytostatika je možná opakovanými lumbálními punkcemi nebo metodou implantovaného Ommaya rezervoáru. Diseminace na meningy ado likvorových cest však není uprimárních CNS tumorů běžná, snad pouze maligní gliomy ji způsobují v6 %, častější je uvysoce maligních lymfoproliferativních chorob.
Účinnost nitrožilní chemoterapie je vpřípadě primárních nádorů CNS limitována jejich chemosenzitivitou aprůnikem cytostatik přes hematoencefalickou bariéru. Proniká jich pouze několik málo vúčinné koncentraci (BCNU (carmustin),CCNU (lomustin), procarbazin, teniposid ametotrexát při vysokých dávkách aznovějších léků temozolomid a topotecan).
20
Diagnostické a léčebné postupy u maligních chorob
Chemoterapie má jen paliativní potenciál, nikoliv kurativní, aproto ji lze indikovat jen upacientů vdobrém celkovém stavu sKarnofskyho indexem nad 60 %. Úlohu chemoterapie při léčbě některých nádorů ilustruje tabulka 1.4.
1.8Koncepty léčby jednotlivých histologických typů mozkových tumorů
Udospělých pacientů jsou nejčastější první dvě skupiny primárních mozkových tumorů (1.8.1 a1.8.2). Meduloblastom (1.8.3) je doménou pediatrie. Další typy jsou vzácnější, vyskytují se jak udětí, tak udospělých.
1.8.1 Maligní gliomy (anaplastické astrocytomy aanaplastické oligodendrogliomy)
Malignígliomyjsouoznačoványjakoembryonální nádory,neboť vznikajízmezodermuneboznízce diferencovanétkáně.Anaplastickéastrocytomy (gradeIII)aglioblastomamultiforme(gradeIV) jsounejčastějšímitumorydospělých,vrcholjejich incidenceje45–55let.Anaplastickéoligodendrogliomyaoligoastrocytomyjsouponěkudméněčasté.Pokudbuňkyneuroglienelzediferencovat anelzediferencovatanimezenchym,mluvíme ogliosarkomu.
V90 %případů jsou tyto nádory lokalizovány vbílé hmotě hemisfér (nejčastěji čelního nebo spánkového laloku). Často prorůstají do sousedních laloků nebo bazálních ganglií. Všechny maligní gliomy se vyznačují velmi rychlým růstem. Tyto tumory jsou charakterizovány cévními proliferacemi sarteriovenózními zkraty, trombózami, krvácením acentrální nekrózou uvnitř nádoru (glioblastoma
multiforme).Nádorové buňky jsou pravidelně nalézány voblasti peritumorózního edému, která odpovídá abnormalitám vT2 váženém MR obraze. Proto se záření plánuje vždy na tento objem.
Léčba
Léčba všech maligních gliomů spočívá voperačním zákroku, který odstraněním části či celého tumoru zmenší nitrolební tlak. Recidiva maligního gliomu je však nevyhnutelná ipři makroskopicky totální exstirpaci ložiska. Medián přežití pacientů po operaci bez další léčby je 4 až 6 měsíců. Radioterapie prodlouží medián přežití na 8 až 10 měsíců, nezabrání vzniku lokální recidivy, avšak zpomalí průběh choroby. Radioterapie je tedy dle doporuč ení NCCN 2003 standardní léčbou pro nemocné s high grade astrocytomy, ato jak vpřípadě kompletní resekce, tak vpřípadě pouhého odběru biopsie.
Pacienti léčení pouze operačně dosahovali jen ve 3 %jednoročního přežití, přidání chemoterapie (BCNU) zvýšilo počet pacientů přežívajících rok po operaci na 12 %, při použití pooperační radioterapie se dosahuje ročního přežití u24 %pacientů (dle NCCN 2003).
Chemoterapie má potenciál zpomalit růst těchto maligních gliomů. Adjuvantní chemoterapie po operaci apo ozáření prodlouží dobu přežití vprůměru odalších 8 až 12 týdnů apočet pacientů přežívajících 18 měsíců zvýší z0–5 %na 20–30 %.
Doporučení NCCN 2003 uvádí, že vpřípadě glioblastoma multiforme má chemoterapie jenom marginální účinek, přínosem však může být pro mladší nemocné sanaplastickým astrocytomem. Adjuvantní chemoterapie však nevede kvyléčení ani vmalé podskupin ě nemocných. Novou modalitou je peroperační vložení biodegradabilního polymeru sBCNU. Tento postup byl již schválen FDA. Vrámci standardní chemoterapie se používá monoterapie sBCNU, nebo kombinace prokarbazinu, CCNU avinkristinu (PCV) nebo temozolomid.
Tabulka 1.4 Obecné doporučení pro chemoterapii maligních mozkových nádorů v závislost na celkovém stavu nemocného (Müller, 2003)
Maligní gliomy WHO III a IV (také gangliomy, ependymomy, plexuspapilomy)
Karnofsky Žádná adjuvantní chemoterapie, při progresi monoterapie ACNU (nitrosourea), pokud není pod 50 %účinná, tak chemoterapii ukončit
Karnofsky Adjuvantní chemoterapie s BCNU, ACNU, při progresi změnit na prokarbazin nebo
50–60 %polychemoterapii, například BCNU+VM-26 či nové experimentální léky
Karnofsky Adjuvantní polychemoterapie s ACNU+VM 26, při progresi alternativní schémata (temozolomid).
> 70%Při další progresi je možné testovat léky 2. volby, cisplatinu, vyšší dávky cytosinarabinosidu
1.8.2 Astrocytomyaoligodendrogliomy nízkého stupně malignity
Pomalu rostoucí astrocytomy (grade II) mají, ipřes dobré ohraničení na CT či MR zobrazení, tendence kdifuzní infiltraci okolních struktur. Při jejich růstu dochází často kdediferenciaci na agresivnější formy. Nejvyšší incidenci mají tyto tumory kolem 37. roku života. Po radikální operaci se5 let dožívá 52 % a10let 23 % operovaných.
Léčba
Utěchtotumorů sedoporučujepokusitsevždy okompletníresekce,kterémohouvéstkněkolikaletémubezpříznakovémuobdobí.Rozsahprovedenéresekcejenutnéověřit časně pooperacikontrolnímMRvyšetřením.
Po subtotální exstirpaci astrocytomu se za vhodné považuje ozáření ložiska, neboť radioterapie dle některých studií zvýšila počet pacientů přežívajících 5let po operaci z20 % (jen operace) na 40 až 45 % při kombinované léčbě. NCCN 2003 doporučuje 54 Gy ve frakci pol,8 Gy, obvykle následně po operaci.
Vpřípadně kompletní resekce umladších osob je možné odložit radioterapii až do doby recidivy či progrese tumoru. Uosob nad 45 let po kompletní resekci se odporučuje neodkládat ozáření, neboť nádory se chovají agresivněji než umladších osob. Ozařovací pole zahrnuje oblast abnormalit vT2 váženém MR obraze s2cm bezpečnostním okrajem.
Vpřípadě recidivy je na zvážení reoperace, je-li možná, případě radioterapie, pokud ale již nebyla dříve použita.
Chemoterapie není u „low grade“ astrocytomů indikována. Při recidivě je vždy na místě zvážení reoperace.
1.8.3 Meduloblastom
MeduloblastomsdalšímiprimitivnímineuroektodermálnímitumoryCNSpatříknejzhoubnějšímnádorůmdětskéhověku.Poleukemiíchjedruhýmnejčastějšímmalignímonemocněním.Nejčastěji vyrůstázdolní částivermis,infiltrujepostupně celou IV.komoruaněkdyprorůstáidomozečkovýchhemisfér.Infiltrujeměkképlenyametastazujevlikvorovémprostoruvšemisměry,zejménavšakdoprostorupáteřníhokanálu.Pooperacibrzyrecidivuje, aprotocílemoperacejezjistithistologickoudiagnózuazmenšitmasutumoru,anižbydošlokvětšímu poškozenínervovýchstruktur,vizobr.1.6.

1.6 Meduloblastom, v oblasti IV. komory v zadní jámě se může šířit implantačními metastázami vlikvorovém prostoru jak v intrakraniální oblasti, tak i na úrovni pateřního kanálu, viz šipky.
Léčba
Zásadní léčebnou modalitou je zde radioterapie na celý CNS apáteřní kanál. Tato léčba dosahuje 5 a10leté přežití u60–70 %dospělých a40–60 % dětí. Přidání chemoterapie koperační aradiační léčbě už dále výsledky nezlepšuje.
Nádory CNS udětí tvoří více než 20 %všech maligních onemocnění apředstavují tak po leukemiích druhou nejčastější skupinu nádorových onemocnění. V ČR to znamená kolem 80 nových nádor ů CNS ro č n ě . V ě tšina d ě tských mozkových nádorů je lokalizována infratentoriálně. Problematika dětských nádorů CNS je podrobněji řešena vpediatrické kapitole.
1.8.4 Germinom-nádor ze zárodečných tkání
Germinomy jsou vzácné tumory CNS (2 %), nejčastěji jsou lokalizovány vpineální krajině
Histologicky odpovídají germinálním nádorům varlat aovarií. Vmozku vyrůstají ze zadní stěny III. komory, jsou maligní. Prorůstají do hypotalamu,
Obr.
Diagnostické a léčebné postupy u maligních chorob
corpus callosum ado čtverohrbolí, metastazují všemi směry vlikvorové soustavě. Postupně utlačují mokovod azpůsobují hydrocefalus.
Léčba
Zásadní modalitou jejich léčby je radioterapie, kterou lze dosáhnout 5letého bezpříznakového přežití u90 % pacientů. Obvykle se ozařuje celý likvorový prostor celkovou dávkou 24 adalších 16 Gy se aplikuje na ložisko tumoru. Pro pacienty srecidivou se používá chemoterapie.
1.8.5 Ependymom
Ependymomy se nejčastěji vyskytují vprvních dvou dekádách, postihují však idospělé. Obvykle odpovídají WHO stupni malignity II, ale mohou být jak semimaligní, tak anaplastické formy. Udětí postihují ve dvou třetinách infratentoriální oblasti, udospělých je tomu naopak. Supratentoriální lokalizace znamená vždy horší prognózu.
Léčba
Kompletní resekce se utohoto typu nádorů zdaří jen výjimečně. Způsob radioterapie se odvíjí od lokalizace astupně malignity.
Doporučení NCCN pro dospělé zroku 2003 zohledňuje jak histologický grade, tak pooperační MR mozku amíchy. Pacienti, unichž se podařilo radikální odstranění dobře diferencovaného tumoru apooperační kontrolní MR mozku amíchy neprokazuje další ložiska, obvykle podstupují pouze cílenou radioterapii na oblast tumoru, byť radioterapie vtěchto případech není obligátní apouhé sledování je rovnocennou volbou. Vpřípadně postižení míchy je však indikováno kraniospinální ozáření.
Upacientů po odstranění anaplastického ependymomu se postupuje dle výsledku pooperačního MR zobrazení mozku amíchy. Pokud MR míchy je negativní, následuje pouze cílené ozáření na oblast ložiska. Vpřípadě pozitivního MR je indikováno kraniospinální ozáření.
Vpřípadě recidivy se vždy zvažuje paliativní operační výkon avpřípadech, kdy mozek nebyl dříve ozařován, se použije ozáření pro léčbu relapsu.
Starší doporučení, které uvádí Müller 2003 odvozuje léčbu od histologického gradingu. Udětí se supratentoriálními low grade tumory ozařují cíleně na ložisko, stejně jako supratentoriální high grade bez souvislosti slikvorovými prostorami, zatímco pro všechny infratentoriální a high grade supraten-
toriální ependymomy související slikvorovými prostorami se používá cerebrospinální ozáření.
Udospělých doporučuje Müller (2003) stejnou léčbou jako pro ostatní maligní gliové nádory. Vpřípadě souvislosti slikvorovými prostorami podání cytostatik intratékálně. Při intratentoriální lokalizaci cerebrospinální radioterapii.
Po samostatné operaci přežívá až 30 %mladých pacientů se semibenigním epedymomem 5 let. Po operaci anásledné radioterapii přežívá 5 let 70 %pacientů sependymomy nízké malignity a30 %pacientů sanaplastickými ependymomy.
Pozitivní přínos chemoterapie nebyl uependymomů doložen, proto chemoterapie zde není indikována.
1.8.6 Anaplastický meningeom
Meningeom může být jak benigní, tak maligní. Maligní anaplastický meningeom je mezodermálního původu, vyrůstá zmozkových plen (hlavně zgranulationes arachnoideales), tvoří 7 %všech meningeomů apostihuje nemocné nad 50 let. Vyznačuje se rychlým invazivním růstem do mozkové tkáně. Po radikální operaci vyžaduje komplexní léčbu radioterapií achemoterapií.
1.8.7 Infiltrace mening maligními buňkami
Objeví-li se upacientů se zjištěným solidním tumorem nebo hematologickým onemocněním neurologické příznaky, je nutno myslet na infiltraci mozkových plen maligními buňkami nebo ložiskovou metastázu. Dále uvedeme informace oinfiltraci mening, metastázy jednotlivých nádorů jsou probírány vrámci jednotlivých histologických entit.
Někdy se vlikvoru zpočátku zjistí jen zvýšená koncentrace bílkovin se sníženou glukózou apleiocytózou. Patologický cytologický nález je zjištěn až později.
Pokud je infiltrace mening na podkladě hematologického onemocnění, je potenciálně kurabilní, opak však platí pro solidní tumory. Neoplastická meningitida se objevuje asi jen u5 % nemocných skarcinomy, nejčastěji vzniká při generalizaci karcinomu prsu, plic amelanomu. Pacienti sneoplastickou meningitidou umírají bez léčby průměrně za 4–6 týdnů.
Není-li indikována pouze symptomatická léčba, připadá vúvahu intratékální aplikace cytostatik. Výhodnější je intraventrikulární aplikace cytostatik přes chirurgicky zvedený Ommaya rezervoár, neboť apli-
kace cytostatik cestou lumbálních punkcí často nedosahuje potřebných terapeutických koncentrací. Lékem volny je metotrexát vdávce 10–12mg 2x týdně podávaný po 4–8 týdnů aposléze při léčebném úspěchu jako udržovací léčba vtýdenních intervalech. Vpřípadech maligních lymfoproliferativních chorob infiltrujících CNS se používá cytosinarabinosid. Alternativou je nitrožilní podávání vysokých dávek metotrexátu, které dosahují dostatečné hladiny vlikvoru. Za vhodné se považuje vyšetřit průchodnost likvorových prostor metodou cerebrospinal fluid flow scan. Vpřípadě prokázaných obstrukcí touto metodou, nebo při prokázání ložiska maligních buněk zobrazením mozku amíchy metodou MR se jednoznačně doporučuje radioterapie na tuto oblast. Vpřípadě,že zářením nezprůchodní likvorové prostory, není vhodné pokračovat vintratékální aplikace cytostatik adoporučuje se pouze podpůrná léčba.
Tato léčba má potenciál prodloužit přežití na 3–6 měsíců a často umožňuje dobrou lokální kontrolu.
1.9
Speciální podpůrná léčba mozkových tumorů
1.9.1 Epileptické záchvaty
Přibližně jedna čtvrtina tumorů se ohlašuje epileptickými záchvaty. Utěchto pacientů je nutná antiepileptická léčba. Avšak na druhé straně profylaktické podávání antiepileptik všem pacientům se ukázalo jako neopodstatněné apro ně nevýhodné. Téměř všechna antiepileptika mají negativní dopad na kognitivní funkce, které jsou již narušené operací azářením. Současné ozařování, obzvláště při podávání nízkých dávek steroidů, zvyšuje riziko fenytoinem (méně často karbamazepinem) indukovaného erythema multiforme. Proto se antiepileptika nemají podávat profylakticky, ale pouze terapeuticky, má-li pacient epileptické záchvaty.
1.9.2
Nitrolební hypertenze
Krátkodobě pomohou kortikosteroidy ve vysokých dávkách 100–500mg prednisonu/den nebo infuze nemetabolizovatelného cukru manitolu. Vpřípadě manitolu se nesmí zapomenout na to, že antiedematózní účinek se dostaví jedině při rychlém podání infuze, asi během 30 minut, kdy prudší vzestup kon-
centrace manitolu vkrvi zvýší osmolaritu krve. Ta vlastně způsobí odsátí edému zCNS. Pomalá infuze manitolu nemá antiedematózní účinek, má pouze účinek diuretický (osmotické diuretikum).
Pro dlouhodobou léčbu jsou však oba uvedené postupy nevhodné. Dlouhodobě lze antiedematózní lé č bu zajistit perorálním podáváním glycerolu vdávce 4x denně 50ml 85% roztoku. Tato léčba působí antiedematózně na stejném principu jako manitol. Kortikosteroidy se podávají dlouhodobě vnižších dávkách, obvykle 4–8mg dexametazonu nebo 20–40mg prednisonu denně
Při akutním zvýšení mozkomíšního tlaku se zmenšuje perfuze mozku. Zvýšení arteriálního tlaku vtěchto případech představuje fyziologickou protiregulaci. Proto je nutno opatrně snižovat hypertenzi. Pokud se ktéto léčbě přikročí, tak nelze používat diuretickou léčbu, která vede ke zvýšení hematokritu azhoršuje perfuzi.
1.9.3 Hydrocefalus
Hydrocefalus vzniká poruchou komunikace mezi likvorovými prostorami. Může být způsoben jak subependymálním šířením tumoru, tak nádorovou infiltrací mening (meningeosis neoplastica). Jedná-li se oinfiltraci mening senzitivní na cytostatika azáření, dojde po radioterapii achemoterapii rovněž kústupu hydrocefalu. Vostatních případech při narůstajícím hydrocefalu je indikována neurochirurgická operace – zavedení shuntu.
1.9.4 Bolesti
Bolesti hlavy nejsou obligátním průvodcem mozkových nádorů. Pokud jsou způsobeny zvýšeným likvorovým tlakem, reagují dobře na antiedematózní léčbu, lépe než na analgetika.
Prudké bolesti může způsobit meningeosis neoplastica infiltrací senzitivních mening sprůvodní zánětlivou reakcí. Vtěchto případech jsou indikována antiflogistická analgetika. Velmi dobrý paliativní efekt může mít intratékální injekce triamcinolonu krystalické suspenze (10–80mg).
1.10 Prognóza
Vsoučasné době dlouhodobě účinná léčba umultiformního glioblastomu aanaplastického astrocytomu neexistuje. Průměrná doba přežití je 5 až 12 měsíců.
Diagnostické a léčebné postupy u maligních chorob
Při komplexní léčbě meduloblastomu se dosahuje pětiletého přežití v50 %.
Komplexní léčba maligního meningeomu umožní 50 %pacientů pětileté přežití.
1.11
Indikace radiochirurgické
léčby pomocí Leksellova gama nože
uintrakraniálních nádorů
Radiochirurgie je způsob stereotaktické neurochirurgické operace, při které je dosaženo žádoucího biologického efektu vmalém cílovém objemu intrakraniální tkáně aplikací jedné dávky fokusovaného záření ze zevních zdrojů. Vpřípadě gama nože vzniká fotonové gama záření rozpadem isotopu kobaltu – 60Co. Toto záření je kolimováno do úzkých svazků paprsků, kterých je 201 aty se kříží ve společném ohnisku. Do tohoto ohniska je po stereotaktické lokalizaci umístěn cíl, vekterém má vzniknout ohraničená léze. Ta vznikne působením vysoké radiační dávky, ke které přispívají všechny křížící se paprsky. Mimo toto ohnisko dávka do okolí strmě klesá ajiž vmalé několikamilimetrové vzdálenosti od ohniska odpovídá dávka prakticky jednotlivému paprsku. Radiochirurgická léčba je spojena snulovou akutní morbiditou amortalitou amalou pozdní morbiditou, která obvykle není vyšší než 3% aje způsobena poradiační kolaterální edémovou reakcí. Na rozdíl od mikrochirurgie není výsledkem radiochirurgické léčby prázdné místo na kontrolním zobrazovacím vyšetření vmístě původního nádoru. Nádor na svém místě stále přetrvává, ale nepokračuje vrůstu anezvětšuje svůj objem, případně lze pozorovat regresivní změny ajeho zmenšování. Rozdílnost radiochirurgie aradioterapie se odvíjejí ze skutečnosti, že radiochirurgie představuje jednorázové fokusované ozáření aplikované cíleně do chorobného ložiska sprudkým poklesem dávky do okolní zdravé tkáně, zatímco radioterapie aplikuje radiační dávku vmnoha frakcích ado většího objemu, vekterém se nachází kromě chorobného ložiska také významnější objem okolní normální tkáně
Radiační dávka aplikovaná jednorázově navozuje signifikantně větší radiobiologický efekt, než stejná dávka aplikovaná vmnoha frakcích. Limitem pro radiochirurgii je objem samotného chorobného ložiska aorientačně lze říci, že pro jednorázové foku-
sované ozáření jsou vhodné chorobné procesy do průměru 3cm.
Benigní nádory
Dobrá ohraničenost azobrazitelnost benigních nádorů je činí ideálním cílem pro radiochirurgickou léčbu gama nožem. Jediným omezením je velikost nádoru, orientačně do 3cm vprůměru, ajejich lokalizace. Vzhledem ktechnickému řešení přístroje nelze léčit nádory uložené pod úrovní foramen magnum. Ujednotlivých histologických typů je nutné posoudit také vztah nádoru knaléhajícím, funkčně významným strukturám. Vzhledem kepidemiologickém výskytu jsou nejčastější 3 histologické typy – meningeomy, vestibulární schwannomy (neurinomy akustiku) aadenomy hypofýzy. Zostatních relativně častějších typů jsou kléčbě gama nožem indikovány chemodektomy (nádory glomus jugulare), kraniofaryngeomy, neurinomy ostatních hlavových nervů achordomy.
Vhodnou indikací kradiochirurgické léčbě jsou zejména nádory voblasti báze lební ato zněkolika důvodů. Jednak je jejich mikrochirurgické odstranění často nemožné anebo spojeno srizikem mutilujících pooperačních následků. Pro radioterapii jsou to pak nádory často radiorezistentní. Nicméně mikrochirurgii, radiochirurgii aradioterapii nelze chápat jako metody, které si konkurují, protože zvláště vtak komplikované lokalizaci, jako báze lební je léčba často multidisciplinární atyto metody se musí často vzájemně kombinovat.
Meningeomy
Incidence meningeomů stoupá svěkem aneinvazivní radiochirurgie je vítanou léčbu ustarších a často interně nemocných pacientů. Nicméně, ne všichni pacienti snáhodně zjištěným meningeomem musí nutně podstoupit aktivní léčbu. Ustarších nemocných (vzávislosti na biologickém věku) snáhodným nálezem meningeomu, kde meningeom je kalcifikovaný, mozek atrofický, lze pacienta pouze dispenzarizovat aradiochirurgickou léčbu indikovat pouze vpřípadě prokázaného růstu nádoru na opakovaném zobrazovacím vyšetření.
Meningeomy lokalizované na bázi lební tvoří polovinu radiochirurgicky léčených nemocných stouto diagnózou. Vpřípadě otevřené neurochirurgické resekce, pokud má být provedena radikálně, představuje tato lokalizace pro pacienta nemalé riziko operační mortality apooperačního zhoršení kvality života. Typicky obtížnou lokalizací pro otevřený výkon je ka-
vernózní splav. Vtakovém případě by měla být radiochirurgická léčba zvažována jako primární způsob léčby také umladších ainterně nezatížených nemocných. Jako kontraindikace kradiochirurgické léčbě je uváděn intimní vztah meningeomu koptickému traktu. Ikdyž je to závažná okolnost, nelze ji považovat za absolutní kontraindikaci. Dobré léčebné výsledky bez přidružené morbidity lze docílit pomocí gama nože také vpřípadě, kdy je přítomna komprese optického traktu meningeomem. Naproti tomu, meningeomy lokalizované na konvexitě si při indikaci radiochirurgické léčby zasluhují obezřetnější přístup. Důvodem je riziko vzniku poradiačního edému, který může být někdy pozorován, ikdyž byla aplikovaná relativně nízká radiační dávka. Riziko poradiačního edému je umeningeomu báze lební zcela výjimečné, což lze vysvětlit tím, že jejich okraj zvětší části není vkontaktu snaléhající mozkovou tkání, ale bazálními cisternami. Ukonvexitárních meningeomů může být naopak kontakt nádorové tkáně smozkovou kůrou intimnější, než se obecně předpokládá. Proto na rozdíl od meningeomů báze lební by měla být pacientům skonvexitárním meningeomem nabídnuta přednostně otevřená operace aradiochirurgická pouze vpřípadě interní kontraindikace anebo vyhraněně negativním postoji nemocného kotevřené operaci.
Adenom hypofýzy
Radiochirurgická léčba adenomu hypofýzy má tyto cíle: zastavit růst adenomu, normalizovat případnou hormonální hypersekreci azachovat funkci normální hypofyzární tkáně astruktur vokolí tureckého sedla. Mozkový kmen je většinou vdostatečné vzdálenosti od okraje adenomu aokulomotorické nervy probíhající kavernózním splavem jsou značně radiorezistentní, takže nejsou pro léčbu gama nožem limitujícím faktorem. Nejdůležitější strukturou, od které se indikace radiochirurgické léčby odvozuje, je optický trakt, protože dávka na něj by neměla přesáhnout 8 Gy. Protože dávka potřebná na zastavení růstu adenomu je nižší, než dávka potřebná na potlačení hormonální hypersekrece, jsou indikační kritéria pro afunkční adenomy méně přísná alze za určitých okolností kradiochirurgické léčbě akceptovat pacienty sadenomem, kde je intimnější kontakt se zrakovou dráhou, pokud takový kontakt je spíše bodový než plošný. Ufunkčních adenomů je potřebná vzdálenost okraje adenomu od optické dráhy alespoň 2mm, aby okrajová účinná dávka na adenom mohla směrem koptiku klesnout na tolerovaných 8 Gy.
Dříve uváděná bezpečná vzdálenost 5mm mohla být díky zdokonalené zobrazovací aozařovací technice víc jak dvojnásobně snížena.
Zatímco ujiných typů benigních nádorů se radiochirurgická léčba indikuje primárně udvou třetin nemocných atřetina podstoupí předchozí otevřenou operaci, uadenomu hypofýzy je tento poměr obrácený.
Vsoučasné době je radiochirurgická léčba adenomu hypofýzy indikovaná většinou jako adjuvantní terapie reziduálního nebo recidivujícího adenomu po předchozí mikrochirurgické operaci. Uvybraných pacientů může být léčba gama nožem zvolena jako primární způsob neurochirurgické operace, například upacientů kontraindikovaných kcelkové anestezii, upacientů kde není naléhavé rychlé dosažení normálních hormonálních hladin aupacientů, kteří se kotevřené operaci staví zamítavě.
Vestibulární schwannom
Pacientsvestibulárnímschwannomemmámožnost výběruzedvousrovnatelně účinnýchléčebných možností–neurochirurgickéoperacearadiochirurgickéléčbygamanožem.Upacientů svelkýmneurinomemakustiku,kterýzpůsobujetlaknamozkovýkmen,jenutnépřistoupitkotevřenéoperaci, protožezastavenírůstunádorujižnestačíajepotřebnéuvolnitjehotlak.Tatosituacenastáváuneurinomusprůměremnad3cm.Upacientů sinternímonemocněním,které činíotevřenouoperační zátěžpřílišrizikovou(např.poinfarktumyokardu, těžkácukrovkaapod.)jeuneurinomusprůměrem méně než3cmjednoznačně vhodnějšíléčbagama nožem.Uvšechostatníchpacientů jemožnývýběr meziotevřenouoperacíaléčbougamanožem.Některýmpacientůmajejichošetřujícímlékařůmvíce vyhovujeráznéskoncovánísnádorempomocíneurochirurgickéoperaceizacenuvětšíhorizika.Jiní dajíp ř ednostnezat ě žujícílé č b ě gamanožem, ikdyžvědí,ženádorjimzhlavynezmizí,pouze přestanerůstanebudetakdobudoucnaproně představovatžádnéohrožení.Přirozhodováníozpůsobuléčbybymělpacientvprvní řadě vědět,jakých léčebnýchvýsledků dosahujepracoviště,kterému sechcesvěřitdopéče.Tutoinformacilzezískatnapříkladnainternetovýchstránkáchpříslušných zdravotnickýchzařízeníarenomovanápracoviště svévýsledkypublikujív časopisech.Pacient,který sechcespolupodíletnarozhodováníozpůsobusvé léčby,můžezjistitstanoviskoneurochirurgakvyhlídkámmikrochirurgickéoperaceastanoviskora-
Diagnostické a léčebné postupy u maligních chorob
diochirurgakmožnostiléčenígamanožemtaké osobníkonzultací.Pozváženíoboustanovisekse můžepotomrozhodnout,kterýléčebnýpostupsi zvolí.Umalýchvestibulárníchschwannomů se dnesvětšinapacientů léčípomocígamanože,protožeúspěšnostléčbydosahuje95%,rizikopoškozenífunkcelícníhonervunepřesahuje1–2%aužitečnýsluchjezachovánasiu80%nemocných.
Maligní nádory
Nejdůležitější uplatnění radiochirurgie je vléčbě mozkových metastáz (svýjimkou malobuněčného karcinomu plic). Kléčbě gama nožem jsou vhodné metastázy do průměru 3cm, dalším limitem je jejich počet azpravidla pokud přesáhne počet metastáz vmozku 4, není již vhodné léčbu gama nožem provádět. Omezením pro indikace radiochirurgické léčby je také celkový stav nemocného, protože léčba mozkové metastázy upacienta vterminálním stadiu onemocnění již pro něj neznamená žádný přínos. Pacienti indikovaní kléčbě gama nožem by měli proto mít Karnofského skóre nad 50%. Role radiochirurgické léčby je umozkových metastáz podceněna. Radiochirurgie by měla nahradit otevřenou operaci vždy, když to objem nádoru umožní aotevřená resekce by měla být rezervovaná pro velké expanzivní léze. Mozková metastáza je totiž vždy projevem ge-
Literatura
neralizace primárního extrakraniálního nádoru ajejí léčba je jenom součástí komplexní onkologické léčby. Vpřípadě, že radiochirurgická léčba docílí stejného anebo lepšího výsledku než otevřená operace, měla by být preferována zdůvodu její neinvazivnosti. Radiochirurgická léčba má ambulantní charakter akvalitu života neohrožuje. Naproti tomu otevřená operace představuje pro pacienta vždy větší zátěž asprávně by měla po ní následovat navíc frakcionovaná radioterapie, ato ivpřípadě radikální resekce metastázy. Utěchto pacientů, kteří vzhledem kznámkám generalizace primárního nádoru mají dobu přežívání limitovanou, měla by být volena léčba co nejméně zatěžující apřitom co nejefektivnější. Úspěšnost radiochirurgické léčby umozkových metastáz přesahuje 90% amorbidita nepřekračuje 5%.
Frakcionovaná radioterapie hraje svoji nezastupitelnou roli umnohočetné intracerebrální metastatické diseminace.
Uprimárních mozkových nádorů je limitujícím faktorem pro radiochirurgickou léčbu kromě objemu nádoru také jeho infiltrativní povaha aproto se radiochirurgická léčba uplatňuje obvykle jako adjuvantní terapie po předchozí frakcionované radioterapii (boost dávka).
Rostoucí uplatnění radiochirurgie je vléčbě očních nádorů, zejména uveálních melanomů
CEJPEK, P.: Problémy po operacích zhoubných nádorů mozku. Onkolog. péče, 1999; 4: 1–2.
JUNG, V., ROMEIKE, B., HENN, W. ETAL.: Evidence of Focal Genetic Microheterogeneity in Glioblastoma Multiforme by Area-Specific CGH on Microdissected Tumor Cells. J. Neuropathol. Exp. Neurol., 58. 1999; 9: 993–999.
KALA,M.: Současné možnosti léčby mozkových metastáz. Čes. Slov. Neurol. Neurochir., 61/ 94, 1998; 1: 3–6.
KALA,M.: Maligní nádory mozku dospělého věku. I.Vyd. Galén: Praha, 1998. 111 s.
KUGLÍK, P., VÁCLAVÍK, P., OLTOVÁ, A. ETAL.: The Identification of Supernumerary Marker Chromosomes in Five Patiens by Fluorescent in situ Hybridization. Cytogenet. Cell Genet. 85. 1999; 39–41.
MLEJNEK, P., KUGLÍK, P.: Induction of Apoptosis in HL-60 Cells by N6–benzyladenosine. J. Cell Biochem., 77, 2000; 1: 6–17.
MOHAPATRA,G., BOLLEN, A., KIM. D. ETAL.: Genetic Analysis of Glioblastoma Multiforme Provides Evidence for Subgroups Within the Grade. Genes Chromosomes Cancer, 21, 1998; 195–206.
MÜLLER, B., BAMBERG, M., KRAUSENECK, P.: Maligne Gehirntumoren, s. 529–561. In.: SEEBER, S., SCHÜTTE, J.: Therapiekonzepte Onkologie. 4. vydání, Springer, Berlin, Heidelberg, 2003.
LEVIN, V., GUTIN, P., LEIBEL, S.: Neoplasm of the Central Nervous System, s.1679–1681. In.:
WILTSHIRE, R., RASHEED, A., FRIEDMAN, H. ETAL.: Comparative Genetic Patterns of Glioblastoma Multiforme: Potential Diagnostic Tool for Tumor Classification. Neuro-Oncology, 2000; 164–173.
2Maligní nádory hlavy akrku
2.1 Definice
Skupina nádorů hlavy akrku je definována anatomickou lokalizací. Patří sem nádory rtů, dutiny ústní, jazyka, dutiny nosní, paranazálních dutin, epifaryngu, orofaryngu, hypofaryngu, laryngu, slinných žláz anádory ušní. Jejich závažnost je dána lokalizací ve funkčně aesteticky exponované krajině. Často bývá vrůzném stupni postižena řeč, polykání adýchání – funkce mimořádně důležité pro sociální interakci, kvalitu života apřežití. Přes různou lokalizaci je jejich léčení principiálně stejné, proto vtéto kapitole nebudeme separátně popisovat léčení jednotlivých tumorů.
2.2 Epidemiologie
Maligní nádory hlavy akrku představují umužů asi 6 %, užen asi 2 %všech zhoubných nádorů. Rakovina nosohltanu se unás vyskytuje 2x, orofaryngu 6x, hypofaryngu 12x, laryngu 13x, nosu avedlejších dutin nosních 2x častěji umužů než užen. Umaligních nádorů slinných žláz jsou obě pohlaví postižena stejnou měrou. Incidence nejčastějších maligních nádorů hlavy akrku, rakoviny laryngu v ČR vroce 1994 byla 9,4/100 000 mužů a0,8/1000 000 žen. Výskyt částečně závisí na geografické poloze astoupá od severu kjihu. Nejnižší hodnoty výskytu maligních nádorů hlavy akrku byly zjištěny ve Švédsku (9/100 000 obyvatel), nejvyšší hodnoty výskytu byly zjištěny ve Francii, kde jsou tyto karcinomy stejně četné jako nádory plic (50/100 000 obyvatel).
2.3 Etiologické faktory
Výskyt nádorů hlavy akrku souvisí sexpozicí následujícím rizikovým faktorům:
•Alkohol anikotin, obzvláště pak jejich kombinace. Stou souvisí více než 80 %tumorů vdutině ústní avlaryngu.
•Nízká úroveň hygienických návyků (malhygiena dutiny ústní) anezodpovědný přístup kvlastnímu zdraví.
•Konzumace tabáku formou žvýkání má stejný potenciál indukovat nádory jako jeho kouření. Látky vznikající spalováním tabáku nebo při žvýkání tabáku jsou poměrně slabými kancerogeny, avšak délka jejich působení je považována za důležitější než jejich koncentrace.
•Kouření marihuany je ještě rizikovější než kouření tabáku, poněvadž marihuanový kouř obsahuje až o50 %vyšší koncentraci benzpyrenu.
•Dřevný prach (tanin) hraje určitou roli při vzniku adenokarcinomů dutiny nosní aparanazálních dutin podobně jako sloučeniny chromu aniklu.
•Virus HPV 16 a18 je spojován se vznikem karcinomu laryngu, virus herpes simplex 1 skarcinomem dutiny ústní.
•EB virus akonzumace slaných ryb jsou spojovány se vznikem nazofaryngeálního karcinomu, který se vyskytuje endemicky vAsii, zatímco vEvropě není častý. Epidemiologická vazba mezi karcinomem nosohltanu aEB virem je silnější než mezi karcinomem nosohltanu aslanými rybami.
•Ionizační záření indukuje vznik nádorů slinných žláz.
2.4 Příznaky nemoci
Maligní nádory hlavy akrku jsou záludné tím, že zůstávají dlouho bez příznaků, nebo připomínají často bagatelizovaná nezávažná chronická zánětlivá onemocnění.
Nádory nosu anosohltanu zhoršují nosní průchodnost, způsobují zvýšenou sekreci znosu aporuchu čichu. Varovat by měla jednostrannost příznaků, příměs krve vnosním sekretu anedostatečná odpověď na standardní léčbu. Zvláště nepříjemné jsou nádory paranazálních dutin – nádor uvnitř kostí pevně ohraničené dutiny roste velmi dlouho bez příznaků. Vpokročilejších stadiích se projevují podobně jako nádory no-
su, navíc bývá dislokace oka, zduření zevně vobličeji, bolesti hlavy, zápach znosu aparestezie.
Nádory dutiny ústní,orofarynguahypofaryngu způsobují bolest vkrku avústech, pocit cizího tělesa, krvácení, zápach zúst azduření na krku. Nádory této lokalizace jsou často vidět pouhým okem apak je hrubým zanedbáním, je-li nemocný spokročilým nádorem vyšetřen několika lékaři, aniž by někdo znich alespoň vyslovil podezření na nádor. Starší osoby se snímatelnou náhradou chrupu by měly být vyšetřovány bez této náhrady – nádor může být protézou zakryt. Rovněž by měla být vyšetřována spodina dutiny ústní – pod jazykem může být skryt pokročilý nádor, který se už projevil metastázou na krku. Ukaždého podezření na nádor kořene jazyka je nezbytně nutné vyšetřovat nemocné ipalpací kořene jazyka aspodiny dutiny ústní (bimanuální palpace).
Nádory hrtanu se liší příznaky dle primární lokalizace adle pokročilosti onemocnění. Vpočáteč-
ních stadiích karcinomu glottis je chrapot, ukarcinomu supraglottis bývá často pocit cizího tělesa apolykací potíže. Karcinom subglottis bývá dlouho bez příznaků. Vpokročilejších stadiích bývá příměs krve ve sputu, dýchací apolykací obtíže, bolest při polykání aexulcerace zevně na krku.
Nádory slinných žláz se projevují jako pozvolna rostoucí, zpočátku nebolestivé zduření. Bolestivost, urychlení růstu, obrna lícního nervu aparestezie mohou být již projevem maligního zvratu.
Patologické zduření na krku může být již pozdním projevem šíření nádoru do spádových lymfatických uzlin, nebo přímým prorůstáním tumoru.
Nádory ušního boltce, většinou karcinomy bazocelulární, způsobují různě rozsáhlé, nehojící se ulcerace. Maligní nádory zevního zvukovodu astředouší, většinou karcinomy, připomínají chronický zánět zvukovodu astředouší. Příznaky maligních nádorů hlavy akrku jsou shrnuty vtabulce 2.1.
Tabulka 2.1 Symptomatologie maligních nádorů hlavy akrku
Nádory voblasti nosu, nosohltanu
Huhňavost aparanazálních dutin
Nosní neprůchodnost (zejména jednostranná)
Krvácení znosu (zejména jednostranné)
Zápach znosu
Porucha čichu
Bolest hlavy
Porucha sluchu (zejména jednostranná)
Bolest uší (zejména jednostranná)
Zduření na krku
Zduření vobličeji
Obrny hlavových nervů
Dvojité vidění
Zhoršení zraku
Nádory voblasti orofaryngu ahypofaryngu
Bolest vkrku avuších
Pocit cizího tělesa
Bolestivost při polykání
Obtíže při polykání
Zápach zúst
Krvácení zdutiny ústní
Zduření na krku
Nádory hrtanu
Nádory velkých slinných žláz
Nádory ucha
Chrapot
Dušnost
Pocit cizího tělesa
Bolest vhrtanu
Polykací potíže
Váhový úbytek
Zduření na krku
Zduření voblasti slinných žláz (příušní, podjazyková a čelistní)
Bolestivost vtěchto krajinách
Parestezie nebo obrna lícního nervu
Vleklý výtok zucha často spříměsí krve, nedoslýchavost, ušní šelest, bolest ucha, závrať, obrna lícního nervu
2.5 Histologie maligních nádorů hlavy akrku
Většina maligních tumorů hlavy akrku vychází zpovrchového epitelu, aproto je zde nejčastějším histologickým typem nádoru dlaždicobuněčný (spinocelulární) karcinom. Představuje až 90 %všech tumorů. Vnazálních aparanazálních dutinách je nejčastějším histolotickým typem adenokarcinom. Mimo spinocelulární karcinomy (verukózní karcinomy) jsou vtéto oblasti popisovány vřetenobuněčné karcinomy anediferencované karcinomy.
Dalšími histologickými typy maligních nádorů voblasti hlavy akrku jsou:
•adenoidně-cystické karcinomy
•mukoepidermoidní karcinomy
•lymfoepiteliomy
•lymfomy
•melanomy
•sarkomy
•extramedulární plazmocytomy.
Zvláštním typem tumoru této lokalizace je lymfoepiteliom (karcinom slymfoidním stromatem) vyskytující se voblastech, kde je vsubmukóze nahloučena lymfatická tkáň, zvláště vnosohltanu, tonzilách avkořeni jazyka. Bývá citlivější kozáření achemoterapii než spinocelulární karcinom, ale méně citlivý než maligní lymfomy. Zdůrazňujeme, že tento lymfoepiteliom je řazen ke karcinomům, nikoliv kmaligním lymfomům.
Vzácně bývá diagnostikován vuzlinách takzvaný mimokostní plazmocytom avoblasti nosu olfaktorní estezioneuroblastom.
2.6 Diagnóza
Výchozím bodem ke stanovení diagnózy maligních nádorů hlavy akrku je pečlivá anamnéza zaměřená na místní acelkové příznaky (váhový úbytek, poruchy chuti), sociální zvyklosti arizikové faktory. Následuje základní klinické vyšetření aendoskopická vyšetření. Řada nádorů hlavy akrku je dobře přístupná aspekci, palpaci apřímým inepřímým endoskopickým metodám. Rozhodující je odběr vzorku khistologickému vyšetření. Vrámci základních vyšetření, vedoucích ke stanovení diagnózy alokálního rozsahu nemoci, se provádí:
•Zobrazovací metody: rentgenový snímek apak nativní CT nebo MR zobrazení, které přináší zá-
sadní informaci ohloubce arozsahu nádoru, postižení chrupavky, kosti, perivaskulárním šíření azároveň přináší informaci ospádových lymfatických uzlinách, viz obr. 2.1, 2.2, 2.3 a2.4.
•Sonografie krku včetně ultrazvukového 2D- vyšetření umožňují posoudit vztah rozsáhlého nádoru karteria carotis.
•Karotická angiografie, případně angiografie, provedená při magnetické rezonanci.
•Panendoskopie vnarkóze, umožňující diagnózu vícečetných tumorů.
•Sonografie krčních uzlin. Zvětšené uzliny zjištěné palpací asi ve 30 %neobsahují nádorové buňky, zatímco nehmatné uzliny smetastázou karcinomu se vyskytují až u50 %pacientů smaligním nádorem hlavy akrku. Ultrazvukové vyšetření krku hodnocené zkušeným lékařem může prokázat metastázu vnehmatné uzlině (nález kulovité uzliny spoměrem maximálního aminimálního průměru 1:1).
•Punkční biopsie nebo histologie uzlin. Vynikajících výsledků při diagnóze krčních metastáz karcinomu bývá dosahováno při aspirační cytolo-

Obr. 2.1 Karcinom hypofaryngu vyklenující se mezi piriformní recesy – RTG vyšetření faryngu, jícnu, polykacího aktu baryovou suspenzí, předozadní snímek. Při Valsalvově manévru a nafouknutí faryngu je patrné rozvinutí glosoepiglotických valekul i piriformních recessů, kontrastní látka zatéká asymetricky vlevo vlivem roztlačení hypofaryngu exofyticky intraluminálně rostoucím tumorem hypofaryngu.

Obr. 2.2 Exulcerovaný spinocelulární karcinom na krku – CT vyšetření po aplikaci kontrastní látky intravenózně – axiální sken v úrovni jazyka. Na levé straně krku je rozsáhlý exulcerovaný tumor od dolní čelisti dorzálně, od kůže po obratle krční páteře, zaujímající velké cévy krku vlevo, dosahující stěny mezofaryngu vlevo.
gii řízené ultrazvukem – až 76 %senzitivita a100 %specifita. Informaci získanou punkční biopsií lze považovat za dostačující pro ověření metastázy již dříve známého karcinomu. Pokud taková diagnóza není známa avúvahu připadá idiagnóza maligního lymfomu, je nutno provést totální exstirpaci celé uzliny. Punkční cytolologie přináší vždy podstatně méně informací než histologické vyšetření, proto pro zodpovězení otázky, jakou chorobou je uzlina postižena, je potřeba provést její totální exstirpaci, nikoliv punkci.
•Vrámci zjišťování vzdálených metastáz se provádí RTG hrudníku, případně CT hrudníku, sonografie břicha apřípadně scintigrafie skeletu.

Obr. 2.3 Karcinom kořene jazyka s metastázami do submandibulárních lymfatických uzlin – CT vyšetření, axiální řez těsně pod dolní čelistí. Tumorózní infiltrace báze jazyka je patrná jako areál smíšené denzity, po aplikaci kontrastní látky intravenózně se nepravidelně sytí.
2.7 Diferenciální diagnóza metastatického postižení krční uzliny bez známého primárního ložiska astanovení klinického stadia
Asi u2 až 3 %nemocných srakovinou hlavy akrku je diagnostikována zvětšená uzlina smetastázou sutajeným primárním ložiskem. Jedná-li se osolitární metastázu, nikoliv na první pohled zřejmý mnohočetný metastatický rozsev, tak následuje pátrání po primárním ložisku anásledně řešení primárního ložiska ismetastatickou uzlinou. Zvětšená uzlina jako první příznak se vyskytuje mnohem častěji než ve 2 až 3 %, toto číslo charakterizuje počet
Tabulka 2.2 Tklasifikace nádorů orofaryngu dle UICC (5. vydání)
Primární nádorPopis
T1 Nádor do 2 cm vnejvětším rozměru.
T2 Nádor více než 2 cm, avšak ne více než 4 cm vnejvětším rozměru.
T3 Nádor větší než 4 cm vnejvětším rozměru.
T4 Nádor se šíří do okolních struktur.

Obr. 2.4 Metastázy karcinomu hypofaryngu do lymfatických uzlin na krku – CT vyšetření, axiální řez.
Zvětšené uzliny až 25 mm se kontrastní látkou podanou intravenózně vysycují jen okrajově a nepravidelně, uvnitř jsou patrné hypodenzní (tmavé) areály, které odpovídají metastatické infiltraci zvětšené uzliny.
případů sutajeným primárním ložiskem, které se ani po intenzivním pátrání neodhalí.
Pokud je na první pohled zřejmý mnohočetný metastatický rozsev, je indikována paliativní léčba sohledem na výsledek histologického vyšetření uzliny.
Ukáže-li se při biopsii metastáza dlaždicového nediferencovaného karcinomu nebo anaplastického karcinomu, je třeba hledat primární ložisko především vpatrových tonzilách, nosohltanu, kořeni jazyka ahypofaryngu. Jde-li ometastázu adenokarcinomu, mělo by se myslet na štítnou žlázu, slinné žlázy, ženský prs, plíce atrávicí ústrojí. V5 až 15 %bývá přítomen synchronní karcinom plic nebo jícnu.
Vyjmenujeme několik základních vyšetření:
•základní instrumentální ORL vyšetření apanendoskopie cest dýchacích apolykacích
•základní laboratorní vyšetření
•rentgenové vyšetření plic
•sonografie orgánů dutiny břišní
•CT, případně MR nebo PET vyšetření
•„slepé“ biopsie – podle anatomické lokalizace, frekvence výskytu ahistologické charakteristiky.
Ke sledování průběhu onemocnění aefektu terapie (nikoliv při screeningu či primární diagnostice) lze použít kombinace sérových nádorových markerů: karcinoembryonální antigen (CEA), antigen skvamózních buněk (SCCA), tkáňový polypeptidový antigen (TPA) acytokeratinové antigeny (CYFRA 21–1).
Vzhledem knedostatečné specificitě asenzitivitě není výtěžnost vyšetření uvedených markerů ve vztahu kjejich ceně vyhovující. Prediktivní biomarkery jsou intenzivně studovány adosud nejsou vrutinní klinické praxi užívány.
Tabulka 2.3 Tklasifikace nádorů nazofaryngu dle UICC (5. vydání)
Primární nádorPopis
T1 Nádor je omezen na nazofarynx.
T2 Nádor se šíří do měkkých tkání orofaryngu a/nebo do dutiny nosní.
T2a bez šíření do parafaryngeálního prostoru.
T2b sšířením do parafaryngeálního prostoru.
T3 Nádor se šíří do kosti a/nebo paranazálních dutin.
T4 Nádor postihuje nitrolebí a/nebo mozkové nervy, infratemporální jámu, hypofarynx nebo očnici.
Tabulka 2.4 T klasifikace nádorů hypofaryngu dle UICC (5. vydání)
Primární nádorPopis
T1 Nádor je omezen na jednu sublokalitu hypofaryngu anení < 2cm vnejvětším průměru.
T2 Nádor postihuje více než jednu sublokalitu hypofaryngu, nebo se šíří na okolní struktury, nebo měří > 2 < 4cm, bez fixace hemilaryngu.
T3 Nádor měří > 4cm vnejvětším průměru, nebo je fixován hemilarynx.
T4 Nádor se šíří do okolní struktury (chrupavka štítná, prstencová, měkké tkáně krku, karotická arterie, prevertebrální fascie, svaly, štítná žláza a/nebo jícen).
Tabulka 2.5 Tklasifikace nádorů supraglottis dle UICC (5. vydání)
Primární nádorPopis
T1
Nádor je ohraničen na jednu sublokalitu supraglottis snormální pohyblivostí hlasivek.
T2 Nádor postihuje sliznici více než jedné sublokality supraglottis nebo glottis nebo oblast mimo supraglottis (sliznice kořene jazyka, valekula, mediální stěna piriformního sinu), bez fixace laryngu.
T3Nádor je omezen na larynx, sfixací hlasivek a/nebo postihuje následující: postkrikoidní krajinu, preepiglotické tkáně, hlubokou vrstvu kořene jazyka.
T4 Nádor se šíří skrze chrupavku štítnou a/nebo do měkkých tkání krku, štítné žlázy a/nebo ezofagu.
Tabulka 2.6 Tklasifikace nádorů glottis dle UICC (5. vydání)
Primární nádorPopis
T1Nádor je ohraničený na jednu hlasivku (T1a) nebo na obě hlasivky (T1b) snormální pohyblivostí hlasivek.
T2 Nádor se šíří do supra- nebo subglottis, je snížená pohyblivost hlasivek.
T3 Nádor je omezen na larynx, sfixací hlasivek.
T4 Nádor se šíří mimo larynx.
Tabulka 2.7 T klasifikace nádorů subglottis dle UICC (5. vydání)
Primární nádorPopis
T1 Nádor je ohraničen na subglottis.
T2 Nádor se šíří na hlasivky, snormální pohyblivostí hlasivek.
T3 Nádor je omezen na larynx, sfixací hlasivek.
T4 Nádor se šíří mimo larynx.
Tabulka 2.8 T klasifikace nádorů maxilárních dutin dle UICC (5. vydání)
Primární nádorPopis
T1 Nádor ohraničen na sliznici antra.
T2 Nádor serozí kosti dolní části vč. tvrdého patra a/nebo středního nosního průduchu.
T3 Nádor se šíří na některé znásledujících míst: tvář, spodina orbity, etmoidy, zadní stěna antra.
T4 Nádor postihuje obsah orbity aokolní struktury.
Tabulka 2.9 T klasifikace nádorů čichových dutin dle UICC (5. vydání)
Primární nádorPopis
T1 Nádor ohraničen na čichový labyrint.
T2 Nádor se šíří do nosu.
T3 Nádor se šíří do přední části orbity a/nebo do maxilární dutiny.
T4 Nádor se šíří do orbity včetně apexu, nitrolebí, sfenoidálních a/nebo frontálních dutin a/nebo kůže nosu.
Tabulka 2.10 Tklasifikace nádorů slinných žláz dle UICC (5. vydání)
Primární nádorPopis
T1Nádor ≤ 2 cm nebo méně ve svém největším rozměru bez postižení kůže, měkkých tkání vokolí, kosti nebo nervu.
T2Nádor > 2 cm – < 4 cm ve svém největším rozměru bez postižení kůže, měkkých tkání vokolí, kosti nebo nervu.
T3Nádor se šířením mimo parenchym, bez postižení VII. nervu a/nebo nádor velikosti > 4 cm –< 6 cm ve svém největším rozměru.
T4 Nádor postihuje lebeční spodinu, VII. nerv a/nebo má > 6 cm ve svém největším rozměru.
Stanovení klinického stadia
Základem pro určení prognózy aléčby je klasifikace TNM, která je stručně shrnuta vtabulkách 2.2–2.11. Třídění do stadií je uvedeno vtabulce 2.12. Nově 5. vydání UICC navíc ještě rozděluje IV. stadium na A, BaC. TNM klasifikace je ovšem do určité míry zatížena subjektivní aplikací klasifikace a často bývá při klinickém vyšetření podhodnocena. Klasifikace krčních uzlin byla navržena vMemorial Sloan-Kettering Cancer Center (obr. 2.5).
2.8 Obecná léčebná strategie maligních nádorů hlavy akrku
Při volbě způsobu léčby přihlížíme ke známým prognostickým faktorům, především kpokročilosti nádoru (vyjádřené TNM klasifikací), jeho lokalizaci, histologickému typu, věku acelkovému stavu nemocného, taktéž je respektováno přání nemocných. Časné stadium nemoci (T1 N0T2N0) je diagnostikováno uméně než jedné třetiny nemocných. Tito pacienti mají nadě-
Maligní nádory hlavy a krku 33
ji na dosažení dlouhodobé remise. Ve II. stadiu je pětileté přežití dosahováno u40–70 %nemocných.
Více než 60 %pacientů má při stanovení diagnózy chorobu vintermediárním (T2N1 neboT3N0) nebo vlokálně pokročilém stadiu (T3–4 N2–3M0). Ztěchto nemocných může být dostupnými postupy vyléčeno méně než 30 %pacientů. Vzdálené metastázy jsou při stanovení diagnózy přítomné asi u10 %nemocných (schéma 2.1).
2.8.1 Léčba nediseminovaného onemocnění
Chirurgická terapie
Chirurgická terapie je základem. Snaží se excidovat tumor do zdravé tkáně.
Radioterapie
Radioterapie je nedílnou součástí léčby tumorů hlavy akrku. Ulokalizovaných, počátečních forem může dosáhnout vyléčení podobně jako operační zákrok. Při léčbě časných stadií maligních nádorů hlavy akrku (T1,T2) je léčba chirurgická aradioterapie považována za rovnocennou. Volba léčebného postupu pak závisí na náklonnosti lékaře kur-
Tabulka 2.11 Nklasifikace pro všechny lokalizace dle UICC (5. vydání)
Regionální Popis
lymfatické uzliny
N0Histologické vyšetření vzorku selektivní blokové disekce obsahuje 6 nebo více lymfatických uzlin. Histologické vyšetření vzorku radikální nebo modifikované blokové disekce obsahuje 10 nebo více lymfatických uzlin. Bez metastáz.
N1Metastáza vjediné stejnostranné mízní uzlině < 3 cm vnejvětším rozměru
N2Metastáza vjedné stejnostranné mízní uzlině vnejvětším rozměru > 3 cm – < 6 cm, nebo ve více stejnostranných uzlinách do 6 cm, nebo oboustranné nebo druhostranné postižení uzlin do 6 cm vnejvětším rozměru.
N2a Metastáza vjediné stejnostranné uzlině > 3 cm – < 6 cm vnejvětším rozměru.
N2b Metastázy ve více stejnostranných mízních uzlinách do 6 cm vnejvětším rozměru.
N2cMetastázy v oboustranných či druhostranných uzlinách, žádná není větší než 6 cm v největším rozměru.
N3Metastáza vmízní uzlině > 6 cm vnejvětším rozměru.
Tabulka 2.12 Třídění TNM stadií
Diagnostické a léčebné postupy u maligních chorob
čitému způsobu léčby, což je ovlivněno „školou“, předchozím tréninkem, zkušeností, erudicí, dostupností kvalitní radioterapie avneposlední řadě přáním samotného pacienta.
Za standardní léčbu pokročilých stadií maligních nádorů hlavy akrku (T3,T4, N1–3,M0) je považována léčba chirurgická vkombinaci s radioterapií
Radioterapie se často používá adjuvantně po operaci s cílem dosáhnout lepší lokální, případně lokoregionální kontroly nemoci, nebo příliš rozsáhlé výkony by byly tuze mutilující. V případě klinicky nenápadných uzlin doporučuje Strupp (2003) 45–50 Gy, vpřípadě klinicky zřetelného postižení uzlin dávku 66–76 Gy. Primární tumor či lůžko primárního tumoru doporu č uje oza ř ovat dávkou 60–70 Gy.
Pooperační radioteapie je indikována u nemocných s lokálně pokročilým tumorem, dále v případě pozitivních resekčních linií, při infiltraci cév, při postižení regionálních uzlin nebo při extrakapsulárním
šíření. Radioterapii lze použít samotnou, nebo současně (konkomitantně) s chemoterapií.
Neoadjuvantní chemoterapie aradioterapie, případně jejich současná (konkomitantní) aplikace
Pokud by tumor pro svou velikost nebyl operabilní, je vhodné použití neoadjuvantní chemoterapie, případně radioterapie apo zmenšení tumoru přikročit koperaci. Nejvýraznějšího ústupu tumoru je dosahováno, použije-li se radioterapie achemoterapie současně jako takzvaná konkomitantní chemoradio- nebo radiochemoterapie. Na druhé straně je však nutno uvést, že svyšší účinností se zvyšuje toxicita léčby. Dle publikovaných klinických studií má neoadjuvantní chemoterapie potenciál prodloužit přežití. Zvlášť výhodné je souč asné podání radioterapie achemoterapie ukarcinomu nosohltanu. Za nejúčinnější cytostatika voblasti hlavy akrku je považována karboplatina, 5–fluorouracil a taxany.
Obr. 2.5
Rozdělení krčních uzlin dle Memorial Sloan-Kettering Cancer Center (převzato amodifikováno)
Legenda:
I – submandibulární a submentální uzliny
II – horní jugulární uzliny
III – střední jugulární uzliny
IV – dolní jugulární uzliny
V – uzliny v zadním krčním trojúhelníku
Lokoregionální chemoterapie
Vindikovaných případech lze použít lokoregionální chemoterapii (pokud je ktomu technické vybavení) snásledným ozářením. Metoda intraarteriální chemoterapie je stále určitým způsobem zajímavá, avšak nestala se standardní léčebnou metodou azůstala spíše na periferii zájmu.
2.8.2 Léčba diseminovaného onemocnění
Za standardní p ř ístup vlé č b ě recidivujících maligních nádorů hlavy akrku anádor ů se vzdáleným metastatickým rozsevem je považována chemoterapie snáslednou radioterapií, p ř ípadn ě paliativním chirurgickým výkonem. Nově se ov ěř uje konkomitantní ozář ení schemoterapií i vtéto indikaci. Vp ř ípadech relapsu č i progrese je nutno vzít do úvahy úč inek p ř edchozích použitých lé č ebných modalit, vpř ípad ě zvažování další chemoterapie vyhodnotit její př edchozí ú č inek a interval do progrese (neboli úč innost p ř edchozí lé č by) a dle toho zvážit, zda je nadě je na další úsp ě ch pak vchemoterapii pokrač ovat, nebo zda dosažení lé č ebné odpov ě di není pravdě podobné, apreferovat symptomatickou léč bu p ř ed chemoterapií.
U pacientů vdobrém celkovém stavu se vzdálenými metastázami se doporučuje paliativní chemoterapie (cisplatina/5-fluorouracilem, karboplatina/fluorouracil, karboplatina/taxan). Kombinovaná chemoterapie dosahuje delší remise než monoterapie, rozdíl vcelkovém přežití je však méně zřetelný. Pro monoterapii je nejčastěji používán metotrexát, platinové deriváty, 5-fluorouracil. Lze použít také bleomycin, hydroxyureu a taxány.
Léčba metastatického postižení krčních uzlin
Pravd ě podobnost metastazování karcinomů hlavy akrku je pom ě rn ě vysoká, aproto lé č ba metastáz maligních nádorů hlavy akrku do kr č ních uzlin podstatn ě ovliv ň uje úsp ě šnost lé č by. Lé č ba je chirurgická, v ě tšinou vkombinaci sradioterapií. Chirurgická lé č ba spo č ívá vodstran ě ní spádových lymfatických uzlin vjednom bloku společ n ě sodstran ě ním primárního tumoru. Podle př edpokládaného rozsahu postižení blokové disekce rozd ě lujeme na úplné odstran ě ní všech uzlin na krku, oblast I–V, viz obr. 2.5, selektivní – jsou odstran ěny pouze ty skupiny uzlin, které mají nejvě tší pravd ě podobnost postižení a rozší ř ené , kde je zahrnuta iresekce dalších lymfatických anelymfa-
tických struktur. Tyto disekce se dále modifikují podle rozsahu šet ř ení d ů ležitých struktur –n.accessorius, v.jugularis interna am. sternocleidomastoideus.
2.9 Podrobnější informace oléčbě asledování po ukončení léčby
Vradioterapii jsou široce používány zm ě ny frakcionačního schématu (ozařování 2x denně) svyšší jednotlivou frakcí aaplikací celkových dávek kolem 50 Gy za období 3 týdnů, což radiobiologicky odpovídá 70 Gy za 7 týdnů při prosté frakcionaci. Lokální kontrola primárního tumoru je stejná, ovšem akutní radiační reakce je větší. Na podkladě studií je prokázáno, že taktika ochrany zdravých tkání při zmenšení pozdních postirradiačních změn je možná při použití menší dávky na frakci avícekrát denně (hyperfrakcionace), nebo při zkrácení doby ozáření (akcelerovaná frakcionace). Maximalizace lokální kontroly sminimálním poškozením okolní tkáně ovšem nezávisí pouze na frakcionaci avýši dávky záření, ale též na homogenním ozáření cílového objemu, ochraně zdravých tkání apřesné reprodukovatelnosti ozáření. Vzhledem kvysoké incidenci metastatického postižení regionálních lymfatických uzlin je nutné jejich ozáření. Vpraxi cílový objem zahrnuje spolu sprimárním tumorem iobě strany krku. Kritickým orgánem je mícha, kde je tolerována dávka záření 40–45 Gy při konvenční denní frakcionaci 1,8 až 2 Gy. Standardní dávka záření na tumor je 65–70 Gy vobdobí 6,5–7,5 týdne.
Vzhledem kneuspokojivým výsledkům standardní léčby bývá vrámci klinického experimentu ve větších onkologických centrech podávána indukční chemoterapie upokročilých operabilních karcinomů hlavy akrku nemocným vdobrém celkovém stavu, ve věku do 70 let, sváhovým úbytkem menším než 15%as dobrými výsledky biochemických laboratorních testů. Algoritmus pro léčbu maligních nádorů hlavy akrku snejvětší incidencí – laryngu, orofaryngu ahypofaryngu je uveden ve schématu 2.2.
Detailnější postup při léčbě nemocných snejčastějšími maligními nádory hlavy akrku je zobrazen vtabulce 2.13–2.15. Při nádorech čelistních dutin bývá dle rozsahu prováděna parciální nebo totální maxilektomie, podle potřeby isexenterací
Diagnostické a léčebné postupy u maligních chorob orbity. Defekt po rozsáhlých maxilektomiích bývá svýhodou nahrazován dvouostrůvkovým muskulokutánním lalokem sdefinovanou cévní stopkou. Přestože se snažíme ozachovávání určitých standardních lé č ebných postup ů , neváháme podle okolností léčbu individuálně přizpůsobit danému pacientovi. Důležitou součástí péče oonkologicky nemocné jsou dispenzární prohlídky. Nejsou-li přítomny příznaky recidiv či metastáz, provádí se vyšetření podle uvedeného schématu (tab. 2.16),
Tabulka 2.13 Chirurgická léčba karcinomu orofaryngu
StadiumLéčba
Stadium I-II
Stadium III
vopačném případě je nemocný léčen asledován častěji.
Oblast nádorů hlavy a krku, neboli oblast nádorů spadajících do oblasti otorinolaryngologie je velmi pestrá a pro každou lokalizaci lze nalézt v odborné literatuře specifická doporučení. Jejich uvedením bychom neúnosně zvětšily rozsah knihy, takže vtomto bodě musíme zájemce o podrobnosti odkázat na aktuální doporučení NCCN distribuovaná na CD discích a na internetu.
Chirurgická léčba (resekce dle lokalizace arozsahu nádoru, většinou ztransorálního přístupu +revize parafaryngeálního prostoru, event. selektivní bloková disekce, použití chirurgického laseru je vhodné) nebo radioterapie. Výkonu chirurgickému bude dána přednost tam, kde dojde jen kminimálnímu funkčnímu deficitu.
Chirurgická léčba – parciální či totální glosektomie, rozšířená tonzilektomie, resekce měkkého patra, patrových oblouků – dle lokalizace nádoru, většinou zlaterální faryngotomie. Vzhledem kvysokému riziku metastazování iselektivní bloková disekce. Dále postoperační radioterapie. Kde nelze použít chirurgický výkon: chemoterapie +radioterapie. Zvažuje se použití neoadjuvantní chemoterapie, zatím jen vrámci klinických protokolů
Stadium IV Resekabilní nádory: chirurgická léčba (resekce tumoru, při infiltraci mandibuly a/nebo maxily, resekce mandibuly /maxily/ snáslednou náhradou laloky sdefinovanou cévní stopkou, bloková disekce, vzhledem kvysokému riziku metastazování iselektivní bloková disekce) + pooperační radioterapie Neresekabilní nádory: radioterapie +chemoterapie (konkomitantně, hyperfrakcionace).
Tabulka 2.14 Chirurgická léčba karcinomu hypofaryngu
StadiumLéčba
Stadium I-II
Chirurgická léčba (laryngofaryngektomie akrční bloková disekce, ve vybraných případech postižení recessus piriformis parciální laryngofaryngektomie) a pooperační radioterapie Ve stadiu II se hodnotí účinek neoadjuvantní chemoterapie.
Stadium III Chirurgická léčba (laryngofaryngektomie akrční bloková disekce. Při totální faryngektomii náhrada hypofaryngu lalokem sdefinovanou cévní stopkou vjedné operační době. Peroperační histologické vyšetření ke stanovení bezpečných hranic resekce nádoru) a pooperační radioterapie. Hodnotí se efekt neoadjuvantní chemoterapie.
Stadium IV
Resekabilní: Chirurgická léčba apooperační radioterapie, účelná může být i neoadjuvantní chemoterapie
Neresekabilní: radioterapie vkombinaci s chemoterapií.
Tabulka 2.15 Chirurgická léčba karcinomu glottis a supraglottis
StadiumLéčba
Stadium I Chirurgická léčba nebo radioterapie. Dle lokalizace arozsahu – supraglottis: epiglotektomie nebo parciální supraglotická horizontální laryngektomie – glottis :chordektomie.
Stadium II Chirurgická léčba nebo radioterapie. Dle lokalizace arozsahu léze: Supraglottis – parciální horizontální supraglotická laryngektomie nebo totální laryngektomie. Glottis – parciální frontolaterální laryngektomie.
Stadium III Chirurgická léčba (totální laryngektomie, umetastáz do krčních uzlin bloková disekce). Vpřípadě nemožnosti operace – chemoterapie aradioterapie
Stadium IV Chirurgická léčba (totální laryngektomie, bloková disekce) a pooperační radioterapie, event. neoadjuvantní chemoterapie +definitivní radioterapie, resp. konkomitantní chemoradioterapie. Pro vzdálené metastázy chemoterapie +radioterapie.
Schéma 2.1 Základní schéma léčebného postupu u maligních nádorů hlavy a krku
Maligní nádory hlavy a krku
Časné stadium T1, T2, T3, T4
Chirurgie Radioterapie
Místně pokročilý nádor T3, T4, N1–N3, M0
Standard: Chirurgie + Radioterapie
Další léčebné možnosti v klinické úvaze: Neoadjuvantní chemoterapie –chirurgie + radioterapie adjuvantní chemoterapie nebo konkomitantní radioterapie + chemoterapie
Metastazující a recidivující nádor
Standard: Chemoterapie + event. radioterapie event. + chirurgie
Další léčebné možnosti v klinické úvaze: konkomitantní radioterapie + chemoterapie
Schéma 2.2 Léčebný algoritmus (v rámci klinické kontrolované studie) pro karcinomy orofaryngu, hypofaryngu a supraglottis
Karcinomy orofaryngu, hypofaryngu a supraglottis
Klinické stadium I a II
Operace Radioterapie
Klinické stadium III a IV (M0)
Operabilní nádory
Inoperabilní nádory
Klinické stadium III a IV (M1) + recidivy
Lokální paliace – zvážit chirurgickou léčbu, nebo radioterapii a chemoterapii – jsou-li proto podmínky
2 cykly chemoterapie. Je-li léčebná odpověď, pak další cyklus, dále operace a ozáření. Není-li odpověď, pak operace a ozáření
2 cykly chemoterapie. Je-li léčebná odpověď, pak další cyklus, zvážení operability, event. operace, následné ozáření. Není-li léčebná odpověď – ozáření
Tabulka 2.16 Schéma dispenzárních prohlídek
Kontrola
Interval
Pravidelné klinické ORL vyšetřeníPrvní rok :po 1měsíci
Druhý rok :po 2 měsících
Třetí rok :po 3–4 měsících
Další roky :po 6–12 měsících
Další vyšetření
RTG plic 1x ročně
SONO jater 1x ročně
KO+diff +screening`a3 měsíce
CT lokoregionálního nálezu individuálně
Po 3 letech se intervaly prodlužují.
2.10 Prognóza arizikové faktory
Vzávislosti na lokalizaci nádoru se prognóza horší od rtů směrem do hypofaryngu. Nádor kořene jazyka má horší prognózu než ostatní nádory dutiny ústní, nádory tonzil mají naopak lepší prognózu než jiné nádory vyr ů stající zhypofaryngu, nádory subglottis mají horší prognózu než nádory glottis. Umaligních nádorů slinných žláz je horší prognóza unádorů submandibulárních slinných žláz než upříušních slinných žláz. Sekundární malignity vaerodigestivním traktu jsou popisovány až u40 %nemocných léč ených pro první karcinom, kteř í nepřestali kouřit. Klokálním aregionálním recidivám dochází až v66 %avětšina recidiv se objevuje do 2 let od začátku léčby. Vzdálené metastázy nejsou časté avznikají většinou pozdě. Pacienti vI.klinickém stadiu dosahují 5letého přežití v75–90%, pacienti ve II. klinickém stadiu ve 40–70%, ve III. klinickém stadiu ve 20–50 %ave IV. klinickém stadiu v10–30 %. Prognóza pacientů smaligními nádory hlavy akrku je ještě zhoršována
častými přidruženými chorobami (jaterní cirhóza, onemocnění oběhového adýchacího ústrojí aj.).
2.11 Perspektivy
Výrazného pokroku vléčbě zhoubných nádorů hlavy akrku by mohlo být dosaženo pomocí vhodných preventivních programů zacílených na rizikové skupiny obyvatelstva. Jde především oomezení, resp. zanechání kou ř ení apití destilát ů azískání zodpovědnějšího přístupu kvlastnímu zdraví. Výsledky léčby maligních nádorů hlavy akrku lze také zlepšit časnějším záchytem onemocnění, k čemuž může výrazně přispět ilékař první linie. Ve stadiu klinického výzkumu doposud zůstává chemoprevence retinoidy. Jejich klinickému využití stojí vcestě značná toxicita. Ke zlepšení výsledků léčby by mohlo přispět inalezení vhodných prediktivních biomarkerů pro nádory hlavy akrku atéž uplatnění nových cytostatik vléčebném schématu.
Literatura
AL SARRAF,M., PAJAK, TF., BYHARDT, RW., ETAL.: Postoperative radiotherapy with concurrent cisplatin appears to improve locoregional control of advanced, resectable head and neck cancers: RTOG 88–24. Int. J.Radiat. Oncol. Biol. Phys., 37,1997; 777–82 .
BECKER, W., NAUMANN, HH., PFALTZ, CR.: Ear, Nose and Throat Diseases. 3rd edition, Georg Thieme Verlag: Stuttgart-New York 1989.
BETKA, J.:Příspěvek ke klasifikaci krčních uzlin ablokových disekcí. Otolaryngol. 45, 1996; 73–77.
CALAIS,G., ALFONSI,M., BARDET, E., ETAL.: Radiation alone (RT) verus RT with concomitant chemotherapy (CT)in stages III and IV oropharynx carcinoma. Results of the 94.01 randomized study from the French group of radiation oncology for head and neck cancer. Acta Oto-Rhino-Laryngologica Belgica. 53,1999; 306.
DINARDO, LJ., KAYLIE,DM., ISAACSON, J.: Current treatment practices for early laryngeal carcinoma. Otolaryngology-Head and Neck Surgery, 120, 1999; 1: 30–37.
HÁJEK, R., VORLÍČEK, J., SLAVÍK,M.: Přehled protinádorové aktivity paclitaxelu (Taxol’R’) vklinických studiích. Klin. Onkol., 8, 1995; 2: 33–44.
HYBÁŠEK, I.: Ušní, nosní akrční lékařství. 1. vyd. Galén: Praha 1999.
KLENER, P.: Protinádorová chemoterapie. 1. vyd. Galén: Praha 1996.
KOCH, WM., LANGO,M., SEWELL, D., ETAL.: Head and Neck Cancer in Nonsmokers: Adistinct Clinical and Molecular Entity. Laryngoscope, 109, 1999; 1544–1551.
LAER, CV., EYNING, PV., HAMANS, E, ETAL.: Diagnostic Procedures in Head and Neck Cancer. Acta Oto-Rhino-Laryngologica Belg., 53, 1999; 145–148.
MECHL, Z., VORLÍČEK, J., NĚMEC, J.: Historie protinádorové chemoterapie. Klinická onkologie, 11,1998; 173–182.
MILLION, RR., CASSISI, NJ., CLARK, JR.: Cancer of the Head and Neck, s.488–590 In: DeVita, VincentT.Jr., Hellman, S., Rosenberg, S.A.: Cancer, principles &Practice of Oncology, 3rd Edition, J.B. Lippincott Company: Philadelphia 1989.
NEKULOVÁ,M., ŠIMÍČKOVÁ,M., ČERNOCH,M.: Nádorové markery. Klin. Onkol., 8, 1995; 60–63.
STRUPP. R., VOKES EE.: Kopf und Halstumoren.. In.: SEEBER, S., SCHÜTTE, J.: Therapiekonzepte Onkologie. 4. vydání, Springer, Berlin, Heidelberg, 2003.
URBA, S.: Concurrent Chemoradiation for Head and Neck Cancer. American Society of Clinical Oncology 2000, Education book 215.
WAX, MK., TOUMA, BJ.: Management of the N0 neck during salvage laryngectomy. Laryngoscope 109, 1999; 1: 4–7.
3Bronchogenní karcinom
3.1 Definice
Termínem bronchogenní karcinomy se označují jak nádory průdušek, tak nádory, které vznikají vplicním parenchymu. Jejich klinický obraz je velmi podobný, aproto je nelze od sebe přesně oddělit. Vanglické literatuře se proto používá termínu lung cancer.
Nádory průdušek obvykle později prorůstají do plicního parenchymu, nebo průdušku, ve které vznikly, uzavírají, což vede knásledným změnám vplicním parenchymu. Nádory, které naopak původně vznikly vplicním parenchymu, často později prorůstají do průdušek. Přesné stanovení, zda nádor pochází zoblasti průdušek nebo zplicního parenchymu, není vždy možné aani nemá pro další léčbu význam. Bronchogenní karcinomy dělíme podle biologického chování, podle histologického složení apodle lokalizace.
Pro praxi má největší význam dělení na skupinu malobuněčných karcinomů (25–30 %) askupinu nemalobuněčných karcinomů (přibližně 70–75 %), protože zrozdílných biologických vlastností malobuněčných anemalobuněčných karcinomů vyplývá irozdílný přístup kléčbě. Vanglické terminologii se používá Small Cell Lung Cancer pro malobuněčné bronchogenní karcinomy a Non Small Cell Lung Cancer pro skupinu nemalobuněčných bronchogenních karcinomů. Malobuněčné bronchogenní karcinomy se vyznačují rychlým růstem, výrazným sklonem k časnému metastazování do kostí, jater, centrálního nervového systému, nadledvin. Jsou zpočátku velmi senzitivní na radioterapii achemoterapii, jejich chemo- aradiosenzitiva však po čase přejde vchemo- aradiorezistenci, takže ač chemoterapie zprvu dosáhne výrazného úspěchu, tumor se časem stane rezistentním ajeho průběh již dále není chemoterapií aradioterapií ovlivnitelný.
Nemalobuněčné bronchogenní karcinomy rostou pomaleji, metastazují později, kradioterapii aprotinádorové chemoterapii jsou však málo citlivé.
3.2 Epidemiologie
Vcelosvětovém měřítku zaujímá bronchogenní karcinom druhé místo mezi všemi zhoubnými nádory. V ČR je na prvním místě mezi zhoubnými nádory umužů ana prvním místě vpříčinách úmrtí na zhoubné nádory. Během roku onemocní touto chorobou přibližně jeden muž ztisíce.
V ČR bylo vroce 1989 nahlášeno 5028 nových onemocnění umužů a895 užen. Vroce 1998 to bylo 4790 umužů a1293 užen. Ke 31. 12. 1998 bylo dispenzarizováno 7282 pacientů. Incidence byla vroce v1998 umužů 96,1/100 000 obyvatel (1995 – 94,2) aužen 24,5/100 000 (1995 –21,1).
Užen pozorujeme trvale vzestupný trend vpočtu nově zjištěných onemocnění. Od roku 1980 do roku 1998 se počet nově zjištěných případů rakoviny plic užen více než zdvojnásobil (1980 – 10,6/100000, 1998 – 24,5/100000). Umužů byl vtěchto letech počet nově zjištěných případů trvale na vysoké úrovni (1980 – 97,6/100000, 1998 – 96,1). Četnost výskytu bronchogenního karcinomu umužů v České republice odpovídá výskytu tohoto onemocnění ve Velké Británii (100/100000).
Bronchogenní karcinom bývá obvykle diagnostikován ve věku 35 až 85 let, nejčastější výskyt je mezi 55. až 80. rokem života.
3.3 Etiologické faktory
3.3.1 Endogenní faktory
Familiární kumulace neoplazií aasociace bronchogenního karcinomu sněkterými afekcemi, např. sklerodermií, svědčí omožnosti genetické predispozice. Zendogenních příčin byla popsána souvislost se zvýšenou aktivitou cytochromu P-450, která způsobuje zvýšenou tvorbu kancerogenů zcigaretového kouře, dále se sníženou aktivitou glutation S- transferázy důležité pro detoxikaci aromatických uhlovodíků asní-
Diagnostické a léčebné postupy u maligních chorob
ženou aktivitou buněčných mechanismů opravujících DNA. Jsou popsány chromozomální aberace vedoucí k častějšímu výskytu bronchogenního karcinomu, například delece 3p21, dále genové změny, mutace supresorického genu p53 nebo zvýšená exprese některých onkogenů ze skupiny c-myc.
3.3.2 Exogenní faktory
Hlavní roli nepochybně hrají faktory exogenní: biologické (viry), fyzikální (ionizující záření) azejména chemické (karcinogeny).
Epidemiologické studie nezvratně prokázaly zvýšené riziko bronchogenního karcinomu ukuřáků Jako „těžký kuřák“ je definován ten, kdo kouřil alespoň 20 cigaret denně po dobu alespoň 20 let, nebo 40 cigaret denně po dobu 10 let atd. Těžký kuřák má 10–15% pravděpodobnost, že se uněj rozvine plicní karcinom. To sice znamená, že 85–90 %těžkých kuřáků karcinom plic nedostane, neznamená to však, že neonemocní anezemřou předčasně – nikoli vinou karcinomu plic, nýbrž jiných nemocí, unichž se kouření rovněž uplatňuje jako etiologický faktor (karcinom močového měchýře, karcinomy hlavy akrku, chronická bronchitida aemfyzém plic sjejich kardiovaskulárními důsledky; onemocnění periferních cév, ischemická choroba srdeční).
Kuřáci, kteří kouřili více než 20 cigaret denně po 20 let, mají 20x vyšší riziko vzniku bronchogenního karcinomu než nekuřáci (riziková hranice je 200 000 vykouřených cigaret); záleží též na způsobu kouření ahloubce inhalace cigaretového kouře. Relativní riziko kuřáků proti nekuřákům je 13.3 (17.4 umužů, 10.8 užen).
Na druhé straně však je pravda, že krozvoji plicního karcinomu může dojít iuceloživotního nekuřáka; jde otzv. spontánní karcinom. Umladých žen se objevuje specifický typ plicního karcinomu (bronchoalveolární karcinom). Pokud jde otzv. pasivní kouření, existuje dostatek přesvědčivých dat, svědčících otom, že významná expozice může vést ke zvýšenému riziku plicní rakoviny iunekuřáků Největšímu riziku jsou vystaveny děti chronicky exponované cigaretovému kouři doma, nebo zaměstnanci pracující vzakouřeném prostředí. Příležitostná expozice cigaretovému kouři například vrestauraci naproti tomu plicní karcinom nevyvolává. Relativní riziko pasivních kuřáků oproti nekuřákům je 1.5.
Existují však expozice vpracovním prostředí, které mohou riziko karcinomu zvyšovat: azbest, těžké kovy jako rtuť, nikl, chróm, arzén, nikl; chloro-
vané uhlovodíky, polycyklické aromatické uhlovodíky, nitrózoaminy, ionizující záření (uhorníků vuranových dolech je karcinom plic uznáván jako choroba zpovolání) aUV záření, chronická expozice různým prachům či radonu.
Expozice azbestu aradonu se neomezují jen na profesionální příležitosti. Azbest býval astále je součástí stavebních aizolačních materiálů ivněkterých současných velkých nemocnicích. Relativní riziko exponovaných osob je 1.4–2.6.
Radon222 je inertní plyn, vznikající jako rozpadový produkt uranové řady. Rozpadem radonu vznikají radioaktivní prvky. Radon může pronikat do obytných domů zgeologického podloží iznevhodně použitých stavebních materiálů. Koncentrace vbytových nebo pracovních prostorách závisí na konstrukci budov ana kvalitě odvětrávání. Asi 2 % populace ČR bydlí vdomech se zvýšenou koncentrací radonu.
Ikdyž znečištěné ovzduší jistě nemá takový význam vetiologii bronchogenního karcinomu, jak sami kuřáci rádi tvrdí, je nutno připustit, že ekologicky nepříznivé vlivy, zejména vliv oxidu siřičitého, se rovněž uplatňují.
3.4 Symptomy nemoci
Všechny symptomy již znamenají nemoc relativně pokročilou; neexistují časné varovné signály, které by umožnily zachycení choroby vpočátečním stadiu. Jakmile se příznaky nemoci objeví, je už karcinom ve stadiu pokročilém. Pro přehlednost dělíme příznaky do tří skupin:
1. Intratorakální neboli lokální plicní příznaky. Jejich výskyt závisí především na lokalizaci nádoru.
2. Extratorakální neboli metastatické.
3. Paraneoplastické.
3.4.1 Počáteční symptomy zlokálního postižení
Nově vzniklý dlouhotrvající kašel
Nejběžnějším symptomem primárního karcinomu plic je kašel. Jde-li okašel nově vzniklý uosoby netrpící chronickou bronchitidou či jinými respiračními chorobami apřetrvává-li déle než 3 až 4 týdny ipřes léčbu bronchitidy, je to indikací krentgenovému snímku hrudníku.
Kašel bývá zpravidla suchý, pouze ubronchioloalveolárního karcinomu se může vyskytovat kašel
sexpektorací vazkého hlenovitého sputa. Vdobě stanovení diagnózy bronchogenního karcinomu trpí kašlem asi 80 %nemocných.
Změna charakteru chronického kuřáckého kašle Protože většina nemocných splicním karcinomem jsou kuřáci, často chápou kašel jako pouze kuřácký, byť třeba přechodně zhoršený. Takzvaný kuřácký kašel vskutku nemusí bezprostředně zvěstovat plicní karcinom, ale vždycky je něčím abnormálním. Nepřestane-li kuřák kouřit, měl by přinejmenším bedlivě sledovat charakter kašle azejména jeho případnou změnu (větší frekvence, intenzita, úpornost, okolnosti výskytu).
Hemoptýza
Dalším symptomem, který zřídkakdy bývá přehlédnut, je hemoptýza, kníž dochází, jakmile primární tumor eroduje bronchiální cévu. Hemoptýza se vdobě stanovení diagnózy vyskytuje asi u20 %nemocných. Spíše než vmasivní podobě přichází hemoptýza vpodobě drobných krvavých nitek ve sputu. Obvykle se jedná jen onepatrné nitky krve ve sputu, nikoliv omasivní vykašlávání krve.
Pneumonie
Běžným příznakem, jímž se plicní karcinom projevuje, je pneumonie, která neregreduje po antibiotické léčbě, nebo má tendenci kobnovování ve stále stejné lokalizaci. Ktéto takzvané retenční pneumonii dochází, je-li bronchus buďto utlačen zvenčí nebo obturován ve svém luminu; za překážkou pak snadno dochází krozvoji infekce. Pneumonie se může projevovat klasickými symptomy – horečkou akašlem sprodukcí purulentního sputa. Proto je důležité ukaždého dospělého nemocného, byť se již cítí opět zdráv, provést kontrolní snímek plic za několik týdnů po prodělané pneumonii. Jestliže nedochází kpřesvědčivé resorpci pneumonického infiltrátu, je zapotřebí podrobného vyšetření scílem vyloučit bronchogenní karcinom. Kobturaci arozvoji infekce udospělých pacientů může ovšem dojít ibez přítomnosti typických obtíží. Taková pneumonie, objevená víceméně náhodně, je příznakem obzvlášť neblahým.
3.4.2 Symptomy lokálně pokročilého karcinomu
Bolesti na hrudníku Invaze nádoru do parietální pleury, svalstva, žeber nebo kůže se ohlašuje bolestí. Bolest na hrudníku zjistí-
me při správně odebrané anamnéze u40 %nemocných. Je neurčitého charakteru, často je vázána na kašel anádech. Většinou souvisí spostižením pleury nebo nervových vláken, ale může být podmíněna iosteolýzou žeber. Bolest hrudní stěny je nejčastějším příznakem regionálního šíření plicního karcinomu.
Bolesti způsobené infiltrací plexus brachialis Zvláštní lokalizaci představuje plicní hrot – zde přistupují kvýše jmenovaným strukturám ještě plexus brachialis, jehož postižení prorůstajícím nádorem nebo infiltrovanými uzlinami může nemocnému způsobit kruté bolesti horní končetiny, akrční sympatická pleteň. Pacienti stímto typem plicního karcinomu, zvaným Pancoastův tumor, jsou někdy zpočátku vyšetřováni aléčeni ortopedicky nebo neurologicky, někdy na úkor času potřebného ke stanovení diagnózy bronchogenního karcinomu. Tzv. Pancoastův tumor má ještě další specifické projevy: tzv. Hornerův (Claude-Bernard-Hornerův) syndrom (= mióza – ptóza – enoftalmus) zpostižení krční sympatické pleteně asyndrom horní duté žíly. Lokální nitrohrudní progrese tumoru někdy může indukovat iperikarditidu, poruchy srdečního rytmu, známky srdeční tamponády nebo srdečního selhávání, vznikající při prorůstání nádoru do perikardu amyokardu.
Chrapot asyndrom horní duté žíly
Další charakteristickou oblastí lokálního šíření plicního karcinomu je mediastinum. Šíří-li se karcinom do mediastina, objevuje se především chrapot asyndrom horní duté žíly. Chrapot je jedním znejčastějších symptomů spojených slokálním šířením karcinomu. Nervus laryngeus recurrens, ovládající levou hlasivku, vychází zkrční míchy, obtáčí velké cévy avrací se khlasivkám; ve svém mediastinálním úseku tedy může být ohrožen rostoucím nádorem nebo izvětšenými uzlinami. Chrapot, způsobený útlakem rekurentu aparézou levé hlasivky, není doprovázen známkami infekce horních cest dýchacích, ani bolestí vkrku.
Na opačné straně hrudníku probíhá v.cava superior, drenující hlavu ahorní končetiny. Dojde-li kinvazi tumoru na pravou stranu krku nebo zvětšení tamních uzlin, může dojít ksyndromu horní duté žíly, jenž se projevuje nejprve distenzí krčních žil apozději otokem obličeje akrku (Stokesův límec) scyanózou.
Bolestivé pleurální dráždění
Periferně rostoucí nádor se může projevit bolestí zpleurálního dráždění nebo zpostižení hrudní stě-
ny. Dušnost se může výrazně zvětšit, podílí-li se na ní pleurální výpotek, jenž často doprovází periferně rostoucí nádory.
Kompresivní příznaky (syndrom horní duté žíly apolykací potíže)
Regionální progrese může způsobit istenózu průdušnice se stridorem, kompresi jícnu spolykacími obtížemi(obtížné či bolestivé polykání), již zmíněné poškození n.recurrens schrapotem nebo parézu n.phrenicus (apříslušné poloviny bránice).
Dušnost
Bývá přítomna u30 %nemocných. Může být podmíněna růstem samotného nádoru a/nebo vznikem pleurálního výpotku, který je takového rozsahu, že utlačuje plicní parenchaym. Pleurální výpotek může být vyvolán prorůstáním nádoru do pleurální dutiny, postižením pleury metastázami nebo obstrukcí lymfatických cév. Dušnost může být idůsledkem sekundární anemie.
3.4.3 Mimoplicní příznaky
Mimoplicní příznaky jsou vždy projevem rozsáhlého onemocnění.
Ikdyž bronchogenní karcinom může metastazovat do kteréhokoli orgánu, nejnápadnější projevy vyvolávají metastázy do CNS (neurologické či psychické poruchy), do skeletu (bolesti, patologické fraktury) ado kostní dřeně (anemie). Naproti tomu metastázy do jater, jež bývají časté i četné, mohou dlouho zůstávat klinicky němé, ato itehdy, když už je zřetelně hmatná hepatomegalie. Mnohočetné metastázy do jater se ovšem mohou projevit ikterem adalší hepatobiliární symptomatologií. Udává se, že vzdálené metastázy nacházíme u50 %spinocelulárních Ca, u80 %adenoCa au95 %malobuněčných Ca.
3.4.4 Paraneoplastické syndromy
Paraneoplastické projevy jsou ubronchogenního karcinomu velmi časté amohou být iprvním signálem onemocnění.
Endokrinní syndromy zahrnují hyperkalcemii ahyperfosfatemii při ektopické sekreci parathormonu nebo substance podobné parathormonu (parathormon-like hormon). Tyto příznaky doprovázejí jak spinocelulární karcinom, tak imalobuněčný karcinom. Dalším metabolickým příznakem je hy-
ponatremie při inadekvátní sekreci ADH ataké Cushingův syndrom shypokalemií při ektopické tvorbě ACTH (malobuněčný Ca).
Vrámci paraneoplastických syndromů se mohou vyskytnout ipříznaky kožní (dermatomyozitida), neurologické (periferní neuropatie), svalové (myastenie) acévní (migrující tromboflebitidy).
3.5Stanovení diagnózy
3.5.1Fyzikální (klinické) vyšetření
Při objektivním vyšetření bývá fyzikální nález na hrudníku unemocných sbronchogennímkarcinomem často normální. Někdy se však můžeme setkat soslabeným až vymizelým dýcháním, zkráceným poklepem, trubicovým dýcháním, př ízvu č nými chrůpky. Vymizelé dýchání azkrácený poklep svědčí pro přítomnost pleurálního výpotku. Nálezem nepříliš vzácným jsou ipískoty avrzoty, které mohou být slyšitelné nad jednou nebo či oběma plícemi. Cílevědomě musíme vyšetřovat ilymfatické uzliny, především nadklíčkové, za kývači avpodpažních jamkách. Na základě nálezu zvětšených jater, někdy snerovným okrajem, můžeme usuzovat na metastatické postižení. Symptomatologie pak odpovídá rozsahu apropagaci nádoru.
3.5.2 Zobrazovací vyšetření hrudníku
Zadopřední aboční skiagram hrudníku, případně klasické tomogramy Nádorová infiltrace se často zobrazuje jako zastínění buď vplicním parenchymu, nebo lokalizovaná centrálně voblasti hilu. Zastínění nemusí být vždy homogenní aostře ohraničené. Lze se setkat sprojasněním, což svědčí pro přítomnost rozpadu. Nádor může také podmiňovat rozšíření mediastina, deviaci struktur mediastina, zúžení hemitoraxu, vyšší postavení bránic. Obraz nádoru může být kombinován sjinými nálezy, jako je pleurální (spíše výjimečně iperikardiální) výpotek, obraz atelektázy, zánětlivá infiltrace plicní tkáně. Při hodnocení skiagramu je potřebné zhodnotit istav zobrazeného skeletu, především žeber. Necharakteristický skiagram (bez zjevné infiltrace) je vždy vhodné porovnat se starší dokumentací. Pokud je nádor menší velikosti než je rozlišovací schopnost rentgenového přístroje nebo při endobronchiálním růstu tumoru, nemusí být zobrazen.
Provedení skiagramu vbočné projekci umožňuje určit lokalizaci nádoru vjednotlivých segmentech příslušného plicního laloku, což je důležité před bronchoskopickým vyšetřením nebo před posouzením možnosti diagnostické transtorakální punkce, viz obr. 3.1, 3.2, 3.3, 3.4.
CT vyšetření plic amediastina
CT má vyšší rozlišovací schopnost než rentgenový snímek. CT vyšetření by mělo být provedeno nejen jako nativní, ale ispoužitím kontrastní látky. Je důležité pro stanovení přesného rozsahu tumoru, umožňuje zjistit případné prorůstání nádoru mimo plicní tkáň do struktur mediastina, pleury či do hrudní stěny. Je nezastupitelné pro zhodnocení velikosti hilových amediastinálních uzlin. Uzliny do velikosti 1cm se považují za nepatologické. Pomocí CT však nelze jednoznačně prokázat uzliny infiltrované nádorovými buňkami, protože ne každé zvětšení uzlin znamená nádorovou infiltraci. Uzliny mohou být zvětšené vdůsledku reaktivní hyperplazie, antrakózy či zánětu. Naopak uzliny postižené mikroskopickými metastázami nemusí být zvětšené.
Modifikací je spirální CT vyšetření, které umožňuje dosáhnout přesnější trojrozměrné zobrazení, viz obr. 3.5, 3.6, 3.7 a3.8.
Magnetická rezonance hrudníku (MR)
MR umožňuje přesnější rozlišení nádorové infiltrace od měkkých tkání. Poskytuje lepší informaci orozsahu tumoru, je-li kontraindikováno podání kontrastní látky při CT vyšetření. Toto vyšetření je vhodné kposouzení prorůstání tumoru do hrudní stěny nebo ke stanovení rozsahu nádoru lokalizovaného vplicním hrotě (Pancoastův tumor).
Pozitronová emisní tomografie
Tato nová metoda senzitivně zobrazuje plicní nádory.
3.5.3 Doplňková vyšetření pro stanovení rozsahu nemoci
Vyšetření břišní dutiny aretroperitonea
Sonografické vyšetření břicha je základním vyšetřením kdetekci metastáz vorgánech břišní dutiny, především jater aorgánů retroperitonea. Sonogra-
Obr. 3.1
Bronchogenní karcinom hlavního bronchu vpravo –sumační RTG snímek hrudníku, zadopřední projekce. Pravý hilus je zvětšený cípatě konturovanou tumorózní infiltrací, je lehká retrakce pravého hemitoraxu.


Obr. 3.2
Bronchogenní karcinom horního laloku vlevo – sumační snímek hrudníku. Ohraničené oválné zastínění tumorem plíce v levém horním laloku, v horním a částečně středním plicním poli.

Obr. 3.3
Bronchogenní karcinom horního laloku vlevo – levý bočný snímek hrudníku ukazuje uložení tumoru v apikodorzálním segmentu levé plíce (S1+2) horního laloku

Obr. 3.4 Tomografie plic – dnes již obsolentní vyšetřovací technika – bronchogenní karcinom horního laloku vpravo

Obr. 3.6 Bronchogenní karcinom dolního laloku vpravo sinfiltrací viscerální pleury ahilovou lymfadenopatií – CT vyšetření. Neohraničený tumor vdolním laloku sinfiltrací okolního parenchymu alehkou obstrukční bronchopneumonií. Pravý hilus je oproti druhé straně zvětšený vlivem lymfadenopatie bronchopulmonálních lymfatických uzlin.
3.5 Bronchoalveolární karcinom segmentu S 3 vlevo. CT vyšetření, řez v úrovni oblouku aorty. Uzlovité scirhoticky konturované ložisko v parenchymu plíce.

Obr. 3.7 Bronchogenní karcinom dolního laloku pravé plíce – CT vyšetření. Uzlovitý tumor v blízkosti větvení dolního bronchu pravé plíce.
fie též poskytuje informace oparenchymu ledvin adutém systému ledvin. CT dutiny břišní je vhodné vnejasných případech, neboť přece jen je rozlišení větší avýsledný obraz názornější. Kprůkazu metastatické infiltrace se vnejasných případech používá CT zobrazením vedené biopsie patologické oblasti.
Scintigrafie skeletu
Slouží ke stanovení kostních metastáz. Indikace záleží na typu bronchogenního karcinomu. Umalobuněčného karcinomu je součástí základního stagingu.
Obr.

Obr. 3.8 Tumor pravého hilu prorůstající do perikardu –CT vyšetření po aplikaci kontrastní látky intravenózně, mediastinální okno. Hypodenzní (tmavý) cípatě konturovaný areál odpovídá tumoru, prorůstajícímu do mediastina, do perikardu v úrovni obou srdečních síní. Trojúhelníkovitá část hypodenzity laterálně odpovídá obstrukční atelektáze vlivem komprese segmentárního bronchu. Tmavý proužek podél obratlového těla a žebra dorsálně prozrazuje infiltraci viscerální pleury a tekutinu v pohrudniční dutině
Unemalobuněčného se provádí jen upacientů spodezřením na metastázy.
CT mozku
Umalobuněčného karcinomu je součástí základního stagingu. Unemalobuněčného karcinomu je indikováno až tehdy, jsou-li přítomné klinické známky poškození mozku (závratě, nevolnost, zvracení, parézy ajiné neuropsychické příznaky).
Sternální punkce, trepanobiopsie
Indikace je zvažována upacientů slimitovanou formou malobuněčného bronchogenního karcinomu vpřípadě, že byla vyloučena diseminace vjiných orgánech. Kromě nemocných zařazených do klinických studií by vyšetření kostní dřeně mělo být prováděno jen vpřípadě zjištěných závažných poruch krevního obrazu.
Pro ilustraci problému uvádíme, že senzitivita průkazu diseminace vkostní dřeni může být zvýšena použitím monoklonálních protilátek proti nádo-
rovým antigenům. To je však dosud experimentální vyšetření, které by mohlo být přínosné pro indikaci vysokodávkované chemoterapie snáslednou transplantací kostní dřeně unemocných slimitovaným onemocněním. Novým přístupem, zatím experimentálním, je vyšet ř ování mikrometastáz vkostní dřeni svyužitím monoklonálních protilátek utěch nemocných, jimž byl radikálně resekován nemalobuněčný bronchogenní karcinom.
3.5.4 Vyšetření před plánovanou resekcí bronchogenního karcinomu
Je-li zvažována resekce bronchogenního karcinomu, je nutno vyloučit vzdálené metastázy na základě vyšetření uvedených výše aposoudit operabilitu dle rozsahu onemocnění vplicích. Pokud operace připadá vúvahu, tak se musí určit maximální možný rozsah resekce plicní tkáně na základě funkčního spirometrického vyšetření aanalýzy krevních plynů. Na základě zjištěných výsledků stanoví odborník, jak velký resekční zákrok je možno provést.
Uvedená vyšetření se vindikovaných případech doplňují ovyšetření difuzní kapacity, případně ventilačně perfuzní scintigrafií plic. Urizikových pacientů může být kposouzení operačního apooperačního rizika přínosné spiroergometrické vyšetření. Vyšetření srdce sonograficky nebo radioizotopovou ventrikulografií je indikováno unemocných skardiovaskulárním onemocněním.
3.5.5Bronchoskopie
Bronchoskopie umožňuje odebrání materiálu na histologické vyšetření speciálními klíštkami, nebo odebrání materiálu kcytologickému hodnocení pomocí speciálního kartáčku či bronchoalveolární laváže. Makroskopicky lze zhodnotit změny vbronchiálním stromu, monitorovat pr ů b ě h nemoci aprovádět paliativní terapeutické výkony.
Makroskopické změny vbronchiálním stromu mohou být přímé (intrabronchiální růst nádoru ve formě plošné infiltrace či exofytu) nebo nepřímé, podmíněné tlakem nádorové masy na stěnu (deformace azúžení bronchu, rozšíření bronchiální kariny). Bronchoskopické kontroly jsou důležitou součástí sledování nemocných léčených chirurgicky ikonzervativně. Unemocných po kurativní resekci se provádějí vpravidelných, zpočátku 3 až 6měsíčních intervalech, scílem časného záchytu případné
recidivy vpahýlu. Ukonzervativně léčených nemocných je důležitost bronchoskopického vyšetření při hodnocení úspěchu léčby asledování dalšího vývoje po léčbě rovnocenná vyšetření rentgenologickému.
Cílem terapeutických bronchoskopických zákroků je paliace příznaků vyvolaných endobronchiálními projevy nádoru usymptomatických nemocných, především dušnosti, atelektázy aretenčních zánětů. Endobronchiálně rostoucí patologickou tkáň můžeme snést mechanicky nebo pomocí laseru, ošetřit ji kryo- či elektrokauterem. Extrabronchiálně uložený tumor může dobře reagovat na endobronchiální radioterapii – brachyterapii, která může být idalším krokem prodlužujícím příznivý výsledek snesení endobronchiálního nádoru. Významná stenóza centrálních dýchacích cest je vhodnou indikací kzavedení endobronchiálního stentu.
3.5.6Další diagnostické metody
Torakoskopie
Torakoskopie zažila vposlední době velkou renesanci anyní je významnou metodou užívanou vdiagnostice iterapii patologických proces ů respiračního traktu – kromě odběru vzorků zparietální aviscerální pleury, které jsou navíc dobře přístupné vizuálnímu zhodnocení, umožňuje provést biopsii, případně resekci části plicního parenchymu avomezené míře jsou přístupny imediastinální struktury. Je tedy možné provést cílenou diagnostickou biopsii či kurativní resekci solitárního útvaru nebo (udiseminovaných procesů) biopsii části plicního parenchymu, případně cílený odběr zpleurálního nebo mediastinálního postižení.
Cílená transtorakální biopsie
Provádí se pod rentgenologickou kontrolou, svýhodou pod CT. Dříve šlo oodběry cytologické, rozvoj instrumentaria však nyní umožňuje získat histologicky hodnotitelný vzorek. Umožňuje diagnostikovat solitární intrapulmonální útvary či infiltráty.
Odběr sputa na cytologické vyšetření
Vzhledem knízké výtěžnosti nyní tato metoda pozbyla na významu, uplatnění snad může najít unemocných neschopných podstoupit náročnější diagnostické výkony. Vtom případě obvykle odebíráme několik (3 až 5) vzorků.
Bronchogenní karcinom
3.6Morfologie
Porucha regulace diferenciace pluripotentní kmenové buňky může vést krozvoji epiteliální dysplazie, metaplazie, hyperplazie nebo ke vzniku maligního epiteliálního nádoru. Bronchogenní karcinom je většinou heterogenní nádor obsahující maligní buňky vrůzném stupni diferenciace, nebo rozdílné histologické typy. Nádor se označuje jako kombinovaný karcinom tehdy, nachází-li se vnádorovém ložisku současně kombinace jednotlivých typů nemalobuněčného karcinomu, nebo elementy jak nemalobuněčného, tak malobuněčného karcinomu.
Morfologická klasifikace bronchogenního karcinomu byla vypracována vroce 1982 WHO. Tato klasifikace již byla revidována. Současná klasifikace používaná americkým National Cancer Institute (NCI) je uvedená vtabulce 3.1.
Spinocelulární karcinom
Tento typ představuje 30 až 40 %epiteliálních nádorů bronchiální sliznice. Jeho incidence vsoučasnosti nevzrůstá. Předstupněm jeho vzniku je dlaždicobuněčná metaplazie bronchiální sliznice. V časném stadiu karcinoma in situ nevykazuje invazivní růst přes bazální membránu epitelu. Často obsahuje maligní buňky vrůzném stupni diferenciace, což svědčí oheterogenitě nádoru. Spinocelulární karcinom je pomalu rostoucí nádor. Odhaduje se, že stadium invazivního růstu nastává až za 3–4 roky. Dle některých studií vykazuje menší potenciál vytvářet vzdálené metastázy amá příznivější prognózu než jiné typy nemalobuněčného karcinomu, je-li v časném klinickém stadiu provedena radikální resekce tumoru.
Adenokarcinom
Tvoří asi 40 %bronchiálních nádorů. Vposlední době vykazuje vzrůstající incidenci. Častěji bývá diagnostikován iunekuřáků aužen. Adenokarcinom je charakterizován přítomností glandulárních elementů nebo hlenu. Jedná se ovýrazně heterogenní nádor, takže určení jednotlivých typů adenokarcinomu může být obtížné.
Bronchoalveolární karcinom se svým biologickým chováním odlišuje od ostatních typů adenokarcinomu. Jeho charakteristickým rysem je růst podél stěn plicních alveolů. Zhlediska způsobu šíření se lze setkat se solitárním nádorem, multifokální přítomností plicního tumoru nebo srychle progredující difuzní pneumonickou formou, jež často postihuje
Tabulka 3.1 Histologické typy bronchogenního karcinomu
Nemalobuněčný karcinom Muži Ženy spinocelulární karcinom
• acinární
• papilární
• brochoalveolární
• solidní hlenotvorný velkobuněčný karcinom 7 % 8 %
• obrovskobuněčný karcinom
• karcinom zjasných buněk smíšené karcinomy 7 % 6 %
• adenoskvamózní karcinom
• mukoepidermoidní
• adenoidně cystický karcinom nediferencovaný karcinom
Malobuněčný karcinom 22 %20 %
WHO klasifikace
IASLC (International Association for the Study of Lung Cancer) klasifikace malobuněčného karcinomumalobuněčného karcinomu
Malobuněčný karcinom Malobuněčný karcinom bez nemalobuněčné komponenty intermediární karcinom malobuněčný svelkobuněčnou komponentou kombinovaný karcinom malobuněčný spodílem adeno nebo spinocelulárního karcinomu
obě plíce. Rozlišuje se hlenotvorná anehlenotvorná varianta bronchoalveolárního karcinomu. Nehlenotvorná varianta bývá obvykle spojována spříznivější prognózou. Velmi příznivá prognóza bývá usolitárního, nehlenotvorného bronchoalveolárního karcinomu, jehož průměr nepřesahuje 3cm.
Velkobuněčný karcinom
Vyskytuje se v10 až 15 %. Charakteristickým rysem tohoto nádorového typu je nepřítomnost diferenciace nádorových buněk ať už dlaždicového nebo glandulárního typu. Dle WHO klasifikace se rozlišují 2 histologické varianty (obrovskobuněčný karcinom akarcinom ze světlých buněk), které však nemají praktický klinický význam. Některé zvelkobuněčných karcinomů obsahují neurosekreční granula. Tento rys je společný iněkterým malobuněčným karcinomům. Prognóza velkobuněčného karcinomu se přibližuje adenokarcinomu.
Malobuněčný karcinom Vyskytuje se v15 až 20 %. Výrazným rizikovým faktorem je kouření avponěkud menší míře iradioaktivní záření. Ve vyšší míře se vyskytuje uosob, které byly ve styku sradonem, nebo uhorníků vuranových dolech. Jedná se oepiteliální nádor charakterizovaný přítomností kulatých nebo oválných malých buněk svýrazným jádrem ama-
lým množstvím cytoplazmy. Nádorové buňky často obsahují neurosekreční granula. Malobuněčný karcinom má již vpočátečních stadiích onemocnění výraznou tendenci vytvářet lymfogenní ihematogenní metastázy. Dle upravené klasifikace zroku 1999 se rozlišuje malobuněčný karcinom akombinovaný malobuněčný karcinom, obsahující elementy nemalobuněčného karcinomu (spinocelulární karcinom, adenokarcinom, velkobun ěč ný karcinom). Morfologické subtypy podle WHO klasifikace se neliší vprognóze, dle IASLC klasifikace má smíšená forma malobuněčné svelkobuněčnou komponentou ještě horší prognózu než čistě malobuněčný tumor.
Neuroendokrinní nádory plic
Pomocí imunohistochemických metod aelektronové mikroskopie byla definována skupina nádor ů produkující neurokrinní látky chromogranin, serotonin, synaptofysin. Neuron-specifická enoláza není považována za vhodný neuroendokrinní marker. Neuroendokrinní aktivita byla prokázána p ř edevším asi u75 %malobuněč ných karcinomů an ě kterých velkobuněč ných karcinomů . Schopnost tvorby neurokrinních látek vykazuje ikarcinoid. Výjime č n ě se neuroendokrinní aktivita prokazuje iuspinocelulárního karcinomu aadenokarcinomu.
3.7 Léčba malobuněčného bronchogenního karcinomu
Doporučení pro léčbu se odvíjí od klinických stadií. Základními postupy léčby malobuněčného karcinomu je:
• chemoterapie
• radioterapie cílená na tumor ametastázy
• preventivní ozáření mozku
• chirurgické zákroky.
Léčba by se měla principiálně lišit ve své intenzitě upacientů se vzdálenými metastázami, kde má jen vysloveně paliativní potenciál, od léčby pacientů slimitovaným onemocněním, kde může mít cíl kurativní, viz schéma 3.1.
3.7.1 Klinická stadia malobuněčného karcinomu
Pro malobuněčný bronchogenní karcinom se vklinické praxi používá zjednodušené klasifikace, ikdyž izde princip TNMklasifikace zůstává stejný. Malobuněčný karcinom je dělen do dvou skupin podle VALG (Veterans Administration Lung Cancer Study Group):
• Limitované stadium (Limited disease LD). Jde oonemocnění ohraničené na jedno plicní křídlo s/bez postižení ipsilaterálních nebo kontralaterálních uzlin mediastinálních nebo supraklavikulárních as/bez ipsilaterálního výpotku, které může být zavzato do jednoho ozařovacího pole.
• Extenzivní stadium (Extensive disease ED) – všechny ostatní formy onemocnění.
Mimo tuto klasifikaci existují ijiné, například Marburgská, která používá následující stadia: very limited disease (VLD), limited disease (LD), extensive disease I(ED-I extensive disease IIA, extensive disease IIB. Vpraxi se však používá častěji první, výše uvedená jednodušší klasifikace.
3.7.2 Chemoterapie
Základním léčebným postupem ulimitovaného iextenzivního stadia onemocnění malobuněčným karcinomem plic je chemoterapie (4 až 6 cyklů).
Vjejím důsledku dochází jak ke zlepšení kvality života, tak kprodloužení života nemocných. Chemoterapie první generace byla založena na základě poznání cytotoxického úč inku alkyla č ních látek, především cyklofosfamidu. Od počátku 80. let byly
postupně do léčby zařazovány další preparáty, jako etoposid, ifosfamid, epirubicin apředevším platinové deriváty, podávané vrůzných kombinacích.
Během první poloviny 90. let jsou testovány nové léky iumalobuněčných forem plicní rakoviny –paclitaxel, docetaxel, gemcitabin, vinorelbin a topotekan. Tyto léky nevedly kzásadnímu zlepšení výsledků alze tedy konstatovat návrat kalkylačním cytostatikům, ifosfamidu a cyklofosfamidu.
Standardní léčba první linie: platinové deriváty (cisplatina) +etoposid.
U ř ady nemocných je cisplatina nahrazována karboplatinou pro její lepší snášenlivost. Jako třetí lék do kombinované léčby první linie se doporučuje ifosfamid nebo paclitaxel. Zda do kombinované léčby zařadit dva nebo tři léky je zatím spíše věcí názoru, neboť dosud nejsou přesvědčivé výsledky oprodloužení doby přežití při užití trojkombinace.
Léčba druhé linie:
Uvíce než 95 %nemocných smalobuněčným karcinomem plic dochází krelapsu po iniciální léčbě. Chemoterapie druhé linie má význam především pro paliaci příznaků apro prodloužení délky přežití. Nemocní, unichž nedošlo kodpovědi na léčbu první linie chemoterapie, nebo nemocní, unichž došlo kprogresi do 3 měsíců od ukončení léčby první linie, mají jen malou šanci na úspěch léčby druhé linie.
Nemocným, unichž došlo kodpovědi na léčbu první linie chemoterapie akrelapsu onemocnění později než za 3 měsíce, je indikována druhá linie léčby ve stejné kombinaci jako první linie léčby. Unemocných skompletní remisí při léčbě první linie asintervalem nejméně 3 měsíců bez příznaků relapsu je indikována léčba druhé linie. Pro léčbu druhé linie je doporučován především paclitaxel a ifosfamid, dále pak topotekan, docetaxel, vinorelbin, gemcitabin anejnověji amrubicin.
Vysokodávkovaná chemoterapie spodporou periferních krevních buněk má význam především jako indukční léčba před plánovanou chirurgickou resekcí, vsoučasnosti je předmětem klinických studií.
Chemoterapie ustarších osob
Ta je často zpochybňována. Indikace kléčbě se ustarších osob se musí řídit především podle performance status spřihlédnutím kdalším chorobám.
Diagnostické a léčebné postupy u maligních chorob
Doba trvání chemoterapie
Léčebné protokoly doporučují 4–6 cyklů chemoterapie. Větší počet cyklů, stejně jako podávání takzvané udržovací cytostatické léčby, nemá vliv na prodloužení doby přežití.
3.7.3 Radioterapie
Radioterapie ulimitovaného stadia
Ulimitovaného stadia onemocnění je radioterapie vkombinaci schemoterapií dnes považována za standardní léčebný postup. Lze zvolit buď radioterapii po ukončení chemoterapie, nebo přistoupit ktakzvané konkomitantní (současné) radiochemoterapii nebo chemoradioterapii. Ozařuje se vdávce 45–50 Gy. Konkomitantní chemoradioterapie způsobuje více lokálních nežádoucích účinků, ale dle některých studií dosahuje lepších výsledků. Nejednotné výsledky dosavadních studií však neumožňují jednoznačné doporučení, proto načasování radioterapie achemoterapie závisí na názorech azkušenostech jednotlivých pracovišť.
Radioterapie jednoznačně zlepšuje lokální kontrolu tumoru adle metaanalýzy klinických studií vede kmalému, avšak statisticky významnému prodloužení přežití.
Radioterapie uextenzivního stadia
Uextenzivního stadia onemocnění má radioterapie význam pro paliaci příznaků.
Preventivní ozáření mozku
Preventivní ozáření mozku je vsoučasnosti indikované unemocných smalobuněčným karcinomem plic vlimitovaném stadiu onemocnění askompletní remisí jako adjuvantní léčba, neboť u20 až 40 %pacientů jsou mozkové metastázy prvním příznakem recidivy. Ozáření mozku trojnásobně snižuje riziko vzniku mozkových metastáz, rozdíl ve dvouletém přežití je +7 %ve prospěch ozářených. Ozáření nemá vliv ani na morfologické, ani funkční vlastnosti mozku. Doporučované dávky nejsou jednotné, většinou se doporučuje klasická frakcionace 30 Gy vl5 frakcích (jednotlivá ložisková dávka 2,0 Gy) nebo 24 Gy vosmi frakcích (jednotlivá ložisková dávka 3,0 Gy).
3.7.4 Chirurgie
Operace jako léčba první linie
Chirurgické odstranění malobuněčného karcinomu plic bývá prováděno poměrně vzácně vzhledem
kbiologické povaze tohoto nádoru. Primární chirurgický výkon při systémové chemoterapii je indikován vpřípadě velmi limitovaného stadia onemocnění. Upacientů spatologicky ověřeným stadiem nemociT1–2 N0–1 je dosahováno tříletého přežití u40 až 60 %pacientů. Pacienti vtomto stadiu však představují maximálně 5 %všech nemocných. Při infiltraci mediastinálních uzlin se snižuje tříleté přežití na pouhých 20 %, což se již neliší od pacientů léčených pouze chemoterapií aradioterapií. To bylo potvrzeno studií, vníž všichni pacienti slimitovaným onemocněním byli po iniciální chemoterapii randomizováni do skupiny léčené operací ado skupiny léčené dále jen radioterapií. Dvouleté přežití dosáhlo 20 %pacientů vobou skupinách, bez jakékoliv výhody pro operované nemocné.
Operační řešení má být tedy vyhrazeno jen pacientům se skutečně velmi limitovaným onemocněním.
Neoadjuvantní chemoterapie snásledující operací
Upacientů slimitovanou chorobou je možno operaci provést po předchozí chemoterapii, po dosažení kompletní nebo parciální remise. Tento postup je nejvhodnější pro pacienty slimitovaným stadiem, kteří mají postižené uzliny (N1 nebo N2). Pro definitivní zhodnocení tohoto postupu je však dosud málo dat.
Záchranný chirurgický výkon
Za záchranný chirurgický výkon je považována resekce nádoru snedostatečnou léčebnou odpovědí na předchozí chemoterapii aradioterapii upacientů vdobrém klinickém stadiu aslimitovaným onemocněním. Toto řešení připadá vúvahu jen umalého počtu pacientů. Vzhledem ktomu, že vjednotlivých případech tak bylo dosaženo dlouhého přežití, je nutné uvhodných pacientů zvážit itento postup.
Doporučení Evropské onkologické společnosti (ESMO) zroku 2001
Léčba limitovaného stadia
• Standardním režimem ipro pacienty speroperačně stanovenou diagnózou je chemoterapie založená na etoposidu a cisplatině nebo cyklofosfamidu a doxorubicinu vpočtu 4 až 6 cyklů. Udržovací léčba nevedla kdalšímu prodloužení přežití.
• Etoposid a cisplatina je režim považovaný za standardní chemoterapii pro limitované stadium. Mimo jiné proto, že může být kombinován sradioterapií bez toxických projevů.
• Radioterapie zlepšuje lokální kontrolu aprodlužuje přežití, aproto by měli být ozářeni všichni pa-
cienti slimitovanou chorobou ato buď po ukončení chemoterapie, nebo současně schemoterapií.
• Profylaktická radioterapie na CNS je indikována jen upacientů vkompletní remisi původně limitovaného stadia tumoru. Tato radioterapie sníží riziko pozdějších metastáz aprodlužuje délku přežití.
Léčba extenzivního stadia
• Ta samá chemoterapie vpočtu 4 až 6 cyklů prodlužuje přežití azmenšuje klinické příznaky nemoci.
• Upacientů srelapsem původně chemosenzitivní nemoci je možné zvážit podání chemoterapie druhé linie.
Schéma 3.1 Léčebné postupy u malobuněčného karcinomu
Limitované stadium
standardní postup
Bronchogenní karcinom
3.7.5 Prognóza pacientů smalobuněčným bronchogenním karcinomem
Prognóza nemocných závisí na stadiu onemocnění vdobě stanovení diagnózy. Léčebná odpověď na chemoterapii bývá dosahována u80–90 %léčených pacientů bez ohledu na původní rozsah nemoci. Je však jen dočasná, uvětšiny nemocných dojde ke vzniku recidivy.
Limitované stadium onemocnění
Bez léčby...........................medián přežití 3 měsíce. Chemoterapie..............medián přežití 12–14 měsíců.
Chemoterapie +radioterapie:medián přežití 14–16 měsíců.
Malobuněčný karcinom
možná alternativa uVLD
4–6 cyklů chemoterapie operace
ozáření primárního tumoru (45–50)Gy nebo současná chemoradioterapie
adjuvantní chemo 3–4 cykly
možná alternativa uLD aED-I
Extenzivní stadium
preventivní ozáření lebky uCR (30 Gy)
ozáření mediastina upostižení uzlin ozáření kalvy?
současná chemoradioterapie
standardní postup ED
5–6 cyklů chemoterapie
uCR preventivní ozáření lebky
experimentální léčba při symptomech ozáření tumoru nebo mediastinálních uzlin
Vysvětlivky: VLD – very limited disease, LD – limited disease, ED-I – extensive disease I, CR – celková remise
Diagnostické a léčebné postupy u maligních chorob
Extenzivní stadium onemocnění
Bez léčby.............................medián přežití 6 týdnů.
Chemoterapie:.................medián přežití 7,8 měsíců.
Přežití: 2 roky 5 %.
3.8 Léčba nemalobuněčného bronchogenního karcinomu
3.8.1 Klinická stadia nemalobuněčného karcinomu
Rozsah nádorového onemocnění se hodnotí dle mezinárodn ě platného systému TNMklasifikace azněho odvozených klinických stadií. Klasifikace
TNMpro bronchogenní karcinom je uvedená vtabulkách 3.2 a3.3. Používá se pro nemalobuněčný karcinom.
3.8.2 Léčba dle klinických stadií
KlinickéstadiumIaII (doporučeníNCCN2003)
Je-li vdobě stanovení diagnózy onemocnění klasifikováno jako klinické stadium IaII aneexistují kontraindikace zfunkčního nebo interního hlediska, je podle současných doporučení indikována chirurgická léčba. Adjuvantní nebo neoadjuvantní chemoterapie se musí stále hodnotit jako léčba experimentální (výzkumná). Význam pooperační radioterapie je také předmětem odborných debat avýzkumů.
Tabulka 3.2 TNMklasifikace bronchogenního karcinomu dle UICC aAJCC, revize zroku 1997
TPrimární nádor
TXPrimární tumor nelze hodnotit nebo byla prokázána přítomnost maligních buněk ve sputu či bronchiálním výplachu, ale nádor nebyl prokázán zobrazovacími vyšetřeními nebo bronchoskopicky.
T 0Primární tumor neprokázán.
TisKarcinom in situ.
T 1Tumor dosahující maximální velikosti 3 cm nebo méně vnejvětším rozměru. Tumor je obklopen plicní tkání či viscerální pleurou. Bronchoskopické šíření proximálním směrem nepřesahuje lobární bronchus (tzn. tumor se nešíří do hlavního bronchu).
T 2Tumor, který má jednu znásledujících charakteristik co se týká velikosti či rozsahu:
• dosahuje větší velikosti než 3 cm vnejvětším rozměru
• postihuje hlavní bronchus do vzdálenosti maximálně 2 cm nebo větší od kariny
• postihuje viscerální pleuru
• podmiňuje atelektázu nebo obstrukční bronchopneumonii šířící se do hilové oblasti, ale nepostihuje kompletně celou plíci.
T 3Nádor jakékoliv velikosti, jenž přímým invazivním růstem postihuje následujících struktury:
• hrudní stěnu, bránici, viscerální pleuru, perikard
• hlavní bronchus ve vzdálenosti bližší než 2 cm ke karině, ale nepostihuje karinu.
Nebo tumor podmiňuje atelektázu nebo obstrukční bronchopneumonii kompletně celé plíce.
T 4Tumor jakékoliv velikosti, který prorůstá do následujících struktur:
• srdce, velkých cév, průdušnice, jícnu, obratlových těl.
Nebo tumor vytváří oddělené (satelitní) nádorové uzly ve stejném laloku, nebo je přítomný maligní pleurální výpotek.
N Regionální mízní uzliny
NXPostižení regionálních uzlin nelze nestanovit.
N 0Bez přítomnosti metastáz vregionálních uzlinách.
N 1Metastázy vipsilaterálních peribronchiálních a/nebo ipsilaterálních hilových uzlinách aintrapulmonálních uzlinách včetně postižení přímým prorůstáním primárního tumoru.
N 2Metastázy ipsilaterálních mediastinálních a/nebo subkarinních lymfatických uzlin.
N 3Metastázy kontralaterálních mediastinálních a/nebo hilových uzlin. Metastázy ipsilaterálních nebo kontralaterálních skalenových nebo supraklavikulárních lymfatických uzlin.
MVzdálené metastázy
MX Vzdálené metastázy nelze prokázat.
M0Vzdálené metastázy nejsou přítomny.
M 1Vzdálené metastázy jsou přítomny.
Tabulka 3.3 Klinická stadia dle UICC aAJCC, revize zroku 1997
Okultní karcinom
Stadium
Stadium
Stadium
Stadium
Kurativní radioterapie jako jediná metoda léčby může dosáhnout až 40% pětileté přežití upacientů I.klinického stadia aproto ESMO tuto alternativu doporučuje pro pacienty stumorem I.aII. stadia, neschopných operace.
Alternativou ktomuto doporučení ESMO zroku 2001 pro neoperabilní pacienty, je chemoterapie snáslednou nebo souběžnou radioterapií. Po ukončení chemoterapie sradioterapií je vždy vhodné stav nemocného znovu zhodnotit, zda se nezlepšil natolik, že nemocný je již chirurgického výkonu schopen.
Klinické stadium III A
(doporučení NCCN 2003)
Upacientů vtomto stadiu je doporučováno operační řešení, pokud nejsou kontraindikace. Předoperační léčba chemoterapií je standardním postupem pro operabilní pacienty stumorem klinického stadia IIIA. Vrandomizovaných studiích byla prokázána lepší účinnost tohoto postupu před samotnou operací.
Vpřípadě neoperabilního stadia IIIA je vhodná radiochemoterapie, podobně jako pro nemocné stadia IIIB.
Klinické stadium III B
Unemocných ve stadiu III Bvdobě stanovení diagnózy je indikována chemoterapie založená na platinových cytostaticích, případně snáslednou nebo souběžnou radioterapií. Jen ve výjimečných případech se vtomto stadiu zvažuje operace po předchozí neoadjuvantní léčbě. Pacientům vklinickém stadiu III Bje však operace indikována jen zcela výjimečně.
Bronchogenní karcinom 55
Klinické stadium IV
Unemocných sgeneralizovaným nemalobuněčným bronchogenním karcinomem (klinické stadium IV) není názor na léčbu chemoterapií jednoznačný. Měla by být indikována jen unemocných vdobrém klinickém stavu. Vjejím průběhu bychom měli pečlivě sledovat, zda touto léčbou nemocnému opravdu prospíváme. Po dvou cyklech chemoterapie by měl být její efekt přehodnocen. Pokračování vléčbě do 4 až 6 cyklů je indikováno utěch nemocných, ukterých je po 2 cyklech prokazatelná odpověď na léčbu. Klinické studie neprokázaly, že by chemoterapie vtomto stadiu statisticky významně prodlužovala přežití. Vněkterých studiích dosahují skupiny pacientů léčené chemoterapií prodloužení života řádově otýdny, vjiných studiích nebyl prokázán signifikantní rozdíl mezi skupinami léčenými chemoterapií nebo jen symptomaticky. Ověřenou pravdou však zůstává, že chemoterapie uněkterých pacientů dočasně zmenšuje symptomy nemoci, atak zlepšuje kvalitu života. Vdoporučení ESMO 2001 se uvádí chemoterapie založená opět na platinových cytostatikách. Při neúspěchu chemoterapie první linie je chemoterapie druhé linie doporučována jenom pro vybrané pacienty, neboť pravděpodobnost úspěchu není velká. Vpřípadě solitárních metastáz je vhodné jejich chirurgické ostranění.
Schematicky jsou léčebné postupy uvedeny vtabulce 3.4.
3.8.3 Chemoterapie
Základem chemoterapeutických režimů jsou platinové deriváty cisplatina nebo karboplatina. Platinový derivát lze kombinovat sdalšími cytostatiky. Pro ne-
Tabulka 3.4 Taktika
léčby unemalobuněčného karcinomu
StadiumOperace
Radioterapie
Chemoterapie
I aII základní léčba:alternativa pro neoperované:alternativa pro neoperované operace kurativní ozáření chemoterapie jako monoterapie nebo současně (konkomitantně) sradioterapií
III Aano, ale až • neoadjuvatní léčba upřednostňuje se preoperativní po neoadjuvantní chemoterapie, případně adjuvantní chemoterapie ve spojení léčbě chemoterapie současně sradioterapií před podáním se zářením, nebo samotné chemoterapie následovaná zářením
• preoperativně uPancoastova tumoru,
• postoperativně uN2 stadia
III B výjimečně neoadjuvantně před případnou upřednostňuje se kombinace výjimečnou operací, sradioterapií před samostatnou nebo kurativně jako samostatná chemoterapií léčba, případně vkombinaci schemoterapií
IVnepaliativní radioterapie dle paliativní indikace chemoterapie symptomů nemoci
malobuněčný bronchogenní karcinom to jsou etoposid, vinblastin, mitomycin C, ifosfamid. V90. letech vstoupily do léčby nemalobuněčného bronchogenního karcinomu tzv. cytostatika III. generace. Jsou to především paclitaxel, gemcitabin, vinorelbin a docetaxel. Při použití kombinací stěmito cytostatiky je dosahováno především většího procenta objektivních odpovědí, což pro samotné nemocné znamená zlepšení kvality života. Autoři těchto studií deklarují istatisticky významné prodloužení přežití, avšak pokud se na tyto studie podíváme kriticky, zjistíme, že se jedná otýdny, zcela výjimečně oměsíce. Ovýsledcích těchto studií referujeme vknize Obecná onkologie apodpůrná léčba, Grada 2003, str. 761.
3.8.4
Radioterapie
Primární radioterapie skurativním záměrem Je indikována uinoperabilních nemocných bez průkazu vzdálených metastáz. Kurativním cílem vtomto případě myslíme zmenšení nádoru ajeho fibrotizaci, zpomalení růstu, nikoliv plné uzdravení, jak vyplývá ze slova kurativní.
Do ozařovacího pole je zahrnut primární nádor, plicní hilus na postižené straně, mediastinum apři uložení nádoru vhorním laloku inadklíčkové uzliny. Aby došlo ke zmenšení nádoru, je nutno aplikovat vyšší dávky záření. Proto se ozáření provádí vysokoenergetickými zdroji (lineární urychlovač, radiokobalt). Celková dávka záření je většinou 64 Gy.
Uněkterých nemocných lze zevní radioterapii (teleterapii) doplnit brachyterapií (zavedení zářiče intrabronchiálně).
Primární kurativní radioterapie dosahuje průměrného přežití 1,5 roku a5letého přežití u5–15 %pacientů
Pooperační radioterapie
Pooperační radioterapie je indikována při N2 aN3, stejně jako uinkompletní resekce tumoru. Ozařovaný objem zaujímá původní tumor amediastinální uzliny, dávka se pohybuje kolem 50–60 Gy/5–6 týdnů při standardním frakcionování 2 Gy/den. Výsledkem této léčby je snížení počtu lokálních recidiv o10 %aněkteré studie udávají ipozitivní vliv pooperační radioterapie na délku přežití.
Předoperační ozáření
Předoperační ozáření přichází vúvahu u Pancoastova tumoru, ozařovací pole zahrnuje tumor, horní část mediastina astejnostrannou nadklíčkovou oblast. Obvykle se používá dávky 40 Gy azbývajících 20 Gy se doplňuje po operaci.
Paliativní radioterapie
Paliativní radioterapie má za cíl mírnit komplikace způsobené tumorem. Při paliativním ozařování se aplikují dávka vrozmezí 30–50 Gy. Udává se následující účinnost paliativní radioterapie unásledujících symptomů: hemoptýza 84 %, bolesti 66 %,
uvolnění atalektázy 23 %, dušnost 60 %, paréza rekurentu 6 %, dráždění ke kašli 60 %.
3.8.5 Chirurgické plicní výkony
Pneumochirurgický výkon je obvykle souč ástí komplexní léčby nemocného sbronchogenním karcinomem. Operace může být prvním terapeutickým krokem, po němž bude následovat případná další léčba, nebo druhým terapeutickým krokem, kterému předchází neoadjuvantní léčba (léčba cytostatiky či zářením).
Přístupové cesty
Jako přístupová cesta knitrohrudním orgánům slouží vpneumochirurgii:
• torakotomie
• torakoskopie
• videoasistovaný torakoskopický přístup (VATS)
• mediastinoskopie
• sternotomie.
Torakotomie
je vsoučasné době nejčastější aobvykle istandardní přístupovou cestou kplicní tkáni. Strana torakotomie je logicky identická se stranou patologicky změněné plíce. Rozlišujeme torakotomii anterolaterální, posterolaterální aparasternální.
Torakoskopie
je výkonem, jehož historie se počítá již od prvého desetiletí dvacátého století. Opodobě, vjaké je tento výkon užíván nyní, bychom měli hovořit spíše jako ovideotorakoskopii. Jde ovýkon vpneumochirurgii dnes již nenahraditelný, avšak jeho užití je limitováno celou řadou faktorů.
Videoasistovaná torakoskopie (VATS)
je výkonem rozšiřujícím možnosti torakoskopie alze říci, že je kombinací mezi torakoskopií aklasickou torakotomií, což umožňuje rozšíření přístupových atím iterapeutických možností torakoskopie.
Mediastinoskopie byla až do nedávna výkonem užívaným prioritně voboru otorinolaryngologie kdiagnostice aodběru vzorku tkání kbiopsii vprostoru horního předního mediastina. Současný rozvoj techniky přinesl možnost videomediastinoskopie aoperační mediastinoskopie. Možnosti tohoto přístupu jsou však limitovány především prostorem mezihrudí.
Sternotomie
není výkonem užívaným pouze vkardiochirurgii nebo vchirurgii mediastina, avšak umožňuje opera č ní dostupnost ip ř i výkonech pneumochirurgických. Jde ooptimální přístup například kodstranění thymomu.
Základní typy pneumochirurgických výkonů
Pneumonektomie
Jde onejrozsáhlejší typ pneumochirurgického výkonu redukujícího plicní tkáň. Tato operace je indikována při postižení plíce vtakovém rozsahu, že výkon menšího rozsahu by již nebyl dostatečně extenzivní, tedy odstraňující patologické ložisko lokalizované vplicním parenchymu nebo vněkterém zbronchů.
Tento výkon indikujeme obvykle nemocným stzv. centrální formou patologického procesu.
Princip pneumonektomie spočívá (schematicky zjednodušeno) vtorakotomii, dále vizolaci všech struktur příslušných pro operovanou stranu plíce, cévních kmenů (a.pulmonalis avv. pulmonales) ahlavního bronchu (bronchus principalis). Při pravostranné pneumonektomii odstraňujeme tři plicní laloky (tedy asi 60 %zcelkového plicního parenchymu), levostranná pneumonektomie směřuje kodstranění dvou plicních laloků (cca 40 %).
Ošetření centrálních pahýlů hlavního bronchu acévních kmenů je velmi významnou součástí každého resekčního výkonu na plíci, kterým mj. předcházíme vážným, mnohdy až smrtícím komplikacím při poruše uzávěru cévního (závažné, rychlé amasivní krvácení) nebo bronchiálního (bronchopleurální píštěl apleurální empyém).Obě tyto komplikace patří knejzávažnějším anejobávanějším vpneumochirurgii.
Standardní součástí pneumonektomie je pooperační hrudní drenáž, která je pouze pasivní aslouží v časném pooperačním období především kodvodu sekretu, jenž se vpleurální kavitě tvoří apři insuficientní drenáži by vedl k řadě závažných pooperačních komplikací. Aktivní hrudní drenáže nepoužíváme především zobav před výraznou akutní dislokací mediastina ajeho orgánů směrem do operovaného hrudníku, což by přinášelo potíže zejména kardiálního původu. Vpozdějším pooperačním období nahrazujeme, vpřípadě potřeby, pleurální drenáž jednorázovými pleurálními punkcemi.
Pneumochirurgický výkon lze extenzivně (vindikovaných případech) rozšířit na:
• součásti mediastina – mediastinální pleuru, srdce (perikard, stěnu srdečních síní, cévní odstupy),
Diagnostické a léčebné postupy u maligních chorob
velké cévní kmeny, jícen, tracheu; lymfadenektomii, spolu sodstraněním související tukové tkáně mediastina, považujeme vsoučasné době již za standard každého pneumochirurgického onkologického výkonu kurativní povahy
• hrudní stěnu – parietální pleuru, měkké tkáně hrudní stěny, skelet hrudní stěny apod.
Za standardní součást každého pneumochirurgického kurativního výkonu uskutečněného zdůvodu bronchogenního karcinomu považujeme vsoučasné době tzv. extenzivní mediastinální lymfadenektomii. Jde opečlivé, systematické acílené odstranění skupin lymfatických uzlin od oblasti horní hrudní apertury až po bránici.
Názory na extenzivní lymfadenektomii se různí.
Někteří autoři ji považují za pouhý dokonalejší staging patologického pneumoonkologického procesu, který sám osobě nemá valného významu pro délku přežití nemocného, avšak může být exaktní indikací kzavedení adjuvantní terapie. Druhým extrémním názorem je úvaha druhé skupiny pneumochirurgů, kteří mediastinální lymfadenektomii naopak považují za vlivný faktor pro délku pooperační remise choroby. Skutečnost bude pravděpodobně někde uprostřed. Exaktně vykonanou mediastinální lymfadektomií unemocného sbronchogenním karcinomem dosáhneme: dokonalejšího stagingu; častější aplikace oprávněné adjuvantní terapie; redukce nádorové masy.
Principiálně však uonkologické choroby, překročivší hranici orgánu (zněhož vychází), nelze očekávat výrazné zlepšení pouze chirurgickým výkonem lokoregionální povahy.
Pneumonektomie je výkonem, který oproti jiným pneumochirurgickým výkonům přináší i řadu pozdních potíží až komplikací. Častěji než po ostatních pneumochirurgických výkonech, při nichž ponecháváme vpohrudniční dutině větší či menší část funkčního azdravého plicního parenchymu, pozorujeme tvorbu pleurálního výpotku (častější pleurální punkce, vyšší riziko pleurálního empyému atím i častější frekvenci bronchopleurální píštěle), zmenšení objemu hrudníku na pneumonektomované straně, výraznější zátěž kardiální apod. Proto musí být tento výkon vždy adekvátně indikován. Při méně rozsáhlém patologickém postižení plíce vždy indikujeme, je-li to možné, výkon menšího, leč stále kurativního rozsahu.
Plicní bilobektomie
Je pneumochirurgickým výkonem, při němž výše popsaným způsobem odstraňujeme dva plicní la-
loky. Otomto výkonu hovoříme zejména při pravostranné plicní resekci, kdy vpohrudniční dutině ponecháváme jeden plicní lalok. Termín bilobektomie však obvykle nepoužíváme p ř i levostranném plicním resekčním výkonu, kdy je vhodnější pojem pneumonektomie, zejména zpohledu na pooperační období (viz riziko výše zmíněných komplikací).
Operační přístup apostup je shodný jako uvýkonů typu pneumonektomie. Pooperační hrudní drenáž je však po bilobektomii obvykle aktivní, protože významně přispívá krozvinutí reziduálního plicního parenchymu na operované straně, což se významně podílí (spolu smírnou dislokací mediastina akompenzatorní hyperinflací plicní tkáně jak na straně operované, tak na straně neoperované) na vyplnění volného pleurálního prostoru adostatečné dýchací ploše. Při bilobektomii dochází kredukci celkového objemu plicního parenchymu cca o40–45 %.
Plicní lobektomie
Je nejčastějším resekčním výkonem vonkologické pneumochirurgii. Resekujeme tedy pouze jeden plicní lalok zpřístupu azpůsobem, který se blíží výše popsané pneumonektomii či bilobektomii. Redukce plicního parenchymu je různá, podle objemu konkrétního plicního laloku. Při výkonech kurativní povahy vždy dbáme odostatečný rozsah plicní resekce tak, abychom nádorové reziduum neponechali vbronchiálním pahýlu centrálně či vplicním parenchymu, proto standardn ě uvšech plicních resekcí vyšetřujeme, samostatnou část tkáně khistologickému vyšetření, bronchiální prstenec centrálně od linie bronchotomie.
Operační výkon lobektomie kurativní povahy je na plicním laloku opět standardně doplněn olymfadenektomii avždy ukončen aktivní hrudní drenáží.
Plicní segmentektomie Je nejmenším výkonem tzv. anatomické plicní resekce, což znamená, že jde otakový výkon, kterým kopírujeme hranice anatomické jednotky, vtomto případě plicního segmentu. Zonkologické indikace je vsoučasné době užíván ojediněle, ato spíše upacientů kde by výkonem většího rozsahu byl plicní parenchym redukován oobjem, který by zfunkčního hlediska byl pro pacienta již nepřiměřeně velkou zátěží. Kurativní plicní resekce vrozsahu segmentektomie je na některých zahraničních pneumochirurgických pracovištích považována, spolu sex-
tenzivní lymfadenektomií, za výkon kurativně dostačující, ato zejména uonemocnění bronchogenním karcinomem vI.stadiu.
Vpooperačním období je péče onemocného realizována již standardním postupem jako uplicních resekcí.
Atypická plicní resekce
Nepatří do standardního sortimentu kurativních pneumochirurgických výkonů. Tento postup, při kterém operatér nerespektuje anatomickou hranici některé zplicních jednotek (plíce, plicní lalok, plicní segment), bývá vyhrazen pro tzv. paliativní resekce, nebo je užit jako kurativní resekce upacientů staršího věku asmenší plicní patologickou malignitou, nebo při paliativních resekcích.
3.8.6 Paliativní léčba bronchogenního karcinomu
Paliativní lé č ba nemocných sbronchogenním karcinomem se řídí stejnými zásadami jako ujiných nádorových onemocnění. Unemocných srakovinou plic indikujeme paliativní léčbu především kvůli potížím, které jsou spojeny se syndromem horní duté žíly, smaligním pleurálním výpotkem abronchiální obstrukcí.
Syndrom horní duté žíly
Umalobuněčného bronchogenního karcinomu je indikována systémová chemoterapie, unemalobuněčného bronchogenního karcinomu především radioterapie. Ještě před zahájením výše uvedené léčby lze zmírnit potíže nemocného antiedematózní léčbou, která spočívá vpodávání vysokých dávek dexametazonu (24–40mg/den) avpodávání diuretik.
Maligní pleurální výpotek
Jeho řešení je podrobně rozebráno vknize Obecná onkologie apodpůrná léčba, Grada, 2003, str. 663.
Obstrukce dýchacích cest
Vpřípadě obstrukce velkých dýchacích cest můžeme kvalitu života zlepšit rekanalizací pomocí laseru aelektrokauteru. Krekanalizaci lze použít také brachyterapii – zavedení zářiče přímo do bronchiálního stromu. Popisuje se ipoužití kryoterapie, nelze ji však zavádět flexibilním bronchoskopem. Další možností řešení extramurálních stenóz je zavedení stentu.
Všechny výše uvedené metody patří mezi intervenční bronchologické výkony, pro jejichž provedení je třeba zkušeného bronchologa ataké odpovídajícího technického vybavení.
3.8.7 Sledování nemocných
Sledování nemocných sbronchogenním karcinomem patří do rukou pneumologa sonkologickou specializací. Po ukončené léčbě má za cíl časně odhalit progresi azahájit další léčbu.
Pokud nemocný po ukončené onkologické léčbě nemá potíže, je vhodné provádět přešetření (restaging) po 3 měsících. Udává-li nemocný nové potíže, je vhodné provést přešetření ihned. Pravidelné sledování má význam ipro ty nemocné, unichž po stanovení diagnózy nebyla zvolena léčba skurativním záměrem. Díky pravidelným kontrolám můžeme včas zachytit nový příznak adobře zvolenou léčbou paliativní pak můžeme zlepšit kvalitu života nemocného.
3.8.8 Prognóza pacientů snemalobuněčným bronchogenním karcinomem
Nejlepší prognózu mají ti nemocní, unichž byl nádor diagnostikován voperabilním stadiu aprovedena úsp ě šná resekce plicního tumoru. Podíl radikálně operovaných nemocných ze skupiny všech pacient ů snemalobun ěč ným bronchogenním karcinomem je pomě rn ě nízký avjednotlivých regionech Č R m ů že být odlišný. V celé ČR nepřesahuje 20 %. Dle zahraničních údajů podíl operovaných činí 25–30 %.U radikálně operovaných pacientů je prognóza závislá na TNM klasifikaci. Nejlepší prognózy dosahují nemocní, jejichž nádor byl klasifikován jakoT1 N0, unichž bývá zaznamenáno 5leté př ežití v ě tší jak 60 %. Naopak pom ě rn ě nep ř íznivou prognózu má skupina nemocných klasifikovaných jako TX N2. Ivpř ípad ě , že je provedena radikální resekce nádoru apostižených uzlin, uvě tšiny nemocných dochází krecidiv ě (lokální nebo vzdálené) do 2 let. Utéto skupiny nemocných se č asto podává adjuvantní (zajiš ť ovací) léč ba, jež sestává bu ď zradioterapie, chemoterapie č i kombinace chemoterapie aradioterapie.
Prognóza upacient ů sneoperabilním lokoregionáln ě pokro č ilým onemocn ě ním č i generalizovaným onemocn ě ním je ip ř es aplikovanou
60 Diagnostické a léčebné postupy u maligních chorob
lé č bu špatná. Medián p ř ežití t ě chto nemocných obvykle nep ř esahuje 18–24 m ě síc ů , jedná-li se omístn ě pokro č ilý nádor, a12–18 m ě síc ů , byl-li vdob ě stanovení diagnózy plicní nádor již diseminovaný.
3.9 Perspektivy
Zařazení dvou cytostatik III. generace do léčby NSCLC nepřineslo očekávané prodloužení přežití. Je velmi pravděpodobné, že vsoučasnosti jsou možnosti konvenční chemoterapie vyčerpány anepředpokládá se, že by další konvenční cytostatika mohla nemocným sNSCLC zásadně prodloužit život. Proto je intenzivně studována léčba biologická, viz též léčba cílená (targeted) nebo intracelulární chemoterapie. Na rozdíl od konvenční cytostatické léčby se jedná opřístup na subcelulární úrovni (proto intracelulární nebo molekulární chemoterapie). Vsoučasnosti je nejvíce informací oovlivnění receptoru pro epidermální růstový faktorEGFR(Epidermal Growth Factor Receptor). Velmi intenzivně je zkoumána možnost inhibice intracelulární domény EGF receptoru styrozinkinázovou aktivitou. Jedná se oléčbu perorální, což je velmi výhodné unemocných často značně předléčených spoškozeným ašpatným stavem periferního žilního přístupu. Podle ukončených studií se tato léčba prokázala pro tuto skupinu nemocných jako velmi slibná, také díky velmi dobré snášenlivosti preparátů. Předpokládá se také její využití vléčbě adjuvantní.
Studovaných pochodů astruktur uvnitř buňky je celá řada. Předpokládá se, že vprůběhu dalších let se vléčbě NSCLC objeví idalší preparáty cílené na nitrobuněčné pochody.
Ke správnému rozhodnutí otom, komu podat in-
hibitor tyrozinkinázové aktivity EGFR (gefitinib, erlotinib) nebo preparát scíleným účinkem na další nitrobuněčné procesy nestačí vyšetřovací metody, které jsou standardně používány před podáním konvenční chemoterapie. Problémovou otázkou zůstává fakt, zda je vhodné monitorovat efekt biologické léčby standardními zobrazovacími metodami zahrnujícími skiagram hrudníku, CT hrudníku aepigastria aultrazvukové vyšetření dutiny břišní kdetekci metastáz ahodnotit nadále celkovou odpověď (response rate) jako parciální akompletní remisi onemocnění. Výše uvedená vyšetření totiž nedokáží rozpoznat aktivitu nádorových buněk ajejich maligní vlastnosti zahrnující schopnost proliferace, angiogeneze ametastazování, které se právě cílenou biologickou léčbou snažíme blokovat. Proto je zapotřebí zaměřit výzkum především na sledování markerů proliferační aktivity vprůběhu tohoto onemocnění. Vsoučasnosti jsou studovány jsou nejčastěji studovány Ki-67, proliferačně –apoptotický index, transmembránové proteiny HER1/neu aHER2/neu, tkáňový polypeptidový antigen, neuronspecifická enoláza atymidinkináza. Předpokládá se, že vdalších letech bude výzkum voblasti bronchogenního karcinomu zaměřen především na výběr té skupiny nemocných, která by měla zbiologické léčby největší zisk.
Srozvojem intervenční radiologie jsou velmi intenzivně studovány imožnosti radiofrekvenční termoablace. Ta je zatím prováděna unemocných speriferně uloženým NSCLC anebo speriferně uloženými solitárními metastázami, ukterých je zfunkčního hlediska nebo zjiného důvodu kontraindikována chirurgická resekce. Zda se jedná ometoda, která je schopná nahradit chirurgický výkon mohou ukázat randomizované studie.
Literatura
BORAL,AL., LYNCH,T. (JR): Chemotherapy of Small Cell Lung Cancer, 381–403. In: Skarin A.T. (ed): Multimodality Treatment of Lung Cancer. Marcel Dekker, Inc., New York *Basel 2000.
British Thoracic Society and Society of Cardiothoracic Surgeons of Great Britain and Ireland Working Party: Guidelines on the selection of patients with lung cancer for surgery. Thorax 56, 2001, 89–108.
BUNN,PA., KELLY,K.: New Combination in the Treatment of Lung Cancer. ATime for Optimism. Chest 117, 2000, 138–143.
BUNN,PA., MAULT,J., KELLY,K.: Adjuvant and Neoadjuvant Chemotherapy for Non-Small Cell Lung Cancer. Chest 117, 2000, 119–122.
DESLAURIERS,J., GRÉGOIRE,J.: Clinical and Surgical Staging of Non-Small Cell Lung Cancer. Chest 117, 2000, 96–103.
ESMO minimum clinical recomendation for diagnosis, treatment and follow up of non-small-cell lung cancer. Ann. Oncol., 12, 2001, s.1049–1050 a1051–1052.
HOLLI,K., VISAKORPI,T., HAKAMA,M.: Smoking and Survival drom Lung Cancer. Acta Oncologica 38, 1999, 8, 989–992.
KELLY,K.: New Chemotherapy Agents for Small Cell Lung Cancer. Chest 117, 2000, 156–162.
KOLEK, V., GRYGÁRKOVÁ, I., HAJDÚCHETAL.:Neoadjuvantní chemoterapie uhraničně operabilních stádií IIIA nemalobuněčného karcinomu plic kombinací vinorelbin akarboplatina. Následnácílená pooperační adjuvantní chemoterapie. Klinická onkologie, 14, 2001, 2, s.55–58.
LUKETICH,JD.: Radiofrequency ablation. Lung Cancer 41, suppl. 3, 2003, S63.
MARTINS,SJ., PEREIRA,JR.: Clinical Factors and Prognosis in Non-Small Cell Lung Cancer. Am. J. Clin. Ocol. 22, 1999, 453–457.
MONNERAT,C., LECHEVALIER,T.: Chemotherapy for non-small-cell lung carcinoma, alook at the past decade. Annals of Oncology 11, 2000, 773–776.
NYGREN, P., LARSSON,R.: Overview of the clinical efficacy of investigational anticancer druha. J. Int. Med. 253, 2003, 46–75.
PEŠEK,M. ETAL.: Bronchogenní karcinom. Galén, Praha, 2002, 235 s.
SKŘIČKOVÁ, J., PÁLKOVÁ, I., ŠPELDAETAL.: Některé aspekty pokroku vchemoterapii bronchogenního karcinomu. Vnitřní lékařství, 47, 2001, 8, s.561–564.
ZATLOUKAL, P., PETRUŽELKA,L.: Karcinom plic. Grada, Praha, 2001, 367 s.


4Maligní mezoteliom
4.1 Definice
Maligní mezoteliom je nádor, který vzniká zmezodermu výstelky tělních dutin, aproto může nabývat jednak epiteliální, jednak mezenchymální podoby, avšak může představovat isměs či přechodné formy mezi oběma tkáněmi. Nejčastěji vychází zpleury. Kromě pleury mezoteliom vzniká vmezenchymální tkáni jiných orgánů: perikard, peritoneum, tunica vaginalis testis, ovarium. Asi 80 %maligních mezoteliomů má pleurální původ.
4.2 Epidemiologie aetiologické faktory
Statistické informace ovýskytu tumoru
Maligní mezoteliom představuje 0,16 %všech maligních tumorů. Jeho incidence vEvropských zemích se pohybuje kolem 1,2–1,4/100 000 obyvatel. U75 %pacientů postihuje primárně pleurální dutinu, primární vznik vperitoneální, perikardiální atunica vaginalis testis činí dohromady 25 %.
Zregistru zhoubných novotvarů ČR lze pouze získat sumární informace odg. C38 zhoubný novotvar srdce, mediastina apleury. Vroce 1989 bylo nahlášeno 61 nových onemocnění umužů a27 užen, vroce 1998 – 65 umužů (1,3/100 000) a33 užen (0,6/100 000). K31. 12. 1998 bylo dispenzarizováno 165 nemocných.
Etiologické faktory
Nejdůležitějším rizikovým faktorem pro vznik mezoteliomu je expozice azbestem. Kontakt sazbestem je dokumentován u50–70 %všech nemocných smaligním mezoteliomem. Nejohroženější jsou osoby vpřímém, především profesionálním kontaktu. Zde se celoživotní riziko vzniku nádoru odhaduje na 20 %. Kohroženým osobám však patří ilidé, unichž je dlouhodobě nepřímý kontakt sazbestem iulidí pobývajících vbudovách, vnichž byl použit azbest kizolaci
příček mezi pokoji, obzvláště, pokud se tyto azbestové povrchy dále mechanicky narušují. Spodivem je, že v ČR existují dokonce velké nemocnice, kde byl azbest použit pro vytvoření nehořlavých příček. Mezoteliomem bývají postiženi irodinní příslušníci osob zpracovávajících azbest. Zde je však riziko vzniku mezoteliomu výrazně menší. Doba latence mezi expozicí azbestu arozvojem maligního mezoteliomu dosahuje 20–40 let. Jeho vznik je vliteratuře popisován ive spojitosti spředchozím terapeutickým ozářením hrudníku. Kouření, na rozdíl od bronchogenního karcinomu, nezvyšuje riziko vzniku maligního mezoteliomu.
4.3 Příznaky nemoci
Nejčastějšími místními příznaky bývá bolest hrudníku, dráždivý kašel, dušnost. Asi u3/4 pacientů dochází ke vzniku maligního výpotku na postižené straně hrudníku. Zřídka (asi v5 %) může být mezoteliom přítomný oboustranně. Někdy může dojít ike vzniku pneumotoraxu. Mezoteliom se může rozšířit nebo vznikout primárně vdutině břišní avtakovém případě se kplicním příznakům přidávají příznaky ascitu. Mezoteliom má výraznou tendenci klokálnímu invazivnímu růstu. Častá je tvorba implantačních metastáz vznikajících následkem invazivních výkonů (punkce nebo drenáž pleurální dutiny, torakoskopie). Mezoteliom svým invazivním růstem často poškozuje okolní orgány: páteř, jícen, horní dutou žílu způsobující syndrom horní duté žíly. Při invazi cervikálních nervů zhrudního sympatiku ainfiltraci plexus brachialis vzniká Claude Bernard Hornerův syndrom. Dochází ikprorůstání tumoru do hrudní stěny nebo bránice smožným prorůstáním do břišní dutiny. Jen ojediněle se vdobě diagnózy maligního mezoteliomu nevyskytují potíže. Pleurální výpotek vtakovém případě bývá často zjištěn jako náhodný nález při rtg vyšetření. Vdůsledku nádoru se mohou vyskytovat icelkové příznaky: horečky, pokles hmotnosti, anemie, kachektizace.
4.4 Stanovení diagnózy
Pacienti přicházejí klékaři spříznaky maligního procesu postihujícího pleuru, proto základním zobrazovacím vyšetřením je skiagram hrudníku. Běžným snímkem hrudníku lze dokumentovat tekutinu vpohrudniční dutině, avšak nemusí vždy být zobrazen nádor vyrůstající zpleury. Proto, nemá-li pacient již dříve stanovenu diagnózu jiného maligního onemocnění, které by mohlo vytvořit maligní výpotek, je nutno vždy mít podezření na mezoteliom aprovést zobrazení pomocí CT či MR, které velmi dobře zobrazí procesy vyrůstající zpleury. Tato vyšetření zároveň stanoví lokální rozsah nemoci apostižení regionálních uzlin. CT či MR zobrazení jsou základem pro další chirurgický postup (torakoskopii nebo torakotomii), jehož cílem je stanovení histologické diagnózy, aumožňují také stanovení klinického stadia. Cytologické vyšetření materiálu získaného pleurální punkcí není většinou dostačující.
Úloha histologa je pak imunohistochemicky potvrdit mezoteliom aodlišit jej od metastáz jiných nádorů, jak je uvedeno vodstavci omorfologii.
Pokud se zvažuje operační řešení, pak součástí vyšetření rozsahu nemoci by mělo být ibronchoskopické vyšetření, protože maligní mezoteliom vzácně způsobuje endobronchiální postižení, arovněž vyloučení vzdálených metastáz, byť vdobě stanovení diagnózy je hematogenní diseminace velmi vzácná. Kmetastazování dochází až vprůběhu onemocnění. Přítomnost orgánových metastáz bývá pitevně konstatována asi upoloviny pacientů. Základní laboratorní vyšetření jsou obvykle normální. Někdy dochází ktrombocytóze nebo khyperkoagulaci (trombotická diatéza), které můžou způsobit žilní trombózy aplicní embolizace či výjimečně syndrom diseminované koagulopatie (DIK). Zatím není znám nádorový marker specifický pro mezoteliom. Zvýšení koncentrace CEA (vséru nebo vpleurálním výpotku) svědčí pro adenokarcinom a činí diagnózu mezoteliomu nepravděpodobnou.
4.4.1 Morfologie
Existují tři histologické varianty maligního mezoteliomu:
• epiteliální, nebo tubolo-epiteliální;
• sarkomatózní (mezenchymálmí, nebo fibrosarkomatózní);
• smíšený neboli bifazický typ obsahující sarkomatózní aepiteliální elementy současně.
Smíšený typ se vyskytuje nejčastěji. Poměrně obtížné může být rozlišení epiteliální formy maligního mezoteliomu od buněk adenokarcinomu.
Diferenciálně diagnostickým problémem při histologickém hodnocení jsou metastázy adenokarcinomů zplic, prsou, vaječníku, žaludku, ledviny či prostaty. Při odlišení těchto metastáz pomohou vyšetření ultrastrukturální, karyotypická aimunohistochemická, znichž připomínáme průkaz receptoru kyseliny hyaluronové (CD44) aprůkaz kyseliny hyaluronové vbuňkách, ale ivpleurální tekutině, adále PAS aCEA negativita apozitivní reakce svimentimem. Přesná histopatologická diagnóza je základem pro přiznání choroby zpovolání.
4.4.2 Klinická stadia (staging)
Bylo vypracováno několik stagingových systémů mimo klasickou TNM klasifikaci.V tabulce 4.1 uvádíme jednu znich avtabulce 4.2 a4.3 pak uvádíme klasickou TNM klasifikaci.
Maligní mezoteliom se však pouze výjimečně diagnostikuje ve stadiu, kdy je možná radikální resekce tumoru.
4.5 Léčba
Neuspokojivé výsledky léčby vedly ke vzniku protokolů kombinujících jednotlivé léčebné modality. Základem je alespoň částečné chirurgické odstranění (debulking) primárního nádoru. Operace pak bý-
Tabulka 4.1 Systém klasifikace dle International Mesothelioma Interest Group (zohledňuje možnosti radikální exstirpace tumoru)
Stadium ITumor je ohraničen kapsulou, jejíž hranice tvoří parietální pleura, ipsilaterální pleura, plíce, perikard abránice.
Stadium IITumor vrozsahu stadia Ispozitivními nitrohrudními (N1–2) uzlinami.
Stadium IIILokální šíření tumoru do následujících struktur: hrudní stěna nebo mediastinum, srdce nebo peritoneum skrz bránici spostižením nebo bez postižení mimohrudních nebo hrudních kontralaterálních (N3) uzlin.
Stadium IVPřítomnost vzdálených metastáz.